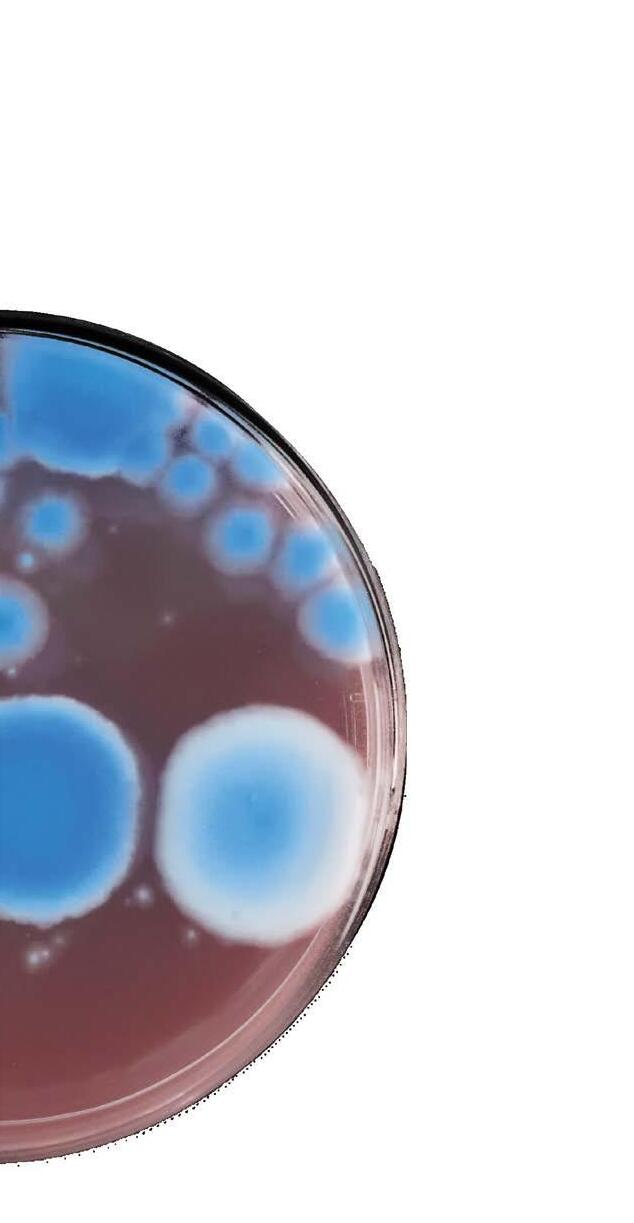

Maurice
takes a compassionate approach to patient care and combating prejudice in the workplace



![]()

Maurice
takes a compassionate approach to patient care and combating prejudice in the workplace



10
A vigorous focus on diversity and inclusion is a major component of the rapidly changing healthcare landscape. These four executives showcase how emphasizing different points of view enhances patient care and bolsters organizational success in the industry.
Community-based care is roaring back to popularity, and Joseph Maher is on the forefront of this healthcare transformation at Steward Health Care System
Talented doctors, nurses, and caregivers can do wonders. Give them state-of-the-art technology, and the possibilities for care seem endless.

Surgeons aren’t often thought of as business partners, but Advocate Christ Medical Center ’s director of business operations Matthew Balog wants to change that

Ruchika Kumar ’s ethical principles are a perfect match for her work at Genentech, helping bring life-altering treatments to market for patients
36
L.A. Care Health Plan’s Robert Turner spearheads initiatives to enhance the lives of everyone who steps through the institution’s doors
97
Galderma’s Quintin Cassady fights every day to showcase the importance of drugs that treat skin conditions such as rosacea and psoriasis
104
Not many people in the healthcare industry can say they’ve worked with an NBA player, but Gordon Richman is no ordinary executive
Making a Difference in the World The Cutting Edge of Care
178
Daniela Crivianu-Gaita followed her passion for healthcare from Romania to Dynacare , where she develops lifechanging digital technologies
200
Jeremy Livianu speaks six languages: French, Romanian, Spanish, English, science, and law. The last two are of particular importance in his role at Nevro.

Sherri Zink revamped Blue Cross Blue Shield of Tennessee‘s data infrastructure to give business leaders unprecedented access to critical information

James Harrington never goes to trial without data. The result: a near-perfect success rate while defending Shire’s patent portfolio.
232
JFK Health’s Neal Ganguly understands firsthand how company growth presents new challenges for a medical center
236
Joe Machicote is cultivating a talent pipeline at Erickson Living by building an inclusive work environment
CREATIVE
VP of Creative
Kathy Kantorski
Editorial Director
Cyndi Fecher
Strategic Content Director
Megan Bungeroth
Senior Editor
Adam Kivel
Editors
Joe Dixon
Beth Hyland
Jonas Weir
Design Director
Joshua Hauth
Designer
Lauren Keeling
Photo Director
Caleb Fox
Photo Editors & Staff
Photographers
Kristin Deitrich
Gillian Fry
Contributors
David Baez
Galen Beebe
Kasey Cheydleur
Randall Colburn
Jenny Draper
Lori Fredrickson
Russ Gager
Chris Gigley
Chuck Green
Elise Gruneisen
Joseph Kay
Russ Klettke
Mary Kenney
David Levine
Porcshe Moran
Bridgett Novak
Jeff Silver
Pamela Sornson
SALES & ACCOUNT
MANAGEMENT
EVP of Sales
Katie Else
VP of Sales
Kyle Evangelista
Director of Sales Operations
Philip Taylor
Sales Director
Kemp Pile
Content and Advertising Managers
Megan Apfelbach
Lauren Cavers
Abbey Cunningham
Mike Gortowski
Max Krevitz
Erin Malone
Lexi Widger
Director, Executive Success
Anna Jensen
Executive Relationship Managers
Josh Rosen
Jenny Vetokhin
PUBLISHING
Guerrero Howe, LLC
By the time I was eighteen years old, I had had as many surgeries. I was born with spina bifida, a congenital birth defect that affects how the spine is formed in utero. As a result, I wear leg braces and use a wheelchair to get around most of the time. This condition affects everyone differently, but for me it meant undergoing various surgeries on my head, spine, legs, and hips while growing up to ensure I maintained optimum health.

In addition to a supportive network of friends and family that get me through some of the more difficult times, I was fortunate enough to have wonderful doctors, nurses, and physical therapists who didn’t make me feel like just another patient; they made me feel like a person.
CEO Pedro Guerrero
Executive Assistant
Jaclyn Tumberger
Managing Director of Marketing
Sean Conner
VP of Business Operations
Marc Jerbi
Recruitment Director
Elyse Schultz
Circulation & Reprints
Director
Stacy Kraft
Events Director
Vianni Busquets
Client Services Director
Cheyenne Eiswald
Senior Client Services Manager
Rebekah Pappas
Client Services Manager
Skylar Garfield
Katie Richards
Financial Controller
Nichole Roiland
Junior Analyst
Amanda Paul
SUBSCRIPTIONS + REPRINTS
For a free subscription, please visit ahlmagazine.com. Printed in China. Reprinting of articles is prohibited without permission of Guerrero Howe, LLC. For reprint information, contact Stacy Kraft at 312.256.8460 or stacy@guerrerohowe.com. AHL Magazine® is a registered trademark of Guerrero Howe, LLC.
My physical therapist, for example, would buy me a birthday present every year, including my first and most beloved Beanie Baby, a tiger named Stripey. And at some point during our therapy sessions, we would turn on the TV and make fun of the actors on infomercials as a break from the rigorous exercises that she put me through.
Being seen as more than my disability—as someone with hopes, fears, flaws, and a distinct set of values—formed a bond between my therapist and me that not only made my intensive therapy more fun, but also improved its outcome and made me physically stronger.
The empathy I experienced from my doctors, nurses, and therapists as a kid is why American Healthcare Leader’s cover story this issue, featuring Maurice Sholas of Children’s Hospitals and Clinics of Minnesota, resonates with me so strongly. As the senior medical director of rehab services for the organization, Sholas works with individuals with congenital and acquired spinal cord injuries to help them cope with their injuries and get back to living a normal life.
Although many of Sholas’s patients may have similar injuries, each one might cope with their disability differently. So, instead of taking a one-size-fits-all approach to his patients, Sholas gets to know each of them so he can develop the best plan and administer the best treatment.
Sholas has also learned to practice empathy with individuals who treat him unfairly in his personal and professional life. As a black man, he has experienced countless instances of implicit and explicit bias because of his skin color throughout his life. But instead of getting overwhelmed by these moments, Sholas meets people with a desire to find common ground.
The most effective way that Sholas attempts to connect with others is by showing different sides of himself: he’s a Harvard graduate, an avid New Orleans Saints fan, and a mentor to young adults, among the many other characteristics that make up who he is.
Just like a doctor doesn’t focus on one symptom before diagnosing a patient’s illness, people should strive to see each other as even more than the sum of their parts. Take a cue from Sholas: start to look beyond labels and truly see the person in front of you.

Joe Dixon Editor
Pulse
“Trust is the currency of leadership, and I learned quickly something your title provides.
It’s earned and tested each day.” p. 30
BY JEFF SILVER | PHOTOS BY WEBB CHAPPELL
Steward Health Care System’s community-based providers are helping shape US healthcare
General Counsel

As complex
as US healthcare has become, it may have come full-circle—returning to community-based care. The growth and success of Steward Health Care System is a shining example of how this model can control costs while dramatically improving quality, eliminating care fragmentation, and reducing duplication of services.
Joseph Maher, Steward’s general counsel, firmly believes the health system’s approach is making a difference in how community care is viewed, and that it will go on to play a significant role in shaping healthcare in the near future.
“Our successes have shown the public that communitybased care is far more valuable than it has been given credit for,” he says. “By continuing to expand our networks along with evolving accountable care models, we can make community hospitals extraordinarily relevant in the larger healthcare discussion.”
Maher developed this perspective while he still had his private legal practice and began to get involved in the business activities of numerous Boston-area healthcare facilities. In fact, at one point in the mid-1990s, he served simultaneously as vice chairman on the boards of both Faulkner Hospital, a community-based provider, and University Hospital, an academic teaching facility associated with Boston University.
The dual perspectives that came from working within the two different environments provided Maher with a number of key insights. He recognized that academic medical centers have more salaried physicians and that those physicians’ research, writing, and teaching responsibilities were effective at convincing insurers that reimbursement for services should be more than what is paid to communitybased providers. However, those same academic activities frequently clashed with the productivity and effectiveness of ongoing clinical services.
During this period, Maher also had the opportunity to negotiate, pro bono, the merger of Faulkner Hospital and the Brigham and Women’s system, which created the current incarnation of Brigham and Women’s Faulkner Hospital. After the merger, he saw that the resulting partnership was producing some unexpected benefits.
“Not only are community hospitals economic engines in their neighborhoods, they can provide more than 90 percent of needed care to patients who, as a result, don’t have to travel to larger academic medical centers.”
“Patients who had been historically sent from physician groups to specialists at Brigham were redirected to Faulkner’s community setting, so costs and efficiencies were better managed,” Maher says. “Patients who needed more significant attention were escalated to specialists, which demonstrated that relationships between community and academic organizations can create benefits for everyone involved.”
Maher’s career in healthcare continued to evolve over the next decade. In 2008, he became general counsel at Caritas Christi Health Care, which operated under the auspices of the Archdiocese of Boston. When Steward acquired Caritas Christi in 2010, Maher helped guide the transition and subsequently assumed his current role.
The transaction highlighted the ripple effect created by community facilities. By acquiring the ailing Caritas Christi system, Steward saved 12,000 jobs, preserved 13,000 pensions, and provided an infusion of capital from its financial sponsor, Cerberus Capital Management, that enabled all six of the existing facilities that Steward acquired to continue operating.


“Not only are community hospitals economic engines in their neighborhoods, they can provide more than 90 percent of needed care to patients who, as a result, don’t have to travel to larger academic medical centers,” he says. “That’s just one of the reasons community centers need to be supported.”
A recent Boston Globe article supported that point of view. It compared clinical outcomes, patient satisfaction, and overall cost of care through community providers to other major medical centers in the Boston area. The community providers were found to be equal in quality, superior in satisfaction, and 20–30 percent less expensive.
Part of Steward’s success in communitybased care is founded on strong relationships in its communities. Maher calls it being a good corporate citizen, which helps create personal connections with patients long before they have to visit the emergency department. This includes outreach events such as wellness screenings, but also requires internal attention and investment. Details such as an emergency department’s physical appearance and efficiency have just as much of an impact on the patient experience as clinical expertise—and patient satisfaction has become an increasingly important factor in payer reimbursement.
Maher takes great pride in the fact that Steward provides care in a large number of underserved communities. He even jokes that for a for-profit organization, it is actually more mission-driven than many nonprofit hospitals.
“Patients with Medicaid coverage don’t have the same choices that patients with commercial insurance or Medicare have,” Maher says. “Our feeling is that everyone deserves equal levels of care. It’s one of the reasons that our Good Samaritan facility is one of our busiest.”
Steward is one of thirty accountable care organizations (ACOs) that were selected to participate in Pioneer ACO, a federal Medicare pilot program that ran from 2012 to 2016 (Steward also began participating

Jackson Lewis is proud to support
JR., General Counsel of Steward Health Care LLC
With 800 attorneys in major locations throughout the U.S. and Puerto Rico, Jackson Lewis provides the resources to address every aspect of the employer-employee relationship.
Robert H. Morsilli
Jackson Lewis P.C. 75 Park Plaza Boston • MA 02116 (617) 305-1220 morsillr@jacksonlewis.com www.jacksonlewis.com
Steward Health is adding to the communities it serves through the acquisition of eight facilities from Community Health Systems.
The integration of two Pennsylvania locations and three each in Ohio and Florida will nearly double Steward’s size and is expected to raise revenue from approximately $2.2 billion to $3.2 billion.
“What we’re excited about is the opportunity to bring a better brand of care that we’ve already proven in Massachusetts to patients in other locations,” Joseph Maher says. “Extending our reach is important because it enables us to show that everyone is entitled to high-quality care with good outcomes that don’t bankrupt patients or the healthcare system.”
“Patients with Medicaid coverage don’t have the same choices that patients with commercial insurance or Medicare have. Our feeling is that everyone deserves equal levels of care. It’s one of the reasons that our Good Samaritan facility is one of our busiest.”
in Massachusetts’s Pilot ACO program in 2017.) As part of Pioneer ACO, Steward has distinguished itself by being among the top performers, generating approximately $30 million in savings and top quality-of-care rankings.
Part of this success can be attributed to Steward’s experience working within Massachusetts’s universal care system, which provided a model for the ACA. But Maher also gives credit to Steward’s own management models.
“Our care, case, and disease management are coordinated through primary care physicians,” he says. “Their involvement is critical to developing an ACO model that does a better job of managing all elements of care at every level.”
Now, Steward is participating in Medicare’s Next Generation (NextGen) initiative, a refined and restructured version of the Pioneer program. One of its goals is to investigate the effectiveness of providers sharing risk with payers. Continuing its performance record from the Pioneer pilot, Steward has already successfully partnered with Blue Cross Blue Shield of Massachusetts (BCBS/MA). In this model, BCBS/MA increases payments when Steward reaches critical benchmarks related to measures such as clinical outcomes and patient satisfaction.
Maher isn’t surprised by these positive results and feels gratified when he sees other community hospitals and

Bowditch & Dewey is proud to partner with Joe Maher and the entire Steward Health Care System on their recent initiatives. We wish Joe and Steward all the success in the world.

you

www.bowditch.com

The innovative, community-based Steward Health Care Network includes several thousand physicians who care for approximately 2 million patients annually. Steward’s unique health care service delivery model leverages technology and care coordination to keep patients healthier and in the community. Steward is recognized as one of the nation’s leading accountable care organizations.
academic medical centers attempt to replicate Steward’s approach to care. He even mentions public relations and advertising campaigns in which he has recognized those providers adapting Steward’s branding to highlight the idea of bringing high-quality care to local communities.
“What we accomplish in the pilot programs are the same things we do in our hospitals on a daily basis,” Maher says. “It’s about figuring out the good, the bad, and the ugly, and then embracing change to make improvements so that no one is left behind.”
That philosophy is clearly guiding Steward as it does more to do good—and to do it better—in as many communities as possible. AHL
McDermott Will & Emery is an integrated, international law firm that values integrity, efficiency, and diversity and emphasizes long-term client relationships. As a recognized industry leader, McDermott’s team of legal and regulatory advisors exhibits an unwavering commitment to successfully navigating the rapidly changing healthcare sector. Our dedicated health lawyers draw on the resources and knowledge of our global firm, including colleagues immersed in data privacy, tax, employee benefits, and intellectual property. We create multidisciplinary teams to develop innovative, goal-oriented solutions at the cutting edge of the healthcare industry. Major legal directories have identified McDermott as the undisputed leader in healthcare law.
Jackson Lewis congratulates Joe Maher on his achievements and this well-deserved recognition. We are proud to partner with Joe and his team to provide Steward Health Care System with a wide array of exceptional, value-driven legal services.
Congratulations Joe Maher and Steward Health Care for the well-deserved recognition you are receiving as leaders and innovators in modern healthcare. Bowditch & Dewey is proud of its longstanding relationship with Steward Health Care and looks forward to continuing to provide you valuable, efficient legal services throughout New England and beyond.
Fisher Phillips is a national labor and employment law firm with 350 attorneys and thirty-three offices committed to providing practical business solutions for employers’ workplace legal problems. The firm serves healthcare organizations across the country, large and small, including hospitals, clinics, physician groups and practices, nursing homes, assisted and independent living centers, and more. We value the opportunity to support Joseph Maher’s strategic leadership in labor and employment matters.
Joe Maher has been a friend to many of us at Donoghue Barrett & Singal for decades. His ability to cut to the chase and identify the root cause of an issue constantly impresses us. He is an exceptional attorney and a “counselor” in the truest sense of the word—one who understands not only the industry but also the strategic and political context of his environment. It has been an honor working with him, and we congratulate him on his welldeserved recognition from American Healthcare Leader.



BY KASEY CHEYDLEUR
Allison Melahouris and Benchmark Senior Living create comfortable places where seniors can go to get stronger
Whenshe sees the words “nursing home,” Allison Melahouris of Benchmark Senior Living focuses on one word: “home.” In fact, she has built a career working to confront negative stereotypes associated with nursing homes. Melahouris helps develop senior living communities that embody hominess and replace “nursing” with a more progressive and desirable focus on the continuum of care.
Melahouris found her passion for working with seniors at a young age. As a child, she helped care for all four of her grandparents, and those experiences had a profound impact on her career. In fact, Melahouris decided to study gerontology while attending Molloy College in Long Island, New York, and even took an internship in the activities department of a local nursing home. That internship led to her first job, and she worked as an activities assistant in a nursing home for several years. Although she liked the job and the people she worked with, the design of the facility was identical to thousands of nursing homes throughout the country. So when she got the chance to influence the design of contemporary senior living communities as senior vice president of quality resident services at Benchmark Senior Living, Melahouris deliberately set out to create an atmosphere where residents and associates can make meaningful connections in a comfortable setting.

Melahouris chose calm colors, intentionally cultivated visiting spaces, and added details such as fireplaces to make people feel welcome and at home. She also strives to be at the forefront of technology, which can include earning LEED certification for portions of a community or piloting fallprevention technology developed by researchers at Massachusetts Institute of Technology. When she gives tours of those communities, Melahouris says that visitors sometimes ask where the nursing home is and can’t believe it when she says they are standing in it.
“It creates a much more natural visiting space for folks and a nicer place to heal,” she says. “It’s nice to look at something beautiful and really fight that stigma that nursing homes are bad, scary places. We are trying to create places where
people go to get well, to get stronger so they can go home, not necessarily places where they will live long-term—until they need to.”
A recent success for Melahouris’s team was Benchmark Senior Living at The Commons in Lincoln, a continuing care retirement community not far from the organization’s corporate office in Waltham, Massachusetts. The previous owner of the property had designed the project to encompass the full continuum of on-site healthcare—independent living, assisted living, memory care, and a skilled nursing unit. However, only the independent living component had been completed. To that end, when Benchmark acquired the property in 2013, Melahouris and her team followed through on a promise to the existing residents by presenting designs
“I love being able to face the seniors who live there and know we kept the promise we said we would. I love seeing this whole new building we built. To be part of something from the ground up—literally from dirt to steel to a building—is amazing.”
for assisted living, memory care, and skilled nursing units, and oversaw the construction. The result, Melahouris says, was the most satisfying project she has ever been involved in.
“I love being able to face the seniors who live there and know we kept the promise we said we would,” she says. “I love seeing this whole new building we built. To be part of something from the ground up—literally from dirt to steel to a building—is amazing.”
From choosing the floor tiles to the treadmills to the doctors, Melahouris was involved in every step of the process. She met with multiple hospitals and executive directors and was instrumental in developing The Commons in Lincoln’s partnership with the Mount Auburn Hospital System—a division of Harvard Medical School’s teaching hospitals. At the heart of the partnership is The Commons’ medical director, Dr. John Anderson, chief of the division of geriatric medicine at Mount Auburn Hospital’s Quimby Center for Geriatric Care, and an assistant professor at Harvard Medical School. Under Anderson’s direction, the community is fulfilling its objective to offer that continuum of care, including on-site physical and occupational therapy. And although not every resident will use the services, Melahouris says that many find it reassuring that it is there if they need it.
Melahouris believes senior living and health system partnerships like this have a great deal of potential for the
future of the industry. They offer shared savings for patients and providers and, most importantly, provide a higher level of care with easy communication between both sides. With the baby boomer generation now at retirement age, Melahouris believes such partnerships are the way forward. And looking forward is at the heart of what Benchmark is all about. With fifty-four communities located in seven northeastern states and an imminent expansion into an eighth, Benchmark is striving to design the future of senior living. But as the organization grows, Melahouris emphasizes, they never lose sight of the resident-family culture and the value of creating an atmosphere of warmth and personal connection. She credits Benchmark’s CEO, Tom Grape, who founded the company in 1997, as a key reason for the culture and the company’s success. In January, at the start of the company’s twentieth anniversary year, Grape reinforced that culture by introducing a new mission: “Elevate Human Connection.” Keeping its promises to residents, families, and associates alike is one of the many ways in which Benchmark achieves its mission.
Melahouris gets chills every time she walks through the doors of The Commons in Lincoln, a place where she helped keep important promises, and seeing the building reminds her why she does what she does. And when she sees residents using the equipment she picked out or meeting with doctors she helped recruit, Melahouris knows she is at home. AHL

Medline is the largest privately held manufacturer and distributor of medical supplies uniquely positioned to provide products, education and support across the continuum of care.
Our ability to bring best practices, cost-savings and differentiated solutions from one care setting to another is what sets us apart.
Our specialties include improving resident satisfaction and resident outcomes, improving staff satisfaction, reducing costs, enhancing quality, increasing revenues, clinical expertise, medical-grade/ best-in-class products, equipment and furnishings.
Visit medline.com/assistedliving to learn more or call 1-800-MEDLINE to request a copy of our assisted living capabilities brochure.

Boston and South Shore
We Take Care Of Innovators –And Imitators.
Since 1924, we’ve been protecting and defending intellectual property rights – in Germany and around the world. The fact that our practice regularly takes a leading position in independent rankings is not only due to our professional expertise –but also to our emphasis on building close partnerships with our clients. That’s why each of our clients is assigned a like-minded and personally compatible contact person for their individual support. www.grunecker.de
Proudly serving the patients and residents of Independent, Assisted and Skilled communities throughout the Metropolitan Boston area
RESIDENT-SPECIFIC PRODUCT
ORDERING AND DELIVERY
CONTINENCE MANAGEMENT
STAFF EDUCATION
INVENTORY MANAGEMENT
PROGRAM MANAGEMENT
MARKETING SUPPORT
BOSTON 617-500-6999
SeniorHelpers.com/Boston
SOUTH SHORE, MA
781-421-3123
SeniorHelpers.com/SouthShoreMA

Thanks to strong teamwork and innovative problem solving, John Pantazis sees continued growth ahead for Heartland Dental
BY CHRIS GIGLEY
Pantazis learned a lot about leadership in law school and in his subsequent legal career. But part of the experience he draws on to make intelligent, forward-looking plans as executive vice president, general counsel, and secretary at Heartland Dental comes from the gridiron.
“So much of success in business is about building a good team,” says Pantazis, who played defensive end at the University of Northern Iowa. “Football and other team sports are a helpful analogy because everyone is truly working toward the same goal. We push each other, and it isn’t always perfect, but at the end of the day, we’re all pointed in the same direction.”
At Heartland Dental, that direction is advancing the art and science of dentistry, which in some ways remains a cottage industry: many dentists manage everything in their practices, including bookkeeping, marketing, and personnel. Heartland Dental is leading a shift in that industry, serving as a one-stop, back-office resource for supported practices—and the appeal to dentists is clear. With Heartland Dental’s support, they can focus more on their patients and less on the day-to-day administrative aspects of managing a practice.
The potential of this market is massive. Founded in 1997 by dentist Dr. Rick Workman, Heartland Dental had about five thousand employees when Pantazis joined the company in 2012 as its first general counsel. The organization has doubled in size since Pantazis arrived, and now has more than 8,700 team members who support 1,200 dentists at more than 775 offices in 34 states. More than 600 employees work at its headquarters in Effingham, Illinois.
Pantazis knows Heartland Dental is not done growing. Despite rapid growth and the fact that the company is the largest player of its type in the United States, he says that the company serves just 1 percent of the market.
“Doctors are demanding our service because they like the freedom it gives them,” Pantazis says. “We have more room to grow than we know what to do with. We like to say we’re in the second inning of a nineinning game.”
Pantazis is confident that he can help Heartland Dental play a winning game. He enjoys that both the business and his job are constantly evolving as the company grows. At this point in the company’s evolution, his focus is on people.
“We’re working on building world-class legal, corporate compliance, and employee relations departments,” says Pantazis, who also oversees Heartland Dental’s dental insurance administration department.
He says part of the draw for potential hires is getting to solve problems that no one has had to deal with before. From a legal perspective, that means designing legally compliant architecture for different states and dealing with anticompetitive regulatory challenges.
Solving new problems isn’t limited to the legal team. As part of a progressing dental support industry, every team at Heartland Dental—whether marketing, accounting, HR, or field support—has the opportunity to take on new challenges and advance personally and professionally. Above all, Heartland Dental team members get to make a real impact in an industry that mostly continues to operate the way it did decades ago.








OGLETREE DEAKINS congratulates JOHN PANTAZIS and proudly celebrates its longstanding relationship with the Heartland Dental team and the opportunity to provide labor and employment services on a national basis.






EMPLOYERS AND LAWYERS, WORKING TOGETHER.
Brian L. McDermott brian.mcdermott@ogletree.com
Robert F. Seidler robert.seidler@ogletree.com
ogletree.com
“We have more room to grow than we know what to do with. We like to say we’re in the second inning of a nineinning game.”
“We don’t just shuffle paper,” Pantazis says. “We solve problems that need to be solved, and our employees have an opportunity to create an impact at the organizational level. You don’t get that everywhere, but you do at a growing company like this one.”
That opportunity to break new ground every day keeps Pantazis and his fellow Heartland Dental team members motivated and focused, and those opportunities should keep coming. Heartland Dental is growing on two fronts: building new dental offices and affiliating with existing ones.
“We’re always learning new things as we grow, so we always have to be open to new ideas,” Pantazis says.
Pantazis’s management style is a perfect fit for that dynamic. His approach is all about being the right type of leader in any given moment, which allows him to adapt to the individuals he works with. For example, someone with significant experience and proven ability gets more delegation, while newer, more inexperienced team members receive more directing and coaching.
“When you deal with growth, you have to accept the fact that there will always be problems to be solved, and that’s OK,” Pantazis says. “You stay focused on what needs to happen. You have to find the right solutions. You have to be strategic.”
And of course, you need a great team that’s focused on the same goal. That’s “Team-Building 101,” whether it’s on the football field or in the boardroom. AHL
BY JEFF SILVER
Encompass Home Health & Hospice’s culture of transparency and strong personal relationships sets it apart from its competitors
Cliff Blessing SVP of Development
Hospice

Whenhe came to work for Encompass Home Health & Hospice in 2012, Cliff Blessing had to make some adjustments. He had extensive financial experience but was new to healthcare. That meant getting used to an entirely new nomenclature, new acronyms, new payment methodologies, and new compensation models that he found to be surprisingly nuanced and complicated. He also had to learn healthcare’s highly complex regulations and compliance requirements, especially as the organization’s mergers-and-acquisitions plan meant even more big changes.
However, the appeal of Encompass’s culture, which emphasizes engaging and nurturing employees, made adapting worth the effort. As the company pursues an ongoing strategy of mergers and acquisitions, part of Blessing’s job is to ensure that the culture is maintained and nurtured throughout a rapidly expanding national home health and hospice care network.
“Maintaining our culture of mutual trust among staff, empowering employees, and encouraging them to share their opinions is a challenge the bigger we get,” Blessing says. “But one of our top priorities is focusing on employees and helping them do their best by giving them the right training, resources, and tools so they can keep doing what they love: caring for patients.”


Blessing and the rest of the company’s senior leadership have succeeded in keeping that focus throughout Encompass’s 100 agencies around the country, which include 226 locations and 8,000 employees.
Encompass’s culture is more than just a competitive differentiator that Blessing says leads to better patient outcomes; it is an intentional objective that the company emphasizes from the outset of all M&A activities. That begins with honest and transparent communication from the Encompass integration team. Then, the team goes on to spend eight weeks at the home office of newly acquired companies. This time provides Encompass with opportunities to build strong personal relationships with new employees and to learn about the acquired company’s existing practices and procedures firsthand.
The integration process continues when new full-time employees come to the Encompass Development Center in Dallas for three days to learn more about the organization and to interact directly with CEO April Anthony, COO Tracy Kruse, and other senior leaders. Additionally, the Encompass team holds general orientation programs at each new local agency location to familiarize new staff with employee benefits and other important details. Encompass has assigned each new location a “buddy agency” that is
The Encompass Cares Foundation extends Encompass Home Health’s mission beyond day-to-day service to patients. The Foundation’s Medical Missions program helps subsidize travel-related expenses for current and retired employees and affiliated partners who care for the medically underserved around the world. Other funds help patients and families who need assistance with home adaptation, food, medical equipment, and household supplies. The foundation also aids staff in need through its Employee Emergency Relief Fund.
already part of the Encompass family to help facilitate the onboarding and integration processes.
“We put a tremendous amount of effort into building productive and trusting relationships,” Blessing says. “Even larger companies we’ve acquired don’t have the same kind of intentional culture building exercises that we do. It really sets us apart from the competition and helps maintain our low turnover rate.”
Another of Blessing’s responsibilities is helping to identify appropriate companies to add to the existing network. Culture plays an important role there as well. Even if a company has strong revenue growth and a positive margin profile, there can be signs that its leadership is not appropriately aligned with Encompass’s values. For example, if a large group of employees all have distinctly different compensation packages, this can indicate a pattern of shortterm decision making that interferes with developing a comprehensive long-term strategy.
“Separate individual deals that are trying to please everyone indicates that the leadership can’t truly be committed to taking care of each person equally,” Blessing explains. “That’s an extraordinarily important commitment for us and an equally important factor to consider.”
Blessing and his team’s efforts to preserve and maintain the Encompass culture were put to the test in 2015 when the company undertook the largest transaction in its history: the acquisition of CareSouth’s forty-five home health locations in seven states for $170 million. The deal, which broadened Encompass’s presence throughout the Southeast, included more than twenty times the number of locations usually involved in the company’s transactions and represented a price that was more than seventeen times larger than its previous average deal.
CareSouth and Encompass both use HomeCare HomeBase, a software solution that Encompass originally developed internally for all back-office and clinical operations. This helped ease the IT integration, but the overall logistic complexity made it impossible for CEO Anthony and COO Kruse to personally announce the deal at each of CareSouth’s locations as they would traditionally have done. Instead, numerous members of the leadership team pitched in to help cover all of the locations in less than a week. Anthony and Kruse also managed to arrange personal visits to each new site within the following year.
Blessing expects that kind of approach to continue. “Encompass is moving forward with efforts to consolidate the home health and hospice care markets,” he says. “That has already made us a large company, but when it comes to strong personal relationships and interactions, we won’t be acting like one.” AHL

Lockton is a global professional services firm with 6,500 Associates who advise clients on protecting their people, property, and reputations. Lockton has grown to become the world’s largest privately held, independent insurance broker by helping clients achieve their business objectives.

of
BY RANDALL COLBURN | PHOTO BY GILLIAN FRY
By giving surgeons a say in strategic vision, Matthew Balog is allowing for greater autonomy and accountability among Advocate Christ Medical Center’s surgeons
won’t find Matthew Balog donning a surgical mask and carrying a scalpel, but you will find him in scrubs. The director of business operations - surgical services for Advocate Christ Medical Center stays close to the surgeons, working behind the scenes to set the vision and strategy for the surgical services team.
Balog thrives in the field’s demanding atmosphere. “I love the fast-paced surgical environment,” he says. “Every day is a new challenge.” As such, Balog says that it’s imperative that his leadership style remain fluid.
“I adapt my leadership style to match the needs of the project or task on a daily basis,” he explains. While some decisions are protocol-driven, he encourages his staff to solve others on their own. That requires a great deal of trust, an integral component of Balog’s business philosophy.
“I continuously focus on building relationships with my associates and physicians,” he explains. “Trust is the currency of leadership, and I learned quickly that trust isn’t something your title provides. It’s earned and tested each day.” Balog spent the early years of his career engaging directly with the most difficult aspects of his job. “I didn’t want to wait ten years to establish two years of critical conversation experience,” he explains. “I’ve never shied away from a difficult conversation.”
That attitude led to one of Balog’s most ambitious initiatives: reshaping Advocate Christ Medical Center and the way the surgical department collaborates with its surgeons. For him, a surgeon is much like a customer, a
description he feels has developed a negative connotation in the industry. “The word customer implies that the consumer has a choice,” he says. “Both my patients and my surgeons have choices. It’s my job to influence them to choose Advocate Christ Medical Center.”
A governance committee was formed to meet the needs of the hospital’s customers. Members of the committee are recognized as the senior leadership of the surgical services department, and their roles and responsibilities include making operational and capital decisions that align with the hospital’s strategic plan. The committee includes several surgeons, which is rarely the case in committees such as these. Even more unique is that the selected surgeons are handpicked.
Committees for surgeons are common at most hospitals, but they’re not typically as interwoven into the development of the department’s big picture. “These committees often serve as a conduit of information, basically telling physicians what is going on as opposed to a collaborative effort,” Balog explains. “This new model invites our surgeons to have a seat at the table. There, they can vote and have a say in the strategic vision of the department.”
Integrating surgeons into Advocate Christ Medical Center’s governance committee helps streamline the decision-making process for everyone involved. For example, in issues of noncompliance, physicians can address their concerns not with a member of administration, but rather a fellow physician on the governance committee. Through










As a global leader in healthcare services, we connect the world of medical products to the point of care.
Complexity undercuts efficiency and adds billions of dollars to the cost of delivering patient care. Owens & Minor provides the end-to-end expertise to streamline every link of the supply chain—from point of manufacture to point of care
PRODUCTS
www.owens-minor.com
“Trust is the currency of leadership, and I learned quickly that trust isn’t something your title provides. It’s earned and tested each day.”
intimate conversations like these, the committee allows for more transparency and greater accountability.
“I wouldn’t say it’s the first time ever that physicians were holding each other accountable,” Balog says. “But it was a culture shift in that it’s not an administrative, topdown approach.”
Other benefits of this model include Balog and his team’s ability to recruit “champion ambassadors,” surgeons who can help cultivate support for the department’s key initiatives from their colleagues. They will be important as Balog works with his dedicated project management team to steer Advocate Christ Medical Center’s surgical services team toward the future. Having a presence on a governance board, after all, means that you have the patient, physician, and department interests in mind.
“Once we’re all rowing in the same direction, this alignment will naturally begin to break down the issues and help identify more opportunities for improvement,” he says.
This new method boils down to ensuring that the patient is receiving the safest, most efficient care with the best outcomes. “In healthcare, we find common ground in the intrinsic motivation to care for our patients,” Balog explains.
This new governance committee proves that philosophy; as far removed as it is from the operating room, it is driving necessary changes in the department. Those within it are making an impact that will refine and fortify Advocate Christ Medical Center’s core mission, which is to create “the best place for patients to heal, physicians to practice, and associates to work.” By remaining close to everyone that his work affects, Balog is able to uphold that mission. AHL
Congratulations Matt for being recognized as the passionate, committed leader you are! Owens & Minor is proud to partner with you to save AHC millions by implementing a truly sustainable, real-time preference card management system and inventory program leveraging our O&M Consulting Solutions, SurgiTrack Unitized Delivery, and Preference Card Analytic Program.
BY ELISE GRUNEISEN
When Joe Capp turned his HR team’s focus toward engaging with other employees, he breathed new life into a lagging department
excellence, accountability, and initiative: these are the values that Joe Capp brings to the office every day and the ones echoed as core values for Meriéux NutriSciences. But upon entering his role as vice president of human resources - North America, Capp found that his values were not as readily shared by other members in his department.
When Capp was first hired, Meriéux’s HR department didn’t focus enough on employee development. “They had neither the plan nor the people capable of driving and influencing the initiatives and behaviors required to accomplish Meriéux NutriSciences’ goals,” Capp says. “As a result, employee engagement was low and turnover was high in our laboratories. This constant churn of people led to service errors, which disappointed our customers.”
Assess Everyone’s Needs
Rather than balking at the lagging department, Capp rolled up his sleeves and immersed himself in the task at hand. To
find the root of the problem, he conducted independent research and face-to-face interviews with employees at all levels of the organization.
Capp credits his successful track record in sales as the key to this step. “The best salespeople don’t talk,” he says. “They listen.” Many of the issues Joe recognized in Meriéux NutriSciences’ culture resulted from a lack of communication between HR and employees and employees’ ignorance of how to handle HR issues. Breaking down those communication barriers helped Capp gain a thorough perspective on what programs were working and what could be improved or removed.
“When you’re trying to develop a solution, you should never go into it thinking, ‘I know what I’m doing. Let me handle this,’” Capp says. To effectively solve pain points, he says that it’s important to know why a solution is needed in the first place and then see how the products and services you offer can directly improve on those issues.
Capp’s observations have allowed him to do just that. He was able to get a clear snapshot of what employees generally liked or disliked.
Capp used this information, along with Meriéux NutriSciences’ objectives for future growth, to develop a new HR strategy within forty-five days, and the company’s leadership responded with sweeping approval.
Capp knew he needed to prioritize restructuring the HR staff if the plan he’d outlined was going to get real traction. To reevaluate the department, Capp had to combine human interaction with data-driven tests and analyses. He is a proponent of psychometric testing for this purpose; he feels that it allows an unfiltered glance at an employee’s abilities and comfort zone, which is weighted in the pool of information collected throughout the entire application process.
The usefulness of these data points does not end when the individual gets hired. Rather, it is retained and referred to throughout the employee’s career.
“Psychometric testing is just one data point that we use to evaluate an individual during our selection process,” Capp explains. “It is extremely helpful in understanding team dynamics and establishing a development plan for the individual.”
With the company’s short- and long-term goals in mind, Capp invested in an HR team that shared that vision. To lead effectively, he first communicates objectives, team member roles, schedules, budgets, keys to success, and risks to his team. The duty that he prioritizes above all in his role is to secure the tools and resources that best empower his team to achieve the end result they envision.
In the early days of the new HR initiative, one of the key changes Capp made was to replace the company’s payroll system with Paychex. Capp recalls that the company’s existing system was so outdated that the vendor no longer supported maintenance services for that model of the product. Payroll errors created significant stress for employees, which prevented them from delivering their best work in the office or lab.
“The transition to Paychex has impacted the quality of life of our employees significantly,” Capp says. “We reduced the
number of payroll errors each pay period by 80 percent within weeks of implementation.” Paychex also provided a streamlined onboarding system for new hires. Now, employees can focus more time and energy on getting acclimated to the company.
And once his team has the appropriate tools, Capp makes sure they feel empowered to use them. “I get out of their way,” he says with a laugh.
Capp’s leadership has prepped Meriéux NutriSciences for further growth and achievement. Today, he builds programs and provides administrative support for his HR team as they work to impact profit, revenue, and operations. They continue to develop and test programs to enhance employee engagement by improving the day-to-day work environment. This includes moving away from the standard five-day, forty-hour work week parameters; creating systems to facilitate shared work across Meriéux NutriSciences’ largely remote workforce; and a host of other projects. The ultimate goal is to eliminate complications and frustrations that impede employee communication and collaboration.
Capp finds that the higher he moves within an organization, the more he becomes responsible for both strategy and people. Businesses are their people, he notes, and when an HR department is failing, the company suffers as a whole.
“Our HR team is leading the charge to ensure employee engagement is maximized,” Capp says. The difference is palpable, both within and beyond Meriéux NutriSciences’ walls. AHL
When Joe Capp, vice president, human resources - North America, Mérieux NutriSciences, wanted to drive HR and business transformation, he considered and reviewed leading HCM companies. He selected Paychex for our robust HCM technology platform and our ability to manage the relationship long term. He was confident that our technology and support fits their current needs and scales with ease as their needs change.
Paychex, Inc. is a leading provider of human capital management solutions including payroll, HR, retirement, and insurance services. By combining our innovative SaaS technology and mobility platform with scalable human resource solutions, Paychex empowers businesses to focus on their growth.


Congratulations to our client and colleague Joe Capp, Vice President, Human Resources – North America, Mérieux NutriSciences Corporation on this well-deserved recognition by American Healthcare Leader! Paychex applauds Joe for his visionary leadership and unwavering dedication to business transformation through HR innovation.




BY RUSS GAGER
Robert Turner and his dedicated team seek out and retain the most passionate and skilled healthcare professionals for Los Angeles County’s L.A. Care Health Plan, the largest public entity in the county
during his commute on public transportation to his position as chief human resources officer at L.A. Care Health Plan, Robert Turner was thanked for his organization’s aid by a fellow commuter’s daughter. Another time, a grateful resident told him that L.A. Care employees were lifesavers. “That’s what drives me,” Turner says.
Having worked in several industries in the private, public, and international sectors during his twenty-five-year career as a human resources executive, there was a time when Turner didn’t have the satisfaction that comes with healthcare’s meaningful work. About thirteen years ago, while visiting one of Tenet Healthcare California’s twentysix hospitals in the Los Angeles area, he witnessed the dedication of the employees. That’s when it struck him.
“I was looking to try to give something back as my career matured,” Turner says. “I was impressed with the caliber of dedication of the doctors, nurses, and technicians. They were saving lives and really helping the people in need.”
Before joining Tenet Healthcare in 2004, Turner had spent most of his career as an HR professional at high-tech and manufacturing companies. But Tenet’s recruiters were attracted to Turner’s management experience in the private sector and his multiple advanced degrees: a bachelor’s in political
science from Ripon College, a master’s in international relations from Brown University, a master’s in organizational development from Pepperdine University, and a doctorate in management from Pacific Western University. After his initial visit, he decided to head up HR for all of Tenet’s hospitals in California, and in his work there, Turner found meaning in working with truly remarkable employees.
“I was on the committee selecting the caregiver of the year award, and there wasn’t a time it didn’t bring tears to my eyes with the dedication that people had,” he says. “That gave me the bug to do something that was not only beneficial for the organization and my own career, but something that was beneficial for other people, as well.”
After Tenet Healthcare, Turner moved from for-profit to nonprofit healthcare as vice president of human resources at AltaMed Health Services. The largest federally qualified nonprofit health clinic chain serves approximately 350,000 patients, many of them Hispanic residents in South Central Los Angeles, where Turner grew up. He appreciated that AltaMed brought medical services directly to residents of South Central and East Los Angeles. When he was growing up, clinics and independent doctor’s offices were few and far between. Now, he was helping make a difference in a community close to his heart.
Then, in 2013, Turner received a phone call from the nonprofit L.A. Care Health Plan, which was going through a major transition. After the ACA became law in 2010, L.A. Care Health Plan was experiencing exponential growth as federal Medicaid dollars flowed into the Medi-Cal system. Vast numbers of low-income Los Angeles County residents now had health insurance—many of them through L.A. Care. This resulted in a similar explosion of personnel at L.A. Care, from approximately 350 employees to 2,000 over a three-year period.
During the call, Turner realized he could impact many more people at L.A. Care— up to 2.1 million Los Angeles County residents—by helping L.A. Care’s further growth. Now, for the past three years, Turner has served as the healthcare organization’s chief human resources officer, and during that time, he’s spearheaded many projects to help the organization provide quality care to its members.
At the center of his work is the idea that satisfied employees provide better care for residents. One of the proudest moments in this realm came in 2016, when Turner worked with L.A. Care CEO John Baackes and the plan’s board of governors to secure a $15 minimum wage for all of L.A. Care’s 1,900 employees—four years before the city of Los Angeles will mandate that pay level in 2020. In fact, L.A. Care was the first major employer in Los Angeles to offer the new $15 minimum wage for all of its employees.
To ensure that L.A. Care employees are continually improving, Turner and his forty employees and five senior directors implemented a new performance-based management system. Employees now set personal goals, and the program measures success quarterly and provides them with feedback from supervisors and opportunities to improve or exceed their initial goals.
Additionally, Turner helped L.A Care restaff and reorganize its recruitment process. The company now has a new, mobile-friendly recruitment website aimed


“Just because you are poor doesn’t mean you have to settle for secondclass healthcare.”
at the higher end of the healthcare market. It also utilizes a service-level agreement that holds recruiters and managers accountable for keeping the recruitment process proceeding promptly. As a result, Turner reports that L.A. Care’s average time to fill a position is thirty-nine days compared with the national average of fifty-two days.
“We want to be able to treat applicants with a significant amount of dignity and respect, get back to them promptly, and manage that process in a way they deserve as professional employees,” he says. “That’s all the way down to entry-level people. I believe if you treat people with respect and you set that bar high at the beginning, people will respond.”
Once employees join L.A. Care, the organization provides them with opportunities for growth and continued learning in an effort to increase retention and satisfaction, Turner says. “As a nonprofit, I cannot be as generous financially as some of our private-sector counterparts, so we do have to focus our team on providing superior-quality service,” he explains. “Just because you are poor doesn’t mean you have to settle for second-class healthcare. To accomplish this, the team has to feel good about themselves.”
To promote its employees’ personal growth, L.A. Care provides up to $7,500
annually for each employee’s education. “Just about everybody here can go someplace else and get more money, so money can’t be the main driver,” Turner says. “Giving back to the community and having that mission-driven passion has to be a primary driver. If someone coming into this organization has that drive and passion, they would never work a day in their life because they have the knowledge that what they are doing is so significant to the people we are helping—things that really matter to this city and the members and their families that we impact. I make sure the organization continues to be committed to taking care of residents to the fullest extent possible.”
In partial recognition of these accomplishments and others, Turner was voted the HR executive of the year in Los Angeles for 2016–17 by the National Human Resources Executive Association.
As L.A. Care Health Plan celebrates its twentieth anniversary, employee retention isn’t the only challenge the future holds. As with any organization that serves Medicaidreliant populations, repealing the ACA could threaten the organization’s mission. “You don’t throw the whole thing out,” Turner says. “At the end of the day, I still have 2.1 million people in Los Angeles that need our help and don’t have adequate healthcare. So we have to be the best at what we do.” AHL

BY PAMELA SORNSON
After rapid, massive growth at Thomas Jefferson University and Jefferson Health, Jeffrey Stevens envisions an HR ecosystem that will appeal to its thousands of diverse employees
WhenJeffrey Stevens joined Thomas Jefferson University and Jefferson Health in Philadelphia, he knew he’d need his two decades of HR experience and his abiding love of technology. Over his first eighteen months, his plans became much more complex, as the institution continued to expand through clinical and academic mergers in the Philadelphia region to become Jefferson, an organization that now includes eleven hospitals, two universities, and thirty thousand team members. The growth spurt meant all of HR had to integrate into a single enterprise function, and the disparate and separate HR systems needed to be merged. For Stevens, Jefferson’s executive vice president and chief human resources officer, that meant the fun was just beginning.
After the mergers, Stevens would consolidate the HR systems of its five main divisions to essentially create a single employee record. Until then, there had been no common language across department names, jobs, job paths, reporting relationships, or titling, among other
structural references that needed to be rebuilt for the new Jefferson. Additionally, HR systems are notoriously disengaging and often seen as providing somewhat limited value to end-users, managers, and employees. That had to change, and the technology system would have to be built not just for the present, but for a rapidly changing future.
Thanks to his years of HR tech experience, Stevens understood how each of the separate systems were functional but inadequate for the goal of changing such a large workforce. The new HR system would have to offer the tools and insights needed for an organization to manage its workforce and inspire employees to seek out learning and develop career paths for themselves. By creating a culture where performance and learning are one’s credentials and become the inputs into development plans, the possibilities are endless in terms of growing talent throughout Jefferson.
Stevens’s vision of a perfect HR ecosystem is that every team member at Jefferson is engaged and participates in learning and collaboration opportunities. “Our
future is about connective or collaborative intelligence,” he explains. “Encouraging employees to build and manage their professional profiles will help people find others like them and connect.” Stevens envisions that the system will connect people to spread best practice ideas, bring teams together, and facilitate discovery, innovation, and even organizational initiatives such as wellness. RedBrick, Jefferson’s partner in wellness, has proven successful by doing what Stevens hopes other system functions will do—connecting people and giving them access to information and engagement. One of the greatest opportunities the system will bring to Jefferson is the ability to rethink its performance program. HR professionals are now thinking seriously about major changes to performance management. Conversations are underway about working without employee rankings, continuous feedback and 360 reviews, recognition badges, and the importance of goals. Stevens vision involves shaping technology through thoughtful design and
creating the type of online engagement that these new performance ideas require.
Design will be a major part of the new Jefferson system. “We have to design technology in a way that people like: think Facebook, LinkedIn, Instagram, and Snapchat,” Stevens says. “We can give employees precisely what they want and need in terms of personal data, tracking education and career objectives, and more.”
Additionally, the system will be able to engage every Jefferson team member, from newly hired maintenance staff to the C-suite, with content and messaging appropriate to each person’s role. As a result, the system will help declutter inboxes and get everyone focused on what they need to do to make Jefferson exceptional.
Stevens began the project by migrating employees from other systems onto Oracle’s Peoplesoft platform, which serves as the core human resources management system. For the talent management functionality that Stevens envisioned, he turned to SAP’s SuccessFactors, specifically their

“We can give employees precisely what they want and need in terms of personal data, tracking education and career objectives, and more.”

Day in and day out, you make a difference
“Jefferson essentially gave me a blank canvas, and I’m working to a build a future-ready workforce.”
performance, learning, and Jam modules— the latter of which offers the front-end design and collaboration features.
The resulting overarching Jefferson “experience” will take users into a beautiful portal that includes their profile, their job and career planning pages, performance tools, and collaboration communities, along with internal and external organizational news and data. Stevens expects that the fully functional system will engage its users just like other forms of social media technology do, virtually assuring its swift adoption once the system is live. “Like Facebook, the more our people engage with the program, the more the program will reflect the realities of Jefferson and its commitment to excellence,” Stevens says.
A system like this has capabilities beyond improving some traditional HR activities. “I see a group of heart surgeons, for example, remotely collaborating and challenging each other through a Jam portal while a procedure plays on screen,” Stevens says. He sees the program’s capacity to turn Jefferson’s educational mission and capabilities over to its majority-clinical workforce. Jefferson’s College of Population Health and its Institute for Emerging Health Professions are just two examples of the rich resources for instruction and content any major clinical system needs. “Jefferson is already showing the combined strength of its parts,” he says.
So far, Stevens’s two biggest challenges have been socializing what is essentially a visual message (how an organization can function at its peak using technology), and of course the larger goal of creating a common culture that changes the frame of reference for virtually every team member. Stevens has shown that he is
already hard at work and expects issues and challenges to become the focus of further innovation—HR as a continuous improvement laboratory, aided by a firstclass system.
This year is just the beginning of a launch that, if executed correctly, will last a generation or more and take Jefferson to a whole new level of performance and engagement. “Jefferson essentially gave me a blank canvas, and I’m working to build a future-ready workforce,” Stevens says. ”I’ve been thinking about this my entire career, so having the opportunity to engage across a system as large and complex as Jefferson has been a thrill.” AHL
Congratulations to Jeffrey Stevens and the Thomas Jefferson University and Jefferson Health teams. Aetna applauds your contributions to creating better healthcare for the communities you serve and is proud to be a key partner in delivering the innovative healthcare solutions your employees and their families depend on each day.
Aon is proud to partner with Thomas Jefferson University & Jefferson Health in the areas of health & benefits and retirement & investment consulting. We applaud Jeff Stevens and his team for their innovation and dedication to the healthcare industry.
Healthier caregivers, healthier patients, and a healthier bottom line? YES.
A healthy workforce has a halo effect on patient and business outcomes. RedBrick Health engages your people to say yes to building habits that improve energy, focus, resilience, and specific health issues. After all, we serve more than four hundred hospitals nationwide.











Healthier caregivers, healthier patients and a healthier bottom line?


We believe in commitments that empower results.
As a leading global professional services firm providing a broad range of risk, retirement and health solutions, Aon colleagues utilize proprietary data and analytics to deliver insights that reduce volatility and improve performance.

aon.com









RedBrick Health engages your people to build healthy habits that create more energy and focus, better resiliency under stress and lower health risks.
Want meaningful engagement and real results? Put our experience serving more than 400 hospitals nationwide to work.
Say yes to RedBrick.
For more information about how we can help, contact us at healthsystems@redbrickhealth.com
Independence Blue Cross salutes Je rey Stevens and our partnership with Thomas Je erson
University. Through our shared commitment, we embrace a bold new patient-centric model known as the Independence Facilitated Health Networks, to improve quality of care and reduce health care costs for our members.



BY JONAS WEIR
Donald Bunnin of Allergan details the advice that legal professionals need when moving into the healthcare sector
When Donald Bunnin was a freshman at the University of Michigan in 1994, he began studying biology and chemistry with the intent to go to medical school. However, after two years of premed, he realized that medical school wasn’t going to be the place for him, so he switched his major to political science. From there, Bunnin followed a familiar path for political science majors: he enrolled in law school.
Although it may not have been his original intention, Bunnin went on to graduate from the USC Gould School of Law and have a successful, diverse career in law—including five years at Latham and Watkins in litigation, where he worked on intellectual property, copyright, trademark, unfair competition, and other related work; two years at a boutique litigation firm in Chicago; a small stint at a plaintiff firm; and a year at Greenberg Traurig, where he did government investigation and enforcement action work. At each firm, he quickly excelled.
In 2010, almost twenty years after he first set his sights on medical school, Bunnin joined the healthcare industry at global pharmaceutical company Allergan. Since then, he has moved up from litigation counsel to senior litigation counsel to the executive director and senior counsel for litigation and commercial eye care.
How did you first come across Allergan?
Bunnin: I spent about two years of my time at Latham working for Allergan on a case involving BOTOX Cosmetic. It introduced me to some of the people in Allergan’s legal department and in other parts of the company as well as to one of its flagship products.
What type of adjustments did you have to make moving in-house for Allergan?
Bunnin: When you’re at a firm, you’re the front line of the case. You deal with opposing counsel, draft briefs, take depositions, review documents, and prepare witnesses. You’re in the nuts and bolts of the case. As an in-house litigator, you’re more of a case strategist and facilitator, doing strategy analysis and marshaling resources. In my case at Allergan, I
have anywhere from forty to eighty cases at a time. In some sense, it’s what I would expect it’s like as a senior partner at a firm but without business development or firm governance responsibilities.
If you’re a senior partner at a firm, you can’t draft all the briefs, take all the depositions, etc. You have to be at a much higher level, strategizing and working with your colleagues and the client to steer the ship toward that ultimate goal.
There’s also some give and take. You’ll have to give up some things you like. I liked writing briefs; I liked depositions and arguing in court. I don’t do that anymore. However, I also gave up some things I didn’t like, such as extensive document review and legal research. Conversely, there are things in-house that I didn’t have much of an opportunity to do before, such as mediations and arbitrations. A lot of that I really like.
The other big thing is that you’re advising a business, and businesspeople can be very different from lawyers. As an example, at a law firm, the memo to file might be eight or ten pages, going through an issue, citing all the cases, and setting out all the caveats. That isn’t typically how the business world works. When I’m dealing with my business colleagues, I can’t send them a lengthy memo. They live in a bullet point world where it’s results-oriented; businesspeople want concise answers. It’s not a law school exam. And I don’t mean that in a negative way to law firms or lawyers; it’s just a different world. They don’t have time to read the fourteen-page memo.
The other thing is there’s a huge difference in not being on a billable hour. You’re not judged in any way by the amount of time you spend. You’re judged more on efficiency and results. Those are also important at law firms, but there usually is the addition of billable hours.
Is there any other advice you would give to lawyers that are transitioning in-house?
Bunnin: First, learn your business from top to bottom. If it’s a pharmaceutical company, know the products, their labels, indications, and safety profile. Get to learn the key people for the products. You need to know people in R&D and commercial. The more people you know, the better lawyer you can be. If you know the folks in R&D and commercial, you can make better decisions about your case, like who has the information you need and who would make a good witness. Learn the company. Who are the people in finance? Who are the people in public relations? Who’s in HR? The more people you know, the better advocate you can be on behalf of the company. It will also help you be more efficient.
What else has helped fueled your success at Allergan?
Bunnin: One thing that’s important, especially for in-house litigators, is to get the businesspeople comfortable with the legal department. For many nonlawyers there’s a natural apprehension causing them to be nervous around lawyers.
The second thing is that from the moment you have a legal matter, step one is figuring out the endgame and working your way back from that. Sometimes it’s hard to figure that out, and it takes a little bit of time, but that’s really step one.
The third important thing is that you need to have good relationships with your outside counsel and have a lot of trust in them. They need to trust you, too. Otherwise, the relationship isn’t going to work. I need to know that you’re giving me sound legal advice. And sometimes that means that you have to give me bad news.
The worst scenario is an outside lawyer who says, “You have a great case. You’re totally going to win this.” And I spend three years working the case up with that lawyer, spending hundreds of thousands if not millions of dollars, and then on the eve of trial, that lawyer comes to me and says, “This case is really bad. The law’s bad for you, the facts are bad.” That’s the worst outcome.
The best in-house lawyers I’ve seen view it as a team, and the team rises or falls together. They’re OK with an outside
“In-house lawyers need to be comfortable being wrong and being told no.”
lawyer saying, “I got your idea, I think it’s the wrong way to go, let’s do something else.” In-house lawyers need to be comfortable being wrong and being told no.
What are some of the benefits to practicing law in healthcare?
Bunnin: If you’re intellectually curious and want to be challenged, healthcare is a highly regulated space. You have FDA regulations and guidance, various state health agencies, etc. There are so many laws in this area that you need to get comfortable with if you want to be effective and knowledgeable in this space. There’s always something new to learn.
It’s also a high-profile industry. As you can imagine, federal and state governments look at our conduct closely. The plaintiff’s bar looks at our conduct closely. Various other stakeholders look at it, too.
The variety that healthcare provides is very intellectually challenging. It can be a lot of fun. Along with that, law firms have rightfully identified healthcare as an area where they want to practice for the exact same reasons I just mentioned. So we get to work with some of the best law firms in the world; some of the most talented lawyers in the country, and I get to read their writing and pick their brains. I get to strategize with them and work with them on a daily basis. It’s a fantastic way to learn and grow as a lawyer. AHL
Gibson Dunn is proud of its longstanding relationship with Allergan and congratulates Donald Bunnin on this welldeserved recognition as a leader and innovator in healthcare. We are honored to work with you and applaud your commitment to helping people around the world live longer, healthier lives.
“Don epitomizes what every outside counsel hopes for in a client: he is exceptionally smart, creative, decisive, and an extraordinary leader and collaborator. We are proud of his accomplishments and honored to be part of his team.” —Lori McGroder, Partner, Shook, Hardy & Bacon L.L.P.

BY JEFF SILVER
Vincent Tammaro brings a patient-centered approach to finance at Yale New Haven Health
Finances and accounting are often viewed as dry, blackand-white, stringently objective pursuits. In a corporate setting, their practitioners are often characterized as the people who say no. But one of Vincent Tammaro’s mentors taught him several valuable lessons: One, financial matters aren’t always black and white. Two, it’s just as important to have solutions as it is to be able to identify the issues. And three, there is no cookie-cutter approach to most situations.
Tammaro has never forgotten those lessons and has applied them in a variety of ways as chief financial officer at Yale New Haven Health.
At a time when health plans have placed more and more responsibilities on patients for deductibles and copays, one of his major priorities has been bringing Yale New Haven’s patient-centered focus to the financial office’s interactions with patients and their families. To improve what he calls the “finance-patient experience,” Tammaro cites the implementation of the Epic electronic health information system, which was initiated in 2010 and substantially completed in 2013, as an important catalyst that has enabled his agenda. Epic has enabled the organization’s staff to do a great deal of front-end, proactive work to ensure patients understand what their insurance covers, as well as the financial and medical options that can enable them to plan more effectively and make fully informed decisions.
“By using the Epic system, we can be more proactive and gather the necessary clinical and insurance documentation before a procedure instead of trying to catch up after,” Tammaro explains. “We can alert patients ahead of time about what costs they’ll be responsible for so they’re not surprised. It improves our interactions and gets them more engaged. Our point of service collection has gone up dramatically, and our revenue cycle has improved overall.”
Recent industry trends have resulted in shifting a greater financial burden onto consumers, which has made the organization
Vincent Tammaro EVP, Chief Financial Officer
more sensitive to pricing. And because Yale New Haven Health is an academic medical center, its cost for services can be higher than some other facilities. With that in mind, Tammaro believes that, especially when patients have decided to go through with treatment at Yale New Haven Health, the organization’s proactive, patientcentered approach to finances is critical.
“If patients aren’t aware of the financial details up front and they have to have negative conversations with the business office, we run the risk of undoing a positive patient experience provided by our incredible clinical and operational teams,” he says. “As one of the last opportunities to influence the impression of patients and their families have of us, billing and finance is in a unique situation.”
To effectively leverage that opportunity, all of Yale New Haven Health’s 1,600 business office staff members were trained on the Epic system. That comprehensive instruction taught them how to understand and accommodate every patient’s story. That means responding to 3.5 million unique individuals each year. Staff members often have to determine if patients are eligible for certain charity resources that can help subsidize their care or free drug programs that the hospital works with to provide more than $5 million in medications annually.
In one pediatric instance, an insurer would not approve an expensive new drug. But the business office staff handling the case spent three days gathering documentation to build the case for the importance of that

specific treatment. Because of their extensive training and knowledge of how to coordinate with clinicians, they were able to change the insurer’s decision.
Tammaro begins his leadership and management meeting with patient stories as a reminder of the organization’s vision, mission, and values and how they directly impact patients and the clinical staff.
“Understanding core success factors from a statistical or numeric perspective is important, but I want to guard against our becoming numb to the numbers on a page,” Tammaro says. “Unless we’re patients ourselves, corporate services such as finance don’t typically have direct contact with the services we provide. But hearing about real outcomes with real patients reminds us of our purpose and why we all work here.”

Smarter business decisions.
Thousands of providers count on Experian Health and our revenue cycle management, identity management, patient engagement and care management solutions. Partnered together, we are leading the way for healthcare organizations and the patients they serve.

In one such example, a nineteen year old with an apparent neurological brain disorder and exhausted parents who had no other avenues to turn to for help landed them at one of Yale New Haven Health’s emergency departments. Although the hospital was not the appropriate setting for this treatment and would most likely never be able to recoup costs for the services it provided, clinicians and the business office committed to keeping the patient until the appropriate resources and social services could be arranged.
“This is a common situation for us,” Tammaro says. “We know the economics aren’t aligned, but it’s the right thing to do.”
To help balance the economics and to enable Yale New Haven to continue to provide such care, Tammaro is involved in numerous cost-saving and efficiency efforts. For years, his teams have led consolidation initiatives that have integrated finance departments throughout the system to bring about economies of scope and scale. This has also enabled consistent processes and performance system-wide in areas such as scheduling, billing, and collections.
As sources of funding and reimbursement continue to shift and evolve, Tammaro’s team reflects on the dynamic risk profile of the health system while overseeing Yale New Haven Health’s enterprise-wide risk assessment process. Each year, his team works with operations and clinical areas to identify inherent risks in the organization’s strategic plan; they then develop mitigation strategies. Yale New Haven Health also leverages the assessment to design its internal audit and compliance plan, which provides assurance over mitigation plans.
The finance team also works closely with operations, clinicians, and other corporate areas to streamline costs by identifying pricing advantages for supplier contracts, reducing overutilization of services, and looking for other opportunities and collaborations that can be tied in with the institution’s transition to value-based payer arrangements. As a result, they have successfully eliminated approximately $390 million in expenses—about 10 percent of Yale New Haven Health’s cost structure.
“My work has to be data-driven, but its value depends on what you do with the information and how you share it. ”
When he looks back on his first experience in healthcare—an internship at New Rochelle Hospital—Tammaro still feels the impact of seeing firsthand how important the facility was to the community. He remembers that and the lessons learned from his mentor on a daily basis.
“My work has to be data-driven, but its value depends on what you do with the information and how you share it,” he says. “Sometimes it’s actually not about the numbers at all, but the relationships and the people that make them meaningful.” AHL
3M Health Information Systems works with providers, payers, and government agencies to anticipate and navigate a changing healthcare landscape. 3M provides healthcare data aggregation, analysis, and strategic services that help clients move from volume to value-based healthcare, resulting in millions of dollars in savings, improved provider performance, and higher-quality care. 3M’s innovative software is designed to raise the bar for computer-assisted coding, clinical documentation improvement, performance monitoring, quality outcomes reporting, and terminology management. For more information, visit www.3M.com/his.
Smarter business decisions. A better bottom line. Stronger relationships with patients. That’s what more than 57 percent of US healthcare organizations experience using Experian Health’s industry-leading revenue cycle management, identity management, patient engagement, and care management solutions, powered by data and advanced analytics.


Tufts Health Plan is expanding services for its members through strategic partnerships
BY JOE DIXON
insurance can be quite confusing for consumers. Between HMOs, PPOs, and health savings accounts and premiums, copays, and deductibles, people can often feel overwhelmed by their choices. On top of that, individuals need to consider the quality of the services they’re getting for what they’re paying.
The team at Tufts Health Plan (THP) is aware of this delicate balance, which is why it has enacted several measures over the past few years to maximize patient care while minimizing costs for patients. One of the main strategies that the organization has used to combat rising healthcare costs while expanding services under its healthcare plans involves partnering with care providers throughout Massachusetts and Rhode Island.
Since 2015, under the leadership of Jim Agnew, the company has embarked on a series of collaborative relationships that have broadened care services for Tufts members in areas such as primary, behavioral, and dental health, and expanded services to Medicare and Medicaid populations. One of the first major partnerships for Tufts of the past few years began in July 2015 with Iora Health.
For the past three years, Tufts has worked with Iora to bring high-quality care to its Medicare patients in the greater Boston area. Under the agreement, Iora provides primary medical care for Tufts members on the company’s Medicare Preferred HMO and Senior Care Options plans. The partnership has not only been beneficial for both parties, but more importantly, it’s benefited patients.
“Iora Health’s innovative care model and increased access to care align perfectly with THP’s integrated care management model, which has been shown to improve our members’ health and wellness,” THP president of senior products Patty Blake said in a news release.
Tufts’s alliance with Iora kicked off a series of other partnerships, chief among them relationships with the State of Rhode Island and Delta Dental of Massachusetts.
In March 2017, Tufts began a partnership with Delta Dental of Massachusetts focused on better care coordination and disease prevention to reduce overall healthcare costs. “There are many studies which suggest that there is a link between oral health and chronic medical conditions,” Marc Spooner, THP president of commercial products, said in a news release. “This collaboration is unique in the marketplace and is another example of our commitment to finding innovative solutions to increase coordination with our providers while reducing costs for employers.” The joint venture will allow the two organizations to share information with each other and work to increase member engagement with their personal health plans. The relationship will benefit employers, as well. Companies with between 51 and 250 employees that purchase health plans that bundle THP and Delta Dental together are eligible for a premium discount.
Just a few months later, the company launched another important partnership. As of June 2017, THP has been collaborating with Rhode Island’s Executive Office of Health & Human Services to create a new
“We are very holistic in our approach to healthcare. We focus not on just physical, but also mental and behavioral, as well as social determinants of care.”

ConsejoSano is a digital health company focused on bridging the gap between Spanish speakers and the US health system. Our integrated services include:
• Multi-channel messaging
• Care navigation
• Data analytics
• 24/7 access to native-Spanish speaking medical navigators
Serving Medicaid and other populations, we help our clients to increase engagement, reduce unnecessary ER visits and produce better health outcomes for their Spanishspeaking customers, employees, and patients.
Lon Hecht
Vice President of Sales (732) 508-7231 lon.hecht@consejosano.com
www.consejosano.com


program called RITogether. The new initiative will allow the state’s Medicaid beneficiaries to utilize primary and behavioral healthcare through Tufts’s network of providers and services.
“We are very holistic in our approach [to healthcare],” Helene Forte, Tufts’s vice president of care management, told HealthPayerIntelligence.com. “We focus not on just physical, but also mental and behavioral, as well as social determinants of care.”
State officials have been quite enthusiastic about the partnership and the impact they feel Tufts will have on residents’ well-being in the state. “We are ecstatic that Rhode Islanders receiving Medicaid will now have another great option for administering their healthcare benefits,” Patrick Tigue, Rhode Island’s Medicaid director, told HealthPayerIntelligence.com. “Tufts Health Plan has an outstanding reputation, and we are happy they [are partnering] with us and [expanding] in our state.”
The goal of the program is to strengthen the relationship between care providers and patients and improve responsiveness to changes in patient health. The partnership aims to allow physicians to detect changes in patients’ health more quickly, which will let them adjust patients’ treatment plans accordingly.
your business transform uncertainty into possibility and rapid change into lasting progress. Learn more at www.deloitte.com/us/ healthplans
Based on the success of its current initiatives, it seems as though Tufts will continue to collaborate with its partners in healthcare to further its goal of improving patient care and minimizing costs to patients throughout Massachusetts and Rhode Island while looking for new relationships to forge. AHL
Deloitte Analytics - Smarter Insights. Stronger Outcomes. Achieving your organization’s objectives means building on vital capabilities and embracing new value propositions. Deloitte’s health plans specialists can help you use analytics to gain insight, capture value in Medicare and Medicaid, understand retail health, and transition to value-based care.
BY JOE DIXON
national debate surrounding healthcare costs continues to swirl, few have as informed a perspective on the evolution of healthcare as Dan Renick, president of Precision Value Group.
After graduating from pharmacy school at the University of Kentucky in 1994, Renick began working at a community pharmacy. Twenty-three years later, that work still has an impact on him today.
“When you’re on the front line of the prescription counter, it’s where reality hits as to what patients can afford,” Renick says. “I saw firsthand that patients would struggle to pay their out-of-pocket costs.”
The empathy for patients Renick cultivated as a pharmacist informs his work today. At Precision Value Group, Renick is responsible for helping clients understand the ever-changing prescription drug market and devising strategies to demonstrate a new drug’s value—always keeping patient well-being front and center.
The industry is quite different from Renick’s early days, when patients primarily paid cash for their medications. Now, most individuals rely on third parties such as insurance companies to help secure their prescriptions. Additionally, Renick says he is witnessing a push in the industry toward paying for prescription drugs based on value provided rather than traditional unit price-based reimbursement.
That change comes with its own challenges for manufacturers trying to achieve widespread usage of their medication, but Renick is prepared to help them navigate the changes.
Why do you think the prescription drug industry is shifting from paying for volume to paying for value?
Renick: The industry had a huge wave of innovation about twenty years ago, and a lot of great brands addressed a number of conditions, such as high cholesterol and high blood pressure. In the past 4–5 years, those drugs have become available as very low-cost generics. So now, drugs that follow them have to compete with these low-cost generics, and the bar has been raised to demonstrate that there’s value to moving to a more expensive, new brand.
The other thing that’s driving this shift is the fact that our ability to research and discover new compounds has expanded exponentially. That means a large surge of products are in the drug pipeline or have been recently approved, and they are coming to market at a time when our ability to pay is probably the most strained it’s ever been. So our technologyenabled R&D throughput is outpacing our ability to pay for medical innovations, especially under our outdated fee-forservice arrangements.
In this new era, how can companies demonstrate their drug’s value to the marketplace?
Renick: They need meaningful health economic data that’s relevant to a diverse group of stakeholders. One of the most straightforward data points I’m referring to would be event avoidance: did a drug result in fewer hospitalizations or fewer readmissions? Drug makers have to focus on altering these
types of events in a positive way because a payer—be that an insurance company, provider system, or patient—is going to think, “I might need to spend more money on a new drug, but if I offset my costs in other ways, my net gains will be positive and patient care will improve.”
There also needs to be a focus on other benefits, such as a reduction in caregiver burden. Another is an improvement in work productivity because an individual misses work less, or they’re a better worker when present.
One last thing that gets lost is the impact on future health considerations. For example, when we now cure people with hepatitis C (HCV), we lower infection rates in the future because those cured patients won’t transmit the virus to others. This also serves to increase the availability of liver transplants for non-HCV patients, which is critically important and of significant future value that needs to be accounted for when evaluating overall product value.
How can manufacturers gather this data in a cost-effective way?
Renick: It’s a real catch-22 right now. To get real-world data that can potentially be converted to meaningful evidence, you first need a drug to be utilized, so you need prescriptions to generate the data so that a drug can be assessed on actual outcomes. Since access is not easily granted and uptake can be hindered, we have a two-fold approach with our clients to address this.
First, within a clinical trial, we try to gather as much outcomes data as possible. I’ll use an easy example: In a trial of a drug that’s meant to lower blood pressure, the goal used to be just to lower blood pressure compared to a placebo or competing product. But that didn’t necessarily mean there was a reduction in actual clinical events, such as heart attacks or strokes. Companies have to focus on conducting clinical trials that allow them to gather as much outcomes data as possible, especially data that can be translated into various value endpoints that matter to payors. We can and do model the various impacts of these decisions to better inform the eventual study design because our clients need to bring drugs to market that have a reimbursable label rather than just an approved label.
Second, the best studies tend to have endpoints that matter to payers if they have clinical endpoints that can be translated into various value endpoints. These tend to be event avoidance, medical side-cost reductions, and the like. Even then, it might not be good enough for payers because it’s all based on clinical trial results versus real-world

observations. So, as quickly as possible, we support our clients in securing formulary coverage with payers that links back to the initial trial results but becomes predicated on future real-world results. This might take the form of risk-based contracting or some other type of contracting that will allow for some early utilization that can then be viewed through the lens of real-world evidence needs. Real-world evidence is key to understanding the value of positive outcomes in the postapproval treatment population. Some might refer to this as “coverage with evidence development,” and there are a host of ways we support this activity with our clients.
“Companies have to focus on conducting clinical trials that allow them to gather as much outcomes data as possible.”
There’s a national debate going on right now about healthcare in the United States. How does politics influence your work?
Renick: For basically a century now, about every ten years there is a big development in healthcare that tends to be tied to the White House, going back to the launch of Medicare and Medicaid in the sixties to the HMO Act of the seventies, with the latest being the ACA under the Obama administration. And we’re still waiting to see what we might get now—or not—with the current administration.
We were front and center when the ACA was launching about eight years ago. In that case, the big considerations were around coverage expansion, primarily to lower-income groups. The question becomes, within that population, “What are their most frequent diseases and conditions?” Our pharma clients have to decide if they’re going to focus a lot of attention on those new markets or if they aren’t. This means they have to evaluate their portfolio and determine, “Is this going to be a group that we want to place a lot of emphasis on?”
What have you learned throughout your career?
Renick: Collectively, what my experience has taught me is that all the different parties in the healthcare system want to do the right thing. Across the payer group, the pharma group, and the provider group, we all want to see patients get better and be healthier. We may have differences on how we evaluate what each party is doing and what we’re charging for various activities and products, but the good news is there is a collective, strong desire to elevate quality in healthcare and to improve patient outcomes. What’s so incredibly rewarding about the work we do on behalf of our clients is that the end result should be value realization for all parties, with the ultimate beneficiary being the patient. AHL



As the patient pool in the United States continues to diversify, it’s increasingly apparent that care providers need a staff that reflects the patients they serve. These four executives demonstrate that the ability for healthcare providers to tap into different perspectives is critical for increasing quality of care.

Maurice Sholas uses empathy as a weapon against racial bias in the workplace and beyond
By

Despite his many accomplishments, driving his car can be an intimidating experience for Maurice Sholas because of the color of his skin, he says.
“I am an MD-PhD from Harvard with a senior leadership position at a major organization, yet I’ve been stopped by police every time I’ve gone into the suburbs around Minneapolis,” Sholas says. “Not sometimes. Every single time.”
Sholas, the senior medical director of rehab services at Children’s Hospitals and Clinics of Minnesota, has frequently experienced racial bias throughout his medical career and personal life, and he’s made it his mission to cure these biases and transform society’s perception of black men in the medical world and beyond.
Sholas says that empathy, not technical knowledge, is the most critical skill he needs in order to deliver the highest-quality care he can to his patients. Every patient he sees brings a different set of values, experiences, and beliefs with them that Sholas needs to take into account when administering care.
“Two different patients can have the same injury. They can both have some of the same deficits, but the construct and how they make sense out of it is influenced by how they see the world, what their construct of illness is, and what their religious background is,” Sholas says. “All of that goes into it.”
About 20 percent of Sholas’s job involves caring for children with congenital or
acquired physical disabilities, but it took him a while to find the specialty that resonated with him. His medical school rotations in cardiology, obstetrics and gynecology, and orthopedics left him wondering why so many of his peers had found their calling while he was feeling apathetic. Always an academic at heart, Sholas picked up a book that detailed dozens of medical specialties to find an answer; he found rehab medicine.
After that discovery, Sholas scheduled an elective in his last year of clinical training to work on a spinal cord-injury unit. He immediately knew that he had found his passion. “I connected with them as people, I connected with them as survivors, and I connected with them as they navigated life after a setback,” Sholas says. “It was wonderful.”
In addition to clinical work, the bulk of Sholas’s job requires him to collaborate with executive leaders across the Children’s Hospitals and Clinics of Minnesota system to incorporate pediatric rehabilitation programs into their hospitals’ and clinics’ services. Often, the executives he speaks with have no experience managing this type of care, which means Sholas has to lay out every step of the process for them, including financial customer service and customer care targets, among other aspects.
Despite his measured approach with patients and colleagues, the empathy Sholas shows the people in his clinic hasn’t always been extended to him professionally




The light that came on in that boy’s eyes when he saw it was possible that someone who looked like him could be a doctor made me so proud I cried. That gave me fuel to just slay a thousand more dragons.”
or personally. One example of implicit bias has stayed with Sholas ever since he experienced it.
Several years ago, he was having a meeting with a former colleague to discuss strategies for an upcoming project. They disagreed about different elements of the plan and began debating the merits and flaws of each other’s ideas. Neither person was yelling or cursing at the other, but as time went on, instead of continuing to debate Sholas, his colleague told him, “I’m afraid.”
“In this setting, what is happening that would make her feel afraid?” Sholas says. “It was very offensive to me because to me because it was so ridiculously out of context.”
The best way to foster empathy among others who are different from you— whatever those differences might be—is exposure, Sholas says. He finds that informal settings, such as having lunch or getting together with someone outside of work, is the best way to become closer with colleagues. It also helps eradicate biases or preconceived notions his coworkers might have about him based on his race or appearance. For Sholas, often this means talking about sports.
“I’m a huge New Orleans Saints fan. I’m a huge San Antonio Spurs fan,” Sholas says.
“Sports motivate me to do all kinds of stuff and spend all kinds of money. You can’t understand me if you don’t understand I love sports.”
Moments like the one he experienced with his former colleague are wearisome, but Sholas makes sure to surround himself with people who help keep him energized and in good spirits. Mentoring and setting a positive example for children is another way he tries to maintain a positive outlook. He takes the time to mentor family members, and friends have also connected him to individuals who they thought might benefit from Sholas’s guidance. But he takes advantage of spontaneous moments to make an impact, as well.
One day, while looking out a window at the garden on the hospital’s grounds, Sholas noticed a young Somali boy looking at him, accompanied by his mother and sister. He waved at the boy, who looked away. The boy looked back. Sholas waved again. The boy asked him, “Are you a hospital doctor?” Sholas replied, “Yes, I am.”
“The light that came on in that boy’s eyes when he saw it was possible that someone who looked like him could be a doctor made me so proud I cried,” Sholas says. “That gave me fuel to just slay a thousand more dragons.” AHL
Maurice Sholas doesn’t confine his wisdom to the hospital. He is always happy to give advice to young professionals and students who aren’t sure about their futures. Two people in particular have made a long-lasting impact on him.
One of his mentees shadowed him for a summer while she was still in high school while he was an attending physician in New Orleans. Since then, she has gone on to graduate college and medical school, and she now practices as a general surgeon.
He met another of his mentees, DJ, through a friend who was looking to connect teenagers with positive role models. Now, DJ plays nickel back for the Prairie View A&M University Panthers football team. He is in his senior year and has plans to attend physical therapy school after graduation. But his mentee relationships aren’t one-sided; Sholas learns from them as well. “DJ taught me how to use Snapchat, as well as the value of balance in my life,” Sholas says.
















It's not what it is... it's what it does. Most companies dispensed braces and we strive to achieve the outcome.

















WE USE INNOVATIVE CUSTOM ORTHOSES TO TREAT
TOE WALKING | DOWN SYNDROME
ONCOLOGY | BRACHYCEPHALY & PLAGIOCEPHALY PRONATION | CEREBRAL PALSY | FRACTURES
WE BELIEVE IN &
We are driven by innovation that improves the lives of children
We always put our patients first and we guarantee our results
We always work with the care team in order to help our patients reach co-created goals
How Avella’s general counsel, chief compliance officer, and executive vice president of administration approached the company’s relocation and acquisition
By Galen Beebe
There are two main ways to expand a company,” says Avella Specialty Pharmacy’s Abby Kaplan. “You can do it organically, or you can do it through acquisition.” In 2016, Avella did both.
In November 2016, Avella relocated its corporate headquarters to a new, fiftythousand-square-foot location in Phoenix, which will also house a mail-order pharmacy and compounding facility. The new facility is geographically close to the former headquarters, and it also presents significant opportunities for the quickly growing company.
“Part of the growth of Avella has been a result of our expanding capabilities in the compounding space,” says Kaplan, the organization’s general counsel, chief compliance officer, and executive vice president of administration. In 2016, Avella compounded 17 percent more prescriptions and served 43 percent more patients than the previous year. By moving into a larger facility with nearly three times the clean room space, Avella will be able to expand its compounding practice for doctors’ offices and hospitals, while continuing to compound for individual patients at its other facilities, she says.
The new headquarters previously housed a medical device manufacturer. Although the building had clean room and office space, it required upgrades to fit Avella’s needs and adhere to government regulations. “We
redesigned the clean room space to make sure that it would provide for an environment that is consistent with what the FDA requires for registered outsourcing facilities,” Kaplan explains. She worked with Avella’s executive vice president of operations and executive vice president of clinical affairs and quality assurance, among others, on the clean room and office setup to help ensure that the company hired the appropriate vendors to adhere to FDA regulations. “It was really a team effort,” she says.
Kaplan’s compliance team focused on securing the necessary licenses and contracts. “Our strategy has been to start fresh,” she says. As a nonresident pharmacy and outsourcing facility, Avella must attain licenses for each state where they ship products: fifty licenses for the pharmacy and fifty for the FDAregistered outsourcing facility. Rather than transferring existing licenses, Kaplan’s team is acquiring new licenses for the new space and relocating employees as they obtain the necessary paperwork. Avella relocated the corporate functions in November 2016, and plans to have completed the operations transition by the end of 2017.
Along with moving headquarters, Avella acquired two companies in 2016: Advanced Pharma, now Avella of Houston, and Oncology Plus, now Avella of Tampa. The latter compounds patient-specific
oncology products at its five-thousandsquare-foot facility, expanding Avella’s compounding capabilities in the oncology realm. And Avella of Houston is a thirtyfive-thousand-square-foot, 503B-registered outsourcing facility that compounds products for hospitals, health systems, and ambulatory surgery centers across the country. Combined with Avella’s new Phoenix location, the company will soon have the capacity to compound more than twenty-two thousand prescriptions per day.
Housing the corporate functions and some of the compounding operations under one roof will increase efficiency and provide additional office space for the company’s growing corporate teams. Before Kaplan joined Avella in 2015, the company outsourced its legal work and maintained just one full-time employee across the legal and compliance departments. “When I came in as the general counsel, the effort was made to centralize legal work in-house where we could and make sure that we had as much oversight as possible,” Kaplan says. Now, Kaplan has four reports across legal and compliance, plus two legal interns.
In addition to managing the legal team, Kaplan oversees the compliance department, where she ensures that the proper procedures are documented and updated regularly and that employees are trained appropriately. Her
team’s director of compliance and regulatory affairs conducts audits in conjunction with the clinical and quality department to ensure that all employees and consultants are following the processes, and the human resources department, also managed by Kaplan, retrains or remediates as needed. “My role is not to be an operator,” Kaplan explains. “It’s providing support for the operators throughout the company to make sure that we’re all protected in our day-to-day activities.”

We started the Women in Healthcare Network in response to some of our customers who were women working in healthcare who were feeling like they really didn’t have an outlet to communicate and share common ground with other women in leadership positions at such organizations.”
As well as growing her team, Kaplan has expanded her reach beyond the office. In 2015, she helped launch the Women in Healthcare Network together with Avella CEO Rebecca Shanahan and several other women at the company. The network aims to create a space for female healthcare professionals to discuss issues and opportunities in the field. “We started it in response to some of our customers who were women working in healthcare who were feeling like they really didn’t have an outlet to communicate and share common ground with other women in leadership positions at similar organizations,” Kaplan says.
Although 78 percent of healthcare professionals are women, according to the Bureau of Labor Statistics, women are drastically underrepresented among healthcare executives. As a company with a female CEO, Avella is in the minority; but according to Kaplan, gender is not a focus in the company. “I’m fortunate to be in an environment where I don’t have to worry about it,” she says. “I don’t need to do anything other than perform well.”
The approach comes from the top. “Shanahan really inspires everyone,” Kaplan says. “She’s really an advocate for the leadership team and for all the employees here. It’s nice to see somebody like her in that role from a mentorship perspective.”
The Women in Healthcare Network gathers every few months for a combination of formal and informal professional development programming. The response has been positive, and the group has gained a following among female healthcare professionals. “The goal,” Kaplan says, “is to create an avenue where people can have informal conversations about anything that they need to discuss as it relates to their role or finding the right fit for themselves in their organization.” AHL
We get it. You want legal advice that’s clear, timely and practical.
We can help. As one of the few law firms in the country with multiple attorneys who are registered pharmacists or healthcare practitioners, we understand your needs. We have handled matters in all 50 states, and we are experienced in dealing with state boards and offices as well as federal agencies, including the FDA, CMS, DEA, OIG, FTC, EPA and DOJ.
We’re versatile. Our clients range from small pharmacies to wholesalers, and from benefits managers to compliance officers. We’re innovative and responsive, and we focus on your success.
Let’s talk.

bakerlaw.com

Our healthcare attorneys have extensive experience assisting Specialty Pharmacies, Hospital-Owned Pharmacies, Pharmaceutical Manufacturers, Wholesalers, Investors, and National Healthcare Organizations in navigating complex and diverse legal issues, and are able to provide counsel on the issues impacting your business. Contact Frier Levitt today. Frier Levitt is a national boutique healthcare law firm, providing comprehensive regulatory, transactional and litigation advice to the Healthcare and Life Sciences industries.

By Galen Beebe | Photos by Kristin Deitrich
In 1999, the CFO of a Miami-based health system called Barbara Ronda into his office. Ronda had recently become the director of managed care contracting, and the CFO had just found out. “He didn’t take to that lightly,” Ronda says. Although she had been offered and accepted the position, the CFO suggested that a “provider relations role was more appropriate for a woman.”
When Ronda refused to change roles, the CFO told her she would have three months to achieve a long list of unattainable goals. “I accepted, knowing full well the goals that he was giving me were unacceptable,” Ronda says. “I went back to the person that hired me and said, ‘We need to call in every single one of our relationships because we have to make this happen.’”
This challenge pivoted Ronda’s career. A month into the three-month deal, the CFO called Ronda back into his office, tore up the contract, and promoted her. In addition, he created a training program to prepare her for a senior leadership position. “Frankly, it was that training and that opportunity that he gave me that really allowed me to distinguish myself early on in my career,” Ronda says. “I used that moment as a platform to improve rather than to falter on.”
Now, Ronda is associate vice president and chief administrative officer at UHealth-University of Miami Health System and the University of Miami Miller School of Medicine. In 2016, she joined the inaugural class of the Carol Emmott fellowship, a yearlong healthcare administration fellowship that aims to transform midlevel career women’s weaknesses into strengths.
The fellowship has four goals: expanding knowledge and experience, creating constructive change in the fellows’ communities, increasing opportunities for further leadership roles, and building a network of health leaders. Through trainings in subjects such as public speaking and creating a personal brand, fellows gain practical skills that prepare them for senior positions.
The fellowship also focuses on overcoming self-defined barriers, such as balancing parenting and career obligations. “What the fellowship teaches us in that regard is to get out there, balance it, and own it,” Ronda says. “Own walking away to go take care of something for your child and then come back and continue your responsibilities.”
This is a familiar landscape for Ronda, who has two children and two stepchildren, all college-aged. “There was
always an event, there was always a show, there was always a meeting or a presentation or an awards ceremony, and there were competing priorities at work,” Ronda says. “Success required understanding that both of my roles as parent and an employee in general required top priority.” That also meant continuing work after her children’s events or bedtimes. “There are moments that are harder than others, but it can be done,” she says.
In the fellowship, Ronda is paired with a female mentor who supports her in applying theory to practice. Most of Ronda’s previous mentors were men—“men who understood what my strengths and weaknesses were, and men who were willing to invest in me to help me propel forward,” she says. But many men, she adds, are unaware of the issues women face and their widespread implications. “If they were more keen to the statistics, on more occasions than not today’s male executives or mentors would be willing to contribute to the solution rather than to continue to propagate the problem,” she says.
The statistics are striking. While women make up a substantial majority of the healthcare workforce, they are considerably underrepresented in senior management roles, according to the Carol Emmott Fellowship website and the Bureau of Labor Statistics 2016 report. In addition, women are often paid less for the same role. “This isn’t just that we’re bad negotiators,” Ronda says. “We’re treated differently.” While the numbers aren’t encouraging, they are helpful. “If you’re able to identify the numbers more precisely, I think that’s the best way to increase awareness and to start to chip away at the problem,” Ronda explains.
To address gender disparities within her own organization, Ronda has developed a mentorship program and organized a number of symposia for young women in the University of Miami community. The goal is to give them a platform to speak and understand, and to create a formal networking opportunity for them. She also secured a staff member who addresses women’s issues in the office of diversity and introduced blind résumé review, removing any gender, age, race, or other personal descriptors from a candidate’s résumé. Reviewers then are focused exclusively on work experience, educational background, and publications. “This way, you’re really comparing apples to apples when you’re looking at competing candidates,” Ronda says.
Although Ronda always pushed to advance her own career, she didn’t grow up thinking of herself as a feminist. “I was actually told the other day that I was raised like a man,” she says. “I think it helped complement my frame of reference as a woman.” Ronda’s parents taught her to face adversity head-on. “To me, it was just matter of fact,” she says. “You just get up, shake yourself off, and move on—and you prove them wrong.”
“If you’re able to identify the numbers more precisely, I think that’s the best way to increase awareness and to start to chip away at the problem.”




As well as advancing gender equality, Ronda looks toward the future in healthcare politics. “Miami is a very parochial city, and understanding who the movers and shakers are and how to advance a mission is more than a science,” she explains. “The fabric of this community is so intertwined; it’s multinational, multigenerational, and has a number of socioeconomic influences that don’t fit any national mold.” A large part of Ronda’s role is anticipating the national landscape challenges and changes and applying that to the transformation of the organization.
The political, healthcare, and equality landscapes all intersect, Ronda says—both on an organizational and personal scale. “Any new perspective that I’m fed, that I understand and can connect with, makes me all the more valuable in my professional role, as a parent, as a member of my community, and as a mentor,” she says.
There’s always innovation when working at a university. “That constant churning of knowledge and growth and being at the forefront of change is invigorating,” Ronda says. “To make long-term changes stick, we need to ensure that we have a platform that’s constantly churning and growing with the organization and that will address the growing and evolving needs of women and men.”









Abigail Epane-Osuala’s well-traveled childhood built the foundation for her work advocating for inclusion at Integra LifeSciences
By Galen Beebe
Every other summer of her childhood, Abigail Epane-Osuala left her home in Douala, Cameroon, to visit her grandparents in the town of Likomba. Her grandparents were farmers and merchants, and every Tuesday, she accompanied them to the local marketplace to sell goods from their store. She carried her grandmother’s canned tomatoes around the marketplace on a tray, negotiating prices and convincing potential buyers that these tomatoes were, in fact, the best. “It was always the more seasoned people buying stuff from me because I would talk to them and engage them,” she says. “You need to be connected to people for people to feel connected to you.”
As vice president, human resources, specialty surgical solutions (SSS), at Integra LifeSciences, a global medical technology company, Epane-Osuala uses this philosophy of connection to advocate for an inclusive, diverse workplace within the SSS division.
When leading global teams, Epane-Osuala engages her team members in decision making, recognizing their concerns and incorporating their feedback. In February 2017, Integra announced its plan to acquire the Johnson & Johnson Codman Neurosurgery business—a plan that requires the company to integrate Codman employees from sixty-eight countries. In leading the HR work stream for this integration, Epane-Osuala’s first step was to bring Integra’s global HR leaders together to gather input on how she could best support them through the process. “It’s not just about giving directives to people,” she explains. “Even though at the end of the day, the final accountability for leading the HR work stream rests on me, and just allowing folks to be part of the process, to opine on it and give their input, goes a long way and really makes the team effective for a smooth execution.”
When she wasn’t visiting her grandparents, EpaneOsuala spent summers traveling the world with her parents, meeting new friends in each country she visited. Her wide
travels as a young woman gives her a cultural and linguistic understanding of the perspectives held by her current and prospective colleagues. “When you’re working with teams around the world, you need to understand the different cultures. You need to allow for those different nuances not to be a barrier to the way you work,” she says. “When people understand that you appreciate their culture, they’re more open to you.”
In order to gain the trust of her multilingual colleagues who are spread across the globe, many of whom she has never met in person, Epane-Osuala emphasizes flexibility. When meeting with a team from France, she typically speaks French—one of the six languages she knows. “Using their native language makes them feel comfortable,” Epane-Osuala

Abigail Epane-Osuala VP, Human Resources, Specialty Surgical Solutions Integra LifeSciences
“You need to be connected to people for people to feel connected to you.”
Abigail Epane-Osuala is currently coauthoring a book on practical leadership advice, including her favorite piece of advice: feedback is a gift, and you can either accept it or throw it away. “Everyone has a perception of you. Sometimes this perception is negative and may not equate to your own perception,” she says. “But, before you jump on it, overreact, get depressed, or let it define who you are, my advice is to pause, think about it, and pick the feedback that works best for you.”
explains. “They become very receptive to getting stuff done. They know that I understand what they’re doing or saying.”
She applies this same flexibility to scheduling meetings and events, ensuring that she considers not only what time zones are convenient for those in the Americas, but what will work for those around the globe.
Epane-Osuala encourages different perspectives within the SSS division at Integra as well. When hiring, she ensures that each slate of candidates is diverse, both in terms of essential qualities such as nationality or gender, as well as in skills and experience. “I’m not saying that I have to hire diverse candidates, but I’m saying let’s give folks an opportunity,” she says. “I always say I’m blessed because someone gave me the opportunity.”
Hiring diverse candidates is especially important at the leadership level. “The leaders shape the organization,” EpaneOsuala says, so demonstrating inclusion at the highest levels of leadership creates a model for the rest of the organization. Diverse leaders are more likely to hire diverse candidates, Epane-Osuala says, and representing different perspectives encourages different approaches to solving problems. Leaders from all backgrounds can serve as valuable allies and stress the importance of diversity within the organization. “It starts at the top,” Epane-Osuala says. “When you don’t have leadership advocating for diversity, you will be unable to sustain it.”
Epane-Osuala has focused not only on increasing the number of women who are hired to work at the SSS division, but also on improving the company’s ability to retain these colleagues. She creates opportunities for people to see and feel the impact of inclusion. For example, every year at the division’s national sales meeting, she hosts a Women of Sales Luncheon. At this year’s event, she was able to recognize that half of the top sales performers were women, which was significantly more than the previous year. Putting a spotlight on this success allows colleagues to see a pathway to accomplishing their own goals. “Making sure that the organization knows that you’re paying attention to inclusion will drive that culture,” she explains.
Epane-Osuala further highlights diversity by supporting employees in creating affinity groups. The SSS Women of Sales network gives women a space to discuss issues they face and provides resources for one another. And when EpaneOsuala was approached by a group of African American
employees about celebrating African American history month, she supported them in creating an annual celebration in February by inviting speakers and ensuring the CEO, CHRO, and senior leaders attended the events. “I don’t have to be African American to understand that these employees want to do something that celebrates their heritage,” she says. “Acknowledging something that they value, which is their culture, makes them want to stay at Integra and makes them want to work harder for Integra.”
For Epane-Osuala, the support of her family, peers, and leaders—particularly her CHRO—are fundamental to her success. “To become a successful leader, you can’t do it by yourself,” she says. “While I have always raised my hand and seized opportunities, I would not have gotten to where I am if someone did not take a chance and give me the opportunity.” AHL
At Mercer, we’re helping clients solve some of today’s most important challenges, like reducing healthcare costs and improving quality of care, managing pension risks and enhancing financial wellness, addressing the needs of a multigenerational workforce, and overcoming global talent shortages.
We’re helping companies help their employees live healthier lives, grow their careers, and build more secure futures. It’s not just the right thing to do; it’s the smart thing to do. Because thriving employees power thriving businesses.
www.mercer.com
Our world is changing. Changing how we live and work. How we make decisions today. How we plan for our future.
At Mercer, creating a brighter tomorrow is at the heart of our business. Our 21,000 colleagues are helping more than 110 million people worldwide achieve their health, wealth and career goals. It’s how we make a difference. It’s how we make tomorrow, today.

www.mercer.com
“No matter how tough the day was,
I know we have done
Life something pretty special around the world.” p. 118
BY JOSEPH KAY
Assistant general counsel Ruchika Kumar’s strong ethical upbringing prepared her well for her mission-driven work at Genentech

In Ruchika Kumar’s family, the legal pedigree is as strong as the moral one.
When she was eighteen, Kumar, who grew up in India, took the written test to get her driver’s license. She passed. But her father forbade her from bribing the local bureaucrat, who refused to issue the license without one. She took the test again, and passed, but her father still insisted that they would not contribute to the corruption endemic to the local government. Kumar finally received her driver’s license—without a bribe—on the fourth attempt.
That outlook continues to support Kumar’s approach at Genentech, where she serves as assistant general counsel. She positions herself as a trusted advisor to the business she works for, providing solutions and guidance in support of the patient, the law, and the partners.
The organization is particularly interested in unmet medical needs, those conditions and communities for which effective treatments are few. It’s that patient interest that drives its business, she says, and she can sense the mission in every meeting. “Even when you’re advising on legal issues, the patient interest is always kept in mind,” Kumar explains. She is continually inspired by the company’s mission, which also includes giving back to the community in the Bay Area.
Kumar took a roundabout course to her current position.
After earning her LLB in India, she was eager to broaden her perspective with education in the United States. She applied to the University of Pennsylvania but only let her parents know when she was accepted.
With a great deal of help from her family and community, Kumar left India to further her studies; following that, she served as a one-woman legal department at a number of tech start-ups. Thirteen years ago, she closed that chapter to have her first child, but within a few short months, missed the stimulation and camaraderie of the legal profession.
Returning to work at Genentech, Kumar was excited by the opportunity to learn new territories of the legal business. Over the past twelve years, growing within a large, complex organization, she’s also been able provide some guidance to her colleagues.
“I made a nontraditional switch within Genentech, and through that I learned new areas of the business and acquired new tech skills,” Kumar explains. She’s been conducting training sessions on those skills to help her colleagues grow, and serves as a mentor to a number of her associates.
Besides the contributions she’s made to others, mentoring has helped Kumar reveal and develop herself as a leader. “Not to make stereotypes or generalizations, but culturally, we are told in India not to show off or talk about our achievements,” she says. “I used to always struggle. I didn’t know how to be gracious enough to take a compliment and say thank you; I thought it meant that I was showing off.”
But Kumar has noticed those tendencies among many of her colleagues, regardless of their background. She reminds others to take stock of their own positive qualities, and encourages mentors to provide that mirror for their mentees. Kumar recalls that her own performance reviews remarked upon her unacknowledged persuasive influence—that she could substantially guide a colleague or a conversation with little recognition of her own presence. Thanks to that eventual recognition, she has learned to wield that influence with confidence and responsibility. “That confidence does translate into how you lead,” she says. “A lot of people don’t realize the qualities they have; what you’re helping them do, you also have to realize about yourself.”
Kumar made a key realization about herself just two years ago, when Genentech distributed a document detailing five pillars of well-being: physical, financial, social, career, and community. With her children a little older and her career
“The causes that resonate with me are the ones that involve communities and initiatives to make themselves self-reliant.”
stabilizing, Kumar discovered that she had the opportunity to make a significant investment in that final category. She resolved to develop strong, intentional, mission-based relationships with her community and with relevant service organizations.
First, she crafted a sort of mission statement. “The causes that resonate with me are the ones that involve communities and initiatives to make themselves self-reliant,” she says. “The collateral benefits are the uplifting of an entire community: individuals lead a life of dignity; women are empowered; children have opportunities for education.” The effects resonate across generations.
To that end, Kumar got involved with Working Solutions, a Bay Area nonprofit which provides microloans to local entrepreneurs, particularly women and minorities, who have difficulty accessing credit. “A lot of these people get refused by banks. We also provide them business advice and financial advice,” she says. Kumar now serves on the advisory board. She also works with her own neighborhood association to build connections and community close to home. Kumar notes that the distance between their houses, modest as it may be in absolute terms, creates real barriers that can be surprisingly difficult to overcome.
Kumar also takes her family to volunteer at the food bank to ensure that her family’s legacy of service will be as strong in the United States as in India.
“Not having grown up in this country, it always comes as a shock that even in a resource-rich country such as the United States there are those who are hungry, those who don’t have access to schools,” she says. “Now, slowly, I’m getting involved and seeing where I can do this work.” AHL
Covington commends Ruchika
of Genentech for her innovative leadership and professional dedication.
BY LORI FREDRICKSON
After time away, Pauline Fox returned to The Permanente Federation with a fresh perspective and renewed dedication
When Pauline Fox decided to retire in 2012 after thirty-five years in law (including fourteen years as the general counsel for The Permanente Federation), she zealously approached her new freedom. Before retirement, she had worked nonstop while also raising a family of four children; after, she climbed Mount Kilimanjaro with her two daughters, and took classes in painting, ceramics, photography, paleontology, crocheting, and horseback riding. She became certified in scuba diving, volunteered at an animal rescue foundation, and served on the board of a disability rights advocacy organization. Most satisfyingly, she spent autumns in Saratoga Springs, New York, cheering on her daughter at every game of the Skidmore College women’s soccer team.
So when a former colleague from The Permanente Federation called Fox in early 2016 to ask if she’d be interested in returning to her old position, she didn’t exactly jump at the opportunity. “Are you crazy?” she remembers responding. “I’m enjoying my retirement, thank you very much.” But the colleague, whom Fox had selected as her replacement when she stepped
down, was insistent: she was taking on a new position in Colorado, and The Permanente Federation was also in the middle of a major reorganization. They needed someone with Fox’s experience, someone who could hit the ground running. They needed someone, even if only temporarily, to train someone new.
And so Fox agreed to come back for three months—but it took her only about two weeks to realize that she wanted to return full-time. (In April 2016, Fox was appointed executive vice president, chief legal officer.)
“I was still having fun at my job,” Fox says. “I came back ready to roll, way more energetic about the work. It taught me the value of getting away and doing something else with your brain for a substantial period of time.”
Fox’s earlier years at The Permanente Federation had been focused on substantial ground building. Having previously worked in commercial litigation for nearly twenty years for Pillsbury, Madison & Sutro, she’d moved into healthcare with a role at Kaiser Foundation Health Plan. She joined Permanente Federation shortly after it was created in 1997 to represent the national interests of the Permanente Medical Groups, partnering with Kaiser Foundation

Health Plan and Hospitals. Owing to the long history and breadth of Kaiser Permanente—which has grown to become the largest managed healthcare organization in the United States—her new role required juggling responsibilities across member groups with varied cultures and histories.
“When I first joined, I was the sole in-house lawyer for ten medical groups,” Fox says. And though Kaiser Foundation Health Plan and Hospitals have since become increasingly nationalized, at that time each group had grown up in an era of regional autonomy, with separate and distinct cultures. To her, it was important to respect these disparate cultures and not eliminate all of the differences to make them like one larger medical group. “There is innovation that comes out of being different, and the trick is to figure out what variation should be eliminated, and what variation should be respected,” Fox says.
To do this, she built legal functions at each medical group and provided support for different boards of directors by highlighting the areas they focused on to see if they wanted to move in different directions. She also focused on putting together resources and manpower where it was lacking, and built an affiliation between their northern California and mid-Atlantic medical groups, both of which have since thrived.
Fox also did all of this while comanaging a few significant lawsuits that came at the tail end of managed-care litigation, one of which Permanente won at trial and one that was settled favorably, in addition to a wide variety of other legal issues. “I did pretty much whatever came in the door,” Fox says, including tax issues, securities issues, and
human resources issues. Here, her previous experience in litigation gave her expertise across a broad array of legal topics. “My earlier career really prepared me to be a general counsel of a company,” Fox says. “That’s one of the reasons I love this job: no two days are ever the same.”
Returning to The Permanente Federation, Fox tackled her old responsibilities and took on new ones, as well. One addition was the company’s reorganization plan, which involved building a new structure where leaders of the medical groups assumed leadership roles in functional areas of the organization, such as IT. To assist them, Fox provides legal services and runs interference in various areas. She’s also working with Kaiser Permanente on its plans to open a new medical school, with programming that emphasizes practicing in a communityfocused way as well as working with new technology, ensuring that it will have autonomy through bylaws, contracts, and structure. “What we hope it will do is look at medical education in a different way, emphasizing it in these days as a team sport,” Fox says.
For nine months, she also took on a second position at the company as a fill-in for the general counsel of the Colorado Permanente Medical Group, which involved everything from governance to rewriting its staff manual. While working two jobs was a personal grind, Fox says, it was professionally satisfying. “The work needed to be done,” she says. “And it was done in a way that moved the medical group forward.”
In addition to all this, Fox returned from retirement with a passion for teaching. “I have lived through this enterprise’s
“That’s one of the reasons I love this job: no two days are ever the same.”

Holland & Hart is proud to celebrate our friend and client, Pauline Fox, for her ongoing contributions to the success of The Permanente Federation.
Brian Mumaugh, Partner 303.290.1067
bmumaugh@hollandhart.com
6380 South Fiddlers Green Circle, Suite 500 Greenwood Village, CO 80111
ups and downs, and to be effective in leadership, you have to understand where this company has been,” Fox says. She’s created two programs—KP 101 and KP 102—and teaches at Medicine in Management (a program designed to develop Permanente physicians’ leadership and management skills). The course she teaches focuses on Kaiser Permanente’s rich history and the importance of building resolutions and working out disagreements.
Having returned to the company after what she now sees as a valuable sabbatical, Fox is able to appreciate it from a fresh perspective. “It’s fun to work with the group of people who were there then and who are here now,” Fox says. “This is a group of people who are dedicated to providing the best service that we can. It is fascinating to see how that works as a lawyer, and gratifying to help those who are helping people.” AHL
Hooper, Lundy & Bookman, P.C. congratulates Ms. Fox and is proud of our association with The Permanente Federation. With offices in California, Massachusetts, and Washington, DC, Hooper, Lundy & Bookman is the largest law firm in the country dedicated exclusively to the representation of healthcare providers and suppliers.
Holland & Hart LLP was privileged to partner with Pauline Fox in support of her vision for the delivery of the highestquality legal services to The Permanente Federation and the Colorado Permanente Medical Group. Ms. Fox’s passion for her work and dedication to the people she serves inspires innovation and creativity, with the goal of ensuring that her clients are successful in delivering high-quality, integrated care to the patients and members of Kaiser Permanente.
BY PORCSHE N. MORAN
From secretary’s assistant to top executive, Tina Graham has spent nearly thirty years working her way up in the world of healthcare. The chief operating officer of Alabama-based Guideway Care has no plans to slow down as she takes on a new challenge to transform the cancer care system.
When Tina Graham started running, a friend gave her some sage guidance to overcome the physical struggles of getting into shape. “She said to just make sure that the last mile is faster than the first mile,” Graham says. “You don’t want to slow down. You want to get faster and better. You want to keep moving forward.”
That advice is a theme that has tracked through Graham’s personal and professional journey. Her first mile was her humble childhood in a small town in rural Alabama. After high school, she moved by herself to Birmingham, the largest city in the state. There, she started working to buy her first car and to pay for tuition at a technical college. The college set her up with a job placement at Southeast Health Plan, a local HMO, where she served as an assistant to a secretary. This proved to be a pivotal point in her life and prepared her for future success.
“I entered my career at the lowest place you can start,” she says. “I was nineteen years old. I started out doing administrative things in the information systems department, but I had a manager who really invested in me. She had me develop training materials for the software and test software changes, and gave me opportunities to expand my writing and presenting skills.”
Not long after, Graham sprinted to a promotion to quality assurance coordinator at Southeast Health Plan. She stayed in
the role for four years before she went on to spend five years as the quality assurance manager for MACESS, a business process and enterprise content management software for the insurance industry. Next, Graham worked her way up to become the chief operating officer (COO) of SuccessEHS—a vendor of EHRs, practice management solutions, and integrated medical billing services— for fourteen years. When SuccessEHS became part of Greenway Health in 2013, the company named Graham the senior vice president of revenue services.
Today, Graham has hit her stride as the COO of Guideway Care, a Birminghambased start-up firm that was founded in 2016 to provide cancer patients with nonclinical services and help them navigate every step of the treatment and recovery process.
“Working at Guideway Care is one of the most exciting things I’ve ever been able to do in my career,” Graham says. “This company has such a great purpose. We are doing something that improves patient care and population health while making healthcare more affordable for everyone in the system.”
Guideway Care hires and trains specialists, known as care guides, for cancer clinics. These experts offer cancer patients emotional support and education about their disease and treatment, as well as assist patients in eliminating barriers to care and in connecting

“Part of what excites me about anything I do is finding a way to do it better.”
them to community resources. The goal is to create a high-quality experience for patients, families, and providers.
“When a cancer patient is in the clinic, they have a lot of support,” Graham says. “But when they leave, they are taking care of themselves. Our care guides engage with patients between clinical visits. They help them deal with issues that go beyond their immediate health concerns.”
A state-of-the-art solution includes care maps, guidance protocols, and a technology platform developed and tested by the University of Alabama at Birmingham (UAB) Health System Cancer Community Network—all of which aid the care guides in their mission. The Guideway Care platform interacts with health system information through the digital cloud, which results in advanced communication protocols that ensure nothing is overlooked in conversations between patients and their care teams. Guideway Care also performs rigorous assessments of patients’ needs.
“I am very proud of our partnership with UAB,” Graham says. “While delivering a more than 350 percent return on the original capital invested in the program, they have created opportunities for us to share this proven process with other cancer centers.
We are doing something at Guideway that will redesign the way in which cancer care is delivered.”
As COO, Graham handles Guideway’s development and care-guidance teams. However, she is involved in all areas of the business as it continues to grow, and she describes the culture throughout Guideway as high-energy, collaborative, and focused on innovation.
“Right now, we are functioning as one big team,” Graham explains. “There aren’t really any divisions. Every single day seems different from the day before. It’s a rewarding place to be. We are getting to do such great work, and there are so many doors opening for us.”
Although Graham has continued to accelerate along her career path for almost three decades, she says her desire to keep improving and growing as a professional has allowed her to keep pace.
“You have to make sure you have good energy for what you are doing,” Graham says. “I love learning and doing new things. Part of what excites me about anything I do is finding a way to do it better. I don’t think you can ever perfect anything. There is always room to make progress.” AHL









































































































































































































































































BY PORCSHE N. MORAN
At BioPlus Specialty Pharmacy, Claire Heins has driven an ethical approach to delivering faster, more seamless medical solutions
Claire Heins, vice president of revenue cycle management at BioPlus Specialty Pharmacy, first started with the company twenty-seven years ago as a receptionist. Over the decades, she’s grown hand in hand with the company, as both it and the specialty pharmacy industry have expanded. “Although I inadvertently ended up in the specialty pharmacy industry, I was lucky enough to find the perfect match with BioPlus, which allows me to bring an ethical approach to my work with people who share a passion for excellence,” Heins says.
As a pharmacy group that specializes in medical specialties ranging from hepatitis C and Crohn’s disease to dermatology and multiple sclerosis—and, more recently, oncology—BioPlus’s patients often have needs for immediate treatment as well as varied medical plans that can be complex to navigate. One of the things that Heins appreciates most about the company, she says, is how much it focuses on partnerships with physicians and patients to ensure optimal outcomes for the patient’s health. A major solution that they’ve created and
are known for in the industry is their TwoHour Patient Acceptance Guarantee—a promise that BioPlus will conduct a full benefits investigation and inform physicians within two hours whether they will be able to service a patient.
This guarantee emerged from discussions in 2013 that BioPlus team members had with physicians about what areas of delay were frustrating for physicians and their patients. “Previously, patients could wait days or even weeks to find out if a particular specialty pharmacy could accept them for treatment,” Heins says. “With our guarantee, this first step to starting treatment is completed in just two hours.” She notes that for patients whose treatment is particularly timesensitive—such as oncology patients, for whom delays in starting medication could be life-threatening—having this immediate timeline can be vital to prompt treatment.
To supplement their commitment to patient care even further, BioPlus also released a new app this past May: RxCommunicator. This app provides physicians with a secure and instant interface to monitor each patient’s admission
journey, including the status of the twohour guarantee. In the event of a slower result, BioPlus makes a donation to patientassistance foundations, while a smaller donation is also made for every referral meeting the guarantee.
Working on the back end, Heins’s team also monitors results from the front end to make sure that there aren’t any issues, an approach that they refer to as circular training. “By having a peek at every other department, my team sometimes catches small errors, which we embrace as a learning opportunity—both fixing the immediate problem and setting up trainings to make the company stronger in future work,” Heins says, adding that this honest and open process helps make each team successful, which in turn lifts up the whole company.
This circular training ties into the company’s founding model, known as CART: Competence, Accountability, Respect, and Trust. “From the outset, we had a different
mind-set than other companies,” Heins says. The company’s core values are consistent across departments, from the open-door policy of management teams to keeping the workplace free from gossip in order to create a respectful environment and a culture of trust. “When patients see us demonstrate the qualities of reliability and trustworthiness in every interaction, they know they can count on us in what might be the most difficult health challenge of their lives,” Heins says. In fact, BioPlus views errors as an opportunity to fix something and prevent a recurrence in the future, something that they refer to as “failing forward.”
This leadership approach has paid dividends, as BioPlus recently expanded both their hepatitis C and oncology presence. “With these diseases, patients are literally fighting for their lives,” Heins says. With stakes this high, BioPlus supports patients by helping them navigate complex insurance issues and connect with foundations that

“When patients see us demonstrate the qualities of reliability and trustworthiness in every interaction, they know they can count on us in what may be the most difficult health challenge of their lives.”







provide financial assistance. These efforts have not gone unnoticed, with BioPlus recently ranking as number one in oncology among specialty pharmacies by a Zitter Health Insights survey and the Accreditation Commission for Health Care Inc. approving BioPlus for accreditation for Specialty Pharmacy with a Distinction in Oncology in 2016.
As one of the longest-serving members of BioPlus, Heins continually works to grow with them on every level. In 2010, she went back to school to get her BS in business management, learning more about ways to enhance her work within the company. This dovetailed with new responsibilities, including helping lead the accreditation team and working with compliance.
For Heins, it all comes down to doing the right thing for patients and physicians. A recent incident highlights this: a cancer patient contacted BioPlus, alarmed that they had inadvertently spilled water on their medication, destroying four pills of a high-cost and yet essential oncology medication. After unsuccessfully trying to replace the medication through the manufacturer and a patient foundation, BioPlus stepped up and sent out replacement pills at a company loss of eight hundred dollars. “For me, this is what it means to work at an ethical company that does the right thing for patients, regardless of profit,” Heins says. It’s why she’s stayed with the company for her entire career and continues to grow with both the company and the industry. AHL
BY GALEN BEEBE
Galderma’s Quintin Cassady is helping transform how patients receive care for chronic skin conditions
For those living with chronic skin conditions like acne, rosacea, and psoriasis, the problem can be hard to hide. Bumps, redness, and inflammation can appear right on one’s face. Quintin Cassady understood the impacts of skin conditions like these at a young age. Cassady’s father worked in the heavy equipment industry in Oklahoma, and he and his colleagues developed red, ruddy skin from the years they spent outside. “My dad and most of his peers were constantly going in for things like cryosurgery because they had so many skin discolorations,” he says.
Cassady began working in healthcare law in the field’s early days. One of his clients was Galderma Laboratories, a pharmaceutical skin care company that develops topical prescription and overthe-counter treatments for acne, rosacea, psoriasis, and other skin conditions. In 2000, Cassady became Galderma’s vice president and general counsel for North America. Now, he is changing the narrative around skin conditions and increasing access to care.
Shifting political pressures and a lack of resources have led insurance payers to seek opportunities to cut costs. Topical skin treatments for non-life-threatening conditions are an easy target. “Government payers as well as managed care and insurance companies increasingly don’t see those conditions as conditions that warrant reimbursement,” Cassady says. “They see them as more cosmetic.”
In response, Galderma is changing the story regarding what types of care are deemed necessary. “As we start to face issues for coverage, we’re starting to have to better justify the value that our drugs add beyond just curing your acne or minimizing your rosacea,” Cassady says.
Acne, rosacea, and psoriasis can be debilitating conditions, and breakouts can have widespread repercussions. “Certainly for teens, acne is a really significant psychological issue,” Cassady says. “People that have acne breakouts are far less confident at school, work, and in social settings.” Rosacea typically affects older populations, but the effects are no less devastating. According to surveys conducted by the National Rosacea Society, 90 percent of respondents said their condition had lowered their self-confidence, 88 percent said their condition negatively affected their
professional interactions, and 51 percent said they had missed work due to their condition.
Cassady emphasizes the socioeconomic implications of these findings. When skin conditions cause those affected to stay home rather than participate in work or school, it diminishes opportunities for advancement. On a case-by-case basis, this might not seem significant, but the US Government estimates that rosacea alone impacts more than 14 million people.
The narrative around rosacea, a chronic condition that is characterized by red, ruddy skin on the face and neck, has changed since Galderma patented its first rosacea treatment, Metrogel .75%, in 1988. At the time, rosacea was considered an orphan condition, and it was thought that fewer than two hundred thousand Americans lived with the disease. According to a study at the Wake Forest School of Medicine, an estimated 82 percent of those who live with rosacea still do not receive treatment.
Increasing awareness of the prevalence and impact of skin conditions such as rosacea, and of the treatments available, increases the likelihood that the right medications will reach patients in need. While Galderma is a well-known brand name among dermatological professionals and family practitioners—especially pediatricians who see many acne patients—it is not widely recognized by consumers, Cassady says. Galderma is owned by Nestlé, and in 2014, the company rebranded itself as Nestlé Skin Health. By capitalizing on the popular Nestlé brand, Galderma hopes to increase its profile and reach more potential customers who are living with untreated skin conditions. “We’re trying to use that as a vehicle to better tell our story,” Cassady explains.
Galderma develops prescription, selfmedication, and aesthetic and corrective skin-care solutions. Businesses can become isolated within a company with such widereaching interests. Throughout Cassady’s eighteen years with Galderma, his role has shifted from technical specialist to strategic leader. He was general counsel when Galderma acquired, licensed, or developed the businesses he interacts with, which gives him a holistic picture of the company that he uses to connect business leaders who would otherwise operate in parallel. “I know what’s been tried unsuccessfully, so I can help guide some of the strategy around our business

“Real people are benefiting by what we do here. I see that on a regular basis.”
philosophies,” Cassady says. “I have the ability, knowing enough about each of those businesses and how they’ve grown over time, to help them help the payers figure out how best to get our products reimbursed.”
Since Cassady joined Galderma, the legal department has grown from one lawyer and a small support staff to multinational teams with specialists in each area. Where Cassady might have once been closely involved in thirdparty contracts, he now leverages his relationship with third-party operators to strategically address broader-scale legal issues. “It’s a different skill set that develops over time,” he says. “It’s far less tactical and far more strategic today than it was when I started here.”
Skin care doesn’t end with prescription treatments, and the company’s holistic approach to treatment is an integral part of the story it tells payers. Products from Galderma’s diverse portfolio are often most effective when used in conjunction, an advantage it has over competitors who operate in a single market, such as prescription solutions. “You might get good reimbursement on a topical product, but a lot of those products have recommended that you also use a topical moisturizer in association with that,” Cassady explains.
Patients living with chronic skin conditions are at the heart of Cassady’s work. “Real people are benefiting by what we do here. I see that on a regular basis,” he says. “I’m excited about knowing that in some way I’m helping out those people out there that have ruddy skin that are working on the highway that I drive by.”
This was, after all, why he started in the business to begin with. AHL


BY CHUCK GREEN
After twenty-one years at Blue Shield of California, Seth Jacobs keeps growing the law department
Seth Jacobs SVP, General Counsel Blue Shield of California

Seth Jacobs hasn’t missed a meeting in twenty-one years. It’s part of his personal philosophy and why, as senior vice president and general counsel of Blue Shield of California, he has been able to cultivate positive working relationships with board members over more than two decades. When Jacobs joined Blue Shield of California as its first in-house general counsel in 1996, though, he was just adjusting to the “Blue way.”
“I was thirty-nine and the youngest general counsel in the Blue system and had no prior Blue experience,” he says.
Despite his young age for a general counsel, Jacobs quickly adapted to the Blue way and was able to gain the trust of leadership. That trust, however, did not come about by chance: Jacobs had nearly a decade of experience as the assistant general counsel of UnitedHealth Group and companies it had acquired. It also helped that the organization has a long history of respect for lawyers.
In 1939, Blue Shield of California was founded by, among others, Howard Hazard, a lawyer affectionately known as “Hap” Hazard. At that time, Jacobs says, the organization was one of the very first prepaid medical plans in the country, which was uncharted legal territory. “There was no precedent for a company like that,” Jacobs says. Ultimately, with the help of outside counsel, the legal foundation of the company was validated by the California Supreme Court, which Jacobs says helped develop a culture of respect for lawyers at Blue Shield of California.
“I think that helped me, coming in, to have that credibility conferred on me by Hap,” Jacobs says. “It gave me the freedom to do what I thought was necessary to build the department.”
When Jacobs first came aboard Blue Shield, there was no formal legal department at the company. There were a few lawyers scattered around, but there was no centralized organization. So, as the first in-house general counsel, he was charged with organizing and then building up the law department in addition to his responsibilities overseeing
corporate governance, the operations of the board of directors, and the governance process.
“That was pretty challenging to jump into, but it was a great opportunity,” Jacobs says.
Throughout the years, Jacobs has built a government affairs team and corporate compliance and ethics programs, to name a few components. And since he started, Jacobs has never really stopped building the legal department. In fact, Jacobs considers himself a team builder, and he is intimately involved in Blue Shield’s homegrown leadership program.
“I’d say it’s part of our DNA—not just for lawyers, but for all our leaders, down to the manager level, directors, and officers,” he says. “We all go through a leadership training program that we created and delivered. We didn’t go out to some consultant or advisor to buy an off-the-shelf leadership training program; we created and delivered it ourselves.”
Leadership development will continue to be a focus in the future, as Jacobs and the rest of the organization focus on growth and providing healthcare for a growing number of Golden State residents. “We don’t currently serve all Californians, so growth is inherent in that mission statement,” he says. “These days, growth requires cost-effective care. You can’t grow if people can’t afford what you’re selling.” To that end, he’s honed in on forging relationships with healthcare providers, physicians, physician groups, hospitals, and hospital systems to provide the public with seamless, quality, and cost-effective care.
In the spirit of that mission, Blue Shield of California acquired the Care1st Health Plan about a year ago. Originally
Seth Jacobs describes himself as a baseball convert. “I’ve lost all my East Coast culture and am a San Francisco Giants fan, through and through,” says the New Jersey native, who grew up a fan of the New York Mets.
But Jacobs enjoys sports with his children—a son and two daughters— more than watching any professional team, and has loved watching them grow into accomplished athletes themselves. Jacobs has many pictures of his son in his office, showing his growth in baseball from age three through to his time as a college athlete. Jacobs fondly remembers him hitting and throwing plastic baseballs—sometimes right at his father’s nose with incredible speed and accuracy.
“Baseball for me is a love that I developed out of my family relationships,” Jacobs says.
a Medicaid health plan, Care1st is now a subsidiary that allows Blue Shield to provide enrollees access to MediCal (California’s version of the federal Medicaid program), and it’s up to Jacobs to help meld Care1st into Blue Shield of California. That process includes integrating the legal departments of the two into one cohesive unit to continue to deliver high-quality legal services to the organization.
During his more than two decades with the continually growing company, Jacobs has seen a lot of change within the organization and with the industry overall. One of the biggest was the passing of the ACA, which he saw as an opportunity for him and his law team to grow.
“When the ACA was passed, no one was an expert in that law; it was brand new,” he says. “So we could all become the world’s foremost authority on what was to come. It’s exciting and energizing for lawyers, and I think that’s going to be the case as well in the next phase of healthcare reform. It’s a little scary, and we don’t know what it’s going to look like, but we’ll have an opportunity to become experts on those changes.”
Going forward, Jacobs says Blue Shield has an opportunity to influence reform at both the state and federal level. And he and his legal team won’t lose sight of Blue Shield’s mission. “When it comes to advocacy in state and federal government, Blue Shield kind of punches above its weight class,” he says. “We have significant influence that I think we’ve earned as a result of being a progressive, outspoken company that was among the first to champion universal care, both at the state and federal level. That gave us some credibility among politicians and thought leaders in terms of how to navigate the terrain and do so well.” AHL
“Seth is a highly experienced, thoughtful, and creative leader who knows both the law and the healthcare industry extremely well. He inspires those who work for him to do their very best and then enables them to do so, a rare skill found in the best leaders. It has been a privilege to work with Seth these past twenty years.” —Bob Bloch, Partner, Mayer Brown
“We’ve admired Seth’s innovative thinking, steadfast integrity, and seemingly boundless knowledge over our many years of collaboration. Thank you, Seth, for making us proud to be your partner!” —Manatt, Phelps & Phillips, LLP

Mayer Brown is honored to have worked with Seth Jacobs, Senior Vice President and General Counsel of Blue Shield of California, for more than 20 years.
We’re proud to call Seth and Blue Shield of California our client.
Manatt is proud to partner with Seth Jacobs and Blue Shield of California in transforming healthcare across America.
Americas | Asia | Europe | Middle East | www.mayerbrown.com
Manatt, Phelps & Phillips, llp
manatt.com
BY BRIDGETT NOVAK
Though many dream of working closely with professional sports, Gordon Richman details why he moved from working with NBA players to working with the FDA

It’s a career that many only dream of: representing and negotiating contracts for major sports stars. However, after spending two years in a small firm that represented about 10 percent of the players in the NBA, Gordon Richman decided it was time to move on.
“There were a couple of reasons I decided it wasn’t for me,” he says. “First, there were no professional qualifications or standards for sports agents, which led to some unscrupulous practices, like competitors trying to lure potential and existing clients away by offering or promising them whatever they thought they might want. Players didn’t know who they could trust among all the people vying for their attention.”
Personal relationships are also difficult, Richman explains. “As shown in Jerry Maguire, agents often become deeply involved in players’ personal lives,” he says. “I found that extremely challenging, especially when their sports career ended. How are you supposed to stop caring about them when they’re no longer a saleable commodity?”
The final straw was the death of allAmerican college basketball player Len Bias. “He was the best player at the University of Maryland, my alma mater, and I tried to recruit him,” Richman says. Two days after the Boston Celtics selected Bias as the second overall draft pick, he died from cardiac arrhythmia induced by a cocaine
overdose. “He was a great guy, and his death shocked everyone,” Richman says. “I was deeply affected by it and realized I was not cut out for this.”
Instead, Richman focused on finishing law school, and a year later, he joined Reed Smith in Washington, DC. His undergraduate training and BS in chemical engineering enabled him to play a more pivotal role than most young attorneys. As a first-year associate, Richman was involved in a $655 million wrongful death case involving a fire and explosion, a case that relied heavily on scientific facts and analyses. Though Richman repeatedly told the other lawyers how a gas pressure regulator worked, he was ultimately asked to handle the thermodynamics expert’s deposition. “My engineering degree enabled me to understand certain things, which gave me more opportunities,” he says. “I see myself as more of a scientist with a law degree than the other way around.”
The blending of technical and legal expertise has continued to play a major role in Richman’s career. In 1993, after six years with various international law firms focusing on areas where law and science intersect, Richman joined the legal department at Glaxo (later GlaxoSmithKline) as FDA regulatory counsel.
Richman was later promoted to director of worldwide quality strategy, and started working closely with EduQuest, an
FDA-regulatory consulting firm. He joined them in 2002. While there, he made a name for himself as a regulatory and compliance expert with a laser focus on the company’s ultimate business goals.
One of EduQuest’s clients, a billion-dollarplus medical device company, was having trouble meeting demand for its newest product. Richman walked the production floor to observe the assembly and testing processes and studied their manufacturing records. “I discovered that 80 percent of their records related to things that hadn’t gone right from the beginning—such as failed tests, nonconforming parts, and instances where something broke,” he explains.
The extent of these problems was mindboggling, but they didn’t see them as having an impact on the business. “They thought regulations were strangling them, but they had it backward,” Richman explains. “The level of nonconformance and test failures was costing them dearly. I’m pretty sure I shocked the division president when I told him their struggles were because they didn’t know how to build their product properly. This was a business problem with compliance consequences, not the other way around.”
In time, Richman was able to persuade management to re-engineer the entire production process, focusing on quality by design. This drove down the cost of nonconformance by minimizing variability in the design and production of the 350-pound medical device (which had more than 750 parts and nearly 650 assembly steps). The re-engineering cost $3.9 million and took 18 months, but increased production capacity for the device fourfold and gave the company a predictable and reliable process.
“I shocked the division president when I told him their struggles were because they didn’t know how to build their product properly.”
But the really big news was the numbers. “The ROI was $51 million a year for the life of the product,” Richman says. “They were able to accomplish that without any additional operators or equipment. The division president didn’t believe it at first. I had to assure him that I had not been involved in the financial analysis; it was his team that had, in their own words, ‘conservatively’ estimated the cost savings.”
In 2012, Richman left EduQuest to become vice president and regulatory compliance counsel for the in vitro diagnostics companies in Danaher Diagnostics Platform. His tasks run the gamut from assessing regulatory compliance requirements and risks in the various countries in which the organization operates and effectively communicating with regulatory authorities to determining the best way to conduct clinical trials.

Ropes & Gray
is proud to support
Gordon Richman
Vice President and Regulatory Compliance Counsel
Danaher Diagnostics Platform and the team at Beckman Coulter as they work to enhance lives, improve health and pioneer vital research advancements.
Gordon Richman’s foray into sports management was inspired by a distant cousin, Maurice Podoloff, the first president of the NBA, who told him fascinating stories about his life and career. In addition to wunderkind Len Bias, Richman worked with NBA greats Bernard King, Maurice Lucas, and Dell Curry, and helped Washington Redskins quarterback Doug Williams negotiate his “I’m going to Disneyland” commercial after winning Super Bowl XXII. “One of the highlights of my sports management experiences was getting to attend the 1985 NBA draft in Madison Square Garden,” Richman says. “We had four players selected in the first round that year: Chris Mullin, Charles Oakley, Kenny Green, and Bill Wennington. It was great to be there to witness and share the excitement of the very first moment of their professional careers.”
ropesgray.com
He and his team are currently preparing for major changes in the way in vitro diagnostic (IVD) and other medical devices will be regulated in Europe. The new rules (adopted April 5, 2017, and due to be implemented in 2020 and 2022) call for stricter premarket controls, increased risk analysis, and more postmarket surveillance.
As a member of the company’s Global Privacy & Security Council, Richman also focuses on cybersecurity. He was on the front lines of this trend long before many of his colleagues, speaking on computerized system compliance and validation at industry conferences in 2002, and participating in joint FDA industry planning committees.
“This job and this industry are dynamic and unpredictable. There’s never time to be bored,” he says. “The company’s development and growth philosophy also keeps it interesting. As soon as I wrap my arms around a business entity or product line, we develop or acquire a new one, which I find incredibly exciting.”
It’s a different kind of excitement from working with NBA stars, yes, but one that Richman finds far more fulfilling. AHL
BY RUSS GAGER
Patricia Ariel knew that both numbers and people were essential when setting up internal compliance and auditing departments for the expanding Westchester Medical Center Health Network
Patricia Ariel understands the challenge of meshing interpersonal relationships with hard numbers. But her determination carried her through years of night school as a single mother of a six-year-old, all the way to becoming an accomplished executive in the healthcare industry. That same determination helped her achieve one of her biggest accomplishments: building the internal audit and compliance departments at Westchester Medical Center Health Network in Valhalla, New York. But to do so, she knew that she’d need to focus just as much on people as numbers.
“When I first came here in 2007, I was by myself,” says Ariel, now the organization’s senior vice president and chief compliance officer, internal audit and compliance. “So, the first thing that I needed was staff.”
Ariel started staffing corporate compliance and auditing departments for Westchester’s three hospitals and hiring consultants when necessary. “When I came here, it took time to hire the right people and put a plan together to work with the CEO and board,” she says.
Ariel built interdisciplinary teams that included representatives of many of the hospital’s departments, not just her employees. “You can put policies out there, but if you can’t enforce them—and that includes with discipline—and you can’t manage them, you’re just putting stuff on paper that you’re never going to be able to meet,” she says.
Teams meet as often as necessary to evaluate whether procedures are being met. When improvement is needed, a subcommittee is formed that meets more frequently until the situation reaches the necessary benchmarks.
Ariel works to ensure that Westchester’s hospitals are operating to government standards before audits are performed.
Ariel’s determination ensured that effective compliance and audit practices were established at all of the organization’s facilities as it expanded to nine hospitals and
1,700 beds in New York’s Hudson Valley. “It was really one step at a time,” Ariel says. The first step of the challenge was addressing a hospital in Poughkeepsie that had no compliance officer.
“I drove up there and stayed in a hotel for twenty-three nights over the summer so I could meet everybody and get to know the operations and what I would need to put a plan in place,” Ariel says. She obtained approval to station a compliance director in Poughkeepsie from Westchester’s CEO and board of directors. That procedure was then duplicated for the other community hospitals that had been added to the network. Ariel’s techniques and determined leadership skills have enabled her to succeed in growing the network’s corporate compliance and internal auditing departments.
This would not have been possible if Ariel hadn’t developed the skills to manage this expansion through her years of experience in finance and the healthcare industry. She started working as a bookkeeper for Nassau County on Long Island, New York, while attending night school for her associate’s degree in business accounting.
After receiving her associate’s degree, her determination kicked in. Ariel realized that, as a single mother, she would need more education to ensure her daughter’s financial future, so she began attending night school to earn her bachelor’s degree in finance. “It wasn’t until I actually graduated with my degree that my career path grew and I had another goal that I wanted to achieve: to go into a leadership role,” Ariel recalls.
Determination was important, but Ariel knew it needed to be developed through education. She also knew that simultaneously raising her daughter, working full-time, and attending night school would require relying on strong relationships. “I had a good family behind me,” Ariel recalls. “That helped a lot. Sacrifices were made, but in the end it all worked out really well.”

Those sacrifices influenced her leadership philosophy, which is driven by empathy and the importance of human connection. “I am not a micromanager,” she says. “I believe you need to treat people as you want to be treated. I ask everybody in healthcare, ‘How would you feel if you were the patient receiving care?’ That resonates with people.”
Ariel’s empathetic philosophy is a natural fit in the healthcare industry, which she says feels like family. “People just seem to be more family-oriented,” she says. “The people care so much more about each other. I love the fact that I can talk to these people. Everybody has a business responsibility, and that always comes first, but there’s a human side. That’s the nature of healthcare: the human side. It just drew me in, and I never left once I got in.”
Even though Ariel says she did not expect to spend the past ten years at Westchester Medical Center Health Network when she joined it, she plans to remain in the healthcare industry for the rest of her career. “I love what I do,” she says. “I landed here and lasted here so long because of the established relationships and a CEO who really believes in compliance. It has allowed me to set up a compliance program that is stellar. I got so lucky to get tied to all these things and still reach what I believe is a success.” AHL
HCCS, A HealthStream Company, is pleased to congratulate Patti Ariel, vice president and chief compliance officer at Westchester County Health Care Corporation, for her outstanding accomplishments. We appreciate and thank Patti for her ongoing direction, support, guidance, and vision, and are proud to be a longstanding partner of Westchester Medical.



BY CHRIS GIGLEY | PHOTOS BY CHUK NOWAK PHOTOGRAPHY
How former banker Jonathan So is helping remake Detroit and Southeast Michigan into a healthcare hub
Jonathan So, senior director, health care initiatives at the Detroit Regional Chamber, grew up in the Detroit area. He went to college in Detroit, at Wayne State University. And he always intended to help make the city and the region around it a better place to live.
It was no surprise, then, that after several years in the banking industry, So joined the Detroit Regional Chamber, an organization devoted to driving economic prosperity in Southeast Michigan, in 2008.
“I loved working at the bank,” So says. “It was a great experience because I was straight out of college and I learned a tremendous amount about how business works. But in the end, the culture in banking just wasn’t for me.”
Needing a change, So’s passion for his hometown drove him to see how he could make an impact. Many local residents’ civic pride is largely born out of the city’s rugged recent history, he says.
“It’s really this idea that we have gone through one of the darkest periods of
any American city,” he explains, alluding to the auto industry crisis and Detroit’s bankruptcy filing in 2013. “From that, we’ve developed thick skin and pride about being survivors. Detroit has had the grit to bring itself back to being a great American city again.”
So jumped into the fray sooner than many. The credit crisis that paralyzed banking in the late aughts led him to take stock of his career and join the Chamber, even at a time when economic revitalization for the city wasn’t on anyone’s radar.
At first, his primary challenge wasn’t stoking economic development—it was simply helping existing businesses stay open by advising them on how to save money on their healthcare expenses. A large part of So’s job is to establish and communicate the common vision for healthcare and healthcare jobs in Southeast Michigan.
“It’s a lot of work,” he says. “I have to win people over every day to share in the future vision of Detroit’s healthcare economy.”


It was difficult for So to adjust his mind-set about his work. “Banking has a very established way of doing things,” So says. “There’s a tried-and-true method of finance, a lot of which was about risk aversion and making sure we could get paid back for things.”
That outlook wouldn’t work at the Chamber, however.
“You have to be really nimble, flexible, and fast,” So says. “I wasn’t experienced at making decisions on things and having the autonomy to do that.”
But the leadership at the Chamber allowed him to make his case for projects he felt passionate about and move forward with ideas he really believed in. Sometimes, he says, there was no precedent for what he wanted to do.
“This job has challenged me to increase the amount of risks I was willing to take,” he says. “My mentors and the organization’s leadership have shown me that more risks you take, the greater the outcomes.”
Now that the economy in Southeast Michigan has stabilized, new challenges have cropped up. The passage of the ACA in 2010 had everyone in the local business community asking questions.
“The Chamber didn’t take a political stance on the ACA, but I think we wanted to make sure our members and their employees had as much information as possible on how to prepare for it,” So says. “We had to make sure we communicated this complex law as capably as possible.”
But if there’s anyone who can do it, it’s So. He is as passionate about healthcare as a growth engine in the region as he is about the area itself. Step one, he says, is expanding the perception of Detroit beyond its status as an automotive hub. Along with industries like defense, agriculture, and tourism, So believes that healthcare is vital to Southeast Michigan’s economic growth.
“There are 330,000 healthcare-related jobs in Southeast Michigan,” he says. “That’s bigger than any other industry here, including automotive. Healthcare is
“Detroit has had the grit to bring itself back to being a great American city again.”
important. It keeps people healthy and it keeps us working.”
Getting that message out is one of three components in a new initiative that So is leading called HealthForward. HealthForward is comprised of employers, stakeholders, and health professionals working together to drive healthcare innovation and talent to Detroit. The initiative works to build the healthcare innovation ecosystem in the region, cultivate collaboration, and improve community well-being through placemaking and stronger infrastructure.
Another component of the initiative is putting patients at the center of healthcare consumerism. “I believe that the patient should be empowered to make wise healthcare decisions, both clinical and financial, and I don’t believe there are resources to do that yet,” So says.
He is focusing on making patient behaviors good consumer behaviors, equipping them with the information they need when seeking care, and redesigning a system in which the right decision is easiest.
So is also working on engaging millennials, who have no preconceived behaviors when it comes to seeking and receiving healthcare.
“It’s a blank slate to create new positive behaviors,” So says. “If we don’t do something now, they will do the same things previous generations have done, and that won’t work in the new system. This is our opportunity.”
The third component of HealthForward is focused on population health, ensuring people in the region have the best chance
to be healthy both physically and mentally. He says the main message here is that good health is good business. “It isn’t an expense, it’s an investment and a driver for growth,” he says.
Coordinating these initiatives requires constant communication to ensure that everyone’s efforts have optimal impact, So says. “A lot of people are motivated to do something in healthcare here,” he explains. “There are many people that are just as passionate, or even more so, than me. I just want to make sure we’re all on the same page in coordinating that future. A lot of things will work only if everyone is moving in the same direction.”
In 2016, Michigan ranked first in healthcare innovation, with two thousand open or active clinical trials, according to data compiled by the U.S. National Institutes of Health. Between 2010 and 2015, Detroit recorded a 44 percent growth rate for medical device-related patents, ranking Detroit fifth among the peer regions, ahead of major medical hubs such as Minneapolis and Chicago, the United States Patent and Trademark Office reported—showing that So’s efforts to position healthcare as a tentpole of Detroit’s economy are paying dividends.
The bottom line for So is that healthcare is a means to make Detroit and Southeast Michigan a better place to live. He’s already made plenty of progress toward that goal, proof that his passion for his hometown is contagious. AHL
In the 2016 scal year, the University Research Corridor (URC) institutions – the University of Michigan, Michigan State University and Wayne State University – were awarded a combined $604 million in funding for the advancement of healthcare.
In 2016, Michigan was the leader in health care innovation. With nearly 2,000 open/active clinical trials, Michigan ranks No. 1, leading California, Texas and New York
The region boasts a vibrant talent pipeline, graduating nearly 27,000 students with some type of health care-related certi cate or degree
By 2021, the health care services industry is forecasted to grow by more than 51,000 jobs, representing a 15.4% growth rate
Health care is the Detroit region’s largest industry employing more than 333,000 workers

27, 000 students No. 1 in innovation $604 million 15.4% growth rate
333, 000 workers
BY CHRIS GIGLEY
How Highmark Health’s Larry Kleinman has driven change from HR leadership positions throughout his career
“If you think about running HR like running a business, you know you have to earn that business every day.
Larry Kleinman, executive vice president and chief human resources officer at Highmark Health, started his own candy store at a young age. That business experience selling sweet treats, and later wholesaling fudge and ice cream, has continually helped him make a significant impact as an HR executive at the secondlargest integrated healthcare delivery and financing network in the nation. At Highmark, Kleinman applies a business-first mind-set to his HR role.
Pittsburgh-based Highmark Health employs more than forty thousand people nationwide and serves nearly fifty million Americans in all fifty states. Kleinman joined the organization in 2015, and has focused on reshaping the HR function. Much the way that Kleinman had to attract customers to shop at his candy store, he has to get Highmark’s employees on board with his HR policies if they are going to be effective, he says. “If you think about running HR like running a business, you know you have to earn that business every day,” he says. The business of HR at Highmark is already booming: within Kleinman’s second year, he improved overall HR effectiveness by 12 percent, all while the company underwent significant transformation.
One catalyst for this quick turnaround is a new technology platform that the company implemented under budget and in less than a year’s time. It streamlined 517 processes and created the HR Employee Service Center for 41,000 employees.
“All of those processes were reevaluated through the lens of what our customers want that process to look like, not what would be easier on HR,” Kleinman says.
He has also helped Highmark’s CEO and executive team realize an aggressive vision that helped the company make a $577 million turnaround in 2016. Highmark is in the midst of establishing an integrated healthcare delivery and financing system. The organization has presented an unusual challenge for Kleinman. “The difference is they were all healthcare providers that added some insurance over time,” he explains. “This has never been done from the payer side because it’s so complicated.”
Kleinman learned how to move forward with the HR vision by relying on the business-first approach he gained from his entrepreneurial days. That perspective was crucial, because the Highmark leadership team had a lot of new faces at the time, and it was his responsibility to get everyone on the same page.

Kleinman showed them hard data from the measurement surveys and other research he’d done, then laid out several options based on that data to move forward on the vision.
“We knew what the cost structure was and where the benchmarks were,” Kleinman says. “You build a lot of credibility when you have your facts together and present investment options. It’s no different from creating a business plan.”
Kleinman has been a catalyst for positive change his entire career, but his first HR executive job may have been his most radical. In 1996, Nabisco hired him as senior director of HR, overseeing the function at Planter’s Peanuts.
“What I did there I wouldn’t do anywhere else,” Kleinman says. “We designed the organization around chaos theory. The business had been around for ninety years and had hit a wall.”
Planter’s was based in North Carolina back then, and Nabisco moved the operation to its home base in New Jersey to keep a closer eye on it. Only twelve people made the move, and three of them left soon after they relocated.
“Suddenly, we had this green field opportunity,” Kleinman explains. “Our CEO was new and energetic and wanted to create an entrepreneurial organization.”
Employees were told that management didn’t care what they did or how they did it, as long as they got results that supported the overall goals of the business. Hence, the chaos—but it proved to be effective chaos.
“We had so many people just wildly energized about what they could do because they had no restrictions,” Kleinman says. “We were hitting on every cylinder and turned around on a dime. It was a lot of fun.”
Kleinman joined German software company SAP in 1999, a time at which its
sales team was enduring heavy turnover. The prevailing wisdom at the time was that talent was leaving for jobs in the Internet industry. Not satisfied with that conclusion, Kleinman wanted to see data that proved it.
“I looked at the numbers, and it didn’t have any correlation to why salespeople were leaving,” says Kleinman, who eventually established an overall talent profit-and-loss statement that let him test the revenue consequences of human capital investment options. In essence, he quantified talent. It took a few years to see results, but based on talent metrics, his efforts to hire the right people for SAP put $100 million back into the business.
Now that he has stabilized the HR function at Highmark Health, Kleinman is already on his way toward having a similar impact. For instance, he noticed a cycle of reliance on outside consulting firms. They’d come in, render advice, and then the company would go back to business as usual, prompting the cycle to repeat itself.
Get a finance and HR system that lets you focus on keeping patients happy.

Kleinman launched an internal consulting group called Enterprise Effectiveness, which has twelve projects underway and has already yielded about $50 million in value this year alone through cost reductions, asset efficiencies, productivity increases, and other measures.
“There is so much demand that we can’t staff it fast enough,” Kleinman says. Along with the CEO and CFO, Kleinman determines where to deploy the group. “It’s worked so well that the rest of the executive team wants more input because they want more services,” he explains. “We’ve created strong demand.”
If history is any guide, the demand for Kleinman’s ideas and initiatives should only grow—right along with Highmark’s bottom line. AHL
BY DAVID LEVINE
K. Scott Carruthers and the AIDS Healthcare Foundation’s cutting-edge medicine and advocacy works for patients around the globe who are most in need
Way back in 1951, a thirteen-yearold boy named Scott Carruthers got his first job. He would hop on his bicycle and deliver prescription drugs and sundry items to customers of a pharmacy in San Diego, California. Sixtysix years later, Carruthers is still delivering medication, but now he needs more than a bike to do it. As chief pharmacy officer and senior manager at the AIDS Healthcare Foundation (AHF), Carruthers is helping the organization deliver on its mission to rid the world of AIDS.
Having turned seventy-nine, Carruthers has no intention of walking away from the only career he has ever had. “I am having too much fun to retire,” Carruthers explains. “I enjoy working for a great organization. They will have to carry me out feet-first to get me to stop.”
Carruthers was born in Phoenix, and his family moved to the San Diego area when he was an infant. He got that first job from a pharmacist named Guy Combs, who promoted him from delivery boy to soda jerk, and then to all-around helping hand. “By the time I was sixteen or seventeen, Guy had his own pharmacy, and I continued to work
for him,” Carruthers says. “He was a good mentor and a father figure to me.” Combs encouraged Carruthers to go to pharmacy school, and he even accompanied him on his interview at the University of Southern California School of Pharmacy.
After completing his prepharmacy degree at San Diego State, Carruthers earned his doctor of pharmacy degree from USC. He returned to San Diego to work for Combs, who by then owned three pharmacies. “I floated among all three,” Carruthers says. A few years later, he formed a partnership to buy his own pharmacy and went out on his own for about four years. From there, he moved into servicing nursing homes. “Pharmacies weren’t providing all the services that Medicare mandated, and I thought that would be an interesting and pioneering thing to do,” he says. So he sold his pharmacy and started a new business. “I went knocking on doors, learned how to sell,
and built a long-term care business,” he says. He ran that for about four years before selling to a larger company located in Seattle.
Carruthers was in the long-term care pharmacy business for about twenty-five years, until changes in the business landscape and his growing family—he and his wife, Judi, who now live in the Los Angeles suburb Temple City, have six children— convinced him to make another change. “I was missing too many soccer games and other activities, so I went to Rite Aid and worked the graveyard shift so I could attend my kids’ functions,” he says. “I didn’t miss a single soccer game my daughter played in high school and college.”
Once his kids graduated, Carruthers became manager of the pharmacy but was not particularly fulfilled in his work. In 2004, a headhunter he knew gave him a call. “He asked me, ‘Are you ready to come out of retirement?’ I said yes,” Carruthers says.

Scott Carruthers’s CV includes other noteworthy entries beyond his role with the AIDS Healthcare Foundation. He was involved in developing a patient medication compliance packaging system that led the US Pharmacopeia to adopt standards for multiple-dose packaging. The National Association of Boards of Pharmacy also implemented these standards for dispensing in a multiple-dose adherence package. That led to Governor George Deukmejian appointing Carruthers to serve two terms on the California State Board of Pharmacy. He was also previously the president of the American Society of Consultant Pharmacists and earned the American Society of Consultant Pharmacists’ highest award, the George F. Archambault Award, for outstanding achievement in the practice of pharmacy in 1985.
Mike Etreby
congratulates
Scott Carruthers, Chief Pharmacy Officer of AIDS Healthcare Foundation.
We value our years of working together and look forward to continued cooperation.
“No matter how tough the day was, I know we have done something pretty special around the world.”

Eletreby
Enterprises Inc. Healthcare IT Consulting
“Then he asked if I had heard of AHF.” At the time, Carruthers hadn’t, but he learned that the Los Angeles-based nonprofit organization, founded in 1987, provides medicine and advocacy for HIV/AIDS care. AHF is currently the largest provider of HIV/AIDS medical care in the United States and serves more than seven hundred thousand people in thirty-eight countries around the world.
“They were providing care to people with HIV when no one would treat these folks,” he says. Carruthers was charged with expanding the domestic pharmacy program for AHF, which is now leading a mass testing initiative to identify and treat the millions of people who are unaware they are infected or not in care. “We call it ‘20-20’ because we feel that by the year 2020, if we and other organizations can get twenty million patients in care, we will start to get our arms around the infection,” he says. “Once the patient is in care and we get viral loads to undetectable levels, there is a high probability they won’t spread the disease.”
Carruthers has certainly come a long way from his time as a delivery boy and soda jerk. And he is quite content at where he is now. “AHF is a very rewarding organization,” Carruthers says. “I have been free to develop the pharmacy division, which generates most of the revenue that allows us to provide care regardless of the ability to pay. No matter how tough the day was, I know we have done something pretty special around the world. It’s my legacy and something that I am very proud of.”
AHL
BY BRIDGETT NOVAK

Nancy Sheehan SVP, Chief Legal Officer Catholic Health System
Most people have heard the saying “Life is a marathon, not a sprint,” but Nancy Sheehan truly embodies it. As a former long-distance marathon runner, Sheehan has applied a marathoner’s attitude to her career.
Sheehan started her professional journey as a nurse. She liked working with people, and after getting an associate in applied science degree in nursing, she took a job at BryLin psychiatric hospital in her hometown of Buffalo, New York. A while later, Sheehan moved to St. Louis, where she continued to work in healthcare while simultaneously getting a bachelor’s degree in business management. “It was challenging going to night school while working and raising four children, but I didn’t think an associate’s degree would carry me very far,” she explains.
After returning to Buffalo, Sheehan accepted a management position at Clearview, a substance abuse program at Mount Saint Mary’s Hospital, but still felt something was missing. “I wanted to be more autonomous, have input in decision making, and have greater control of my career,” she explains. Her brother, a personal injury attorney, suggested she try law.
“I thought it would be dry and boring, but I took the LSAT and did well. It ended up being something I had a strength for, and it was a lot more interesting than I thought it would be,” Sheehan says. So she juggled part-time work with classes at SUNYBuffalo School of Law. “Law school teaches
“Law school teaches you how the problems of the world are solved.”
you how the problems of the world are solved and about people and the various difficulties they get into.”
With her JD in hand, Sheehan returned to her early stomping grounds—BryLin Hospital—for a position as general legal counsel and risk manager.
Since then, risk mitigation has continued to be a major focus of her career. She joined Catholic Health System (CHS) in Buffalo as their legal services and risk management director in 2000. At the time, there were only three employees in the legal department, including a part-time administrative assistant. Now, as CHS’s senior vice president and chief legal officer, Sheehan oversees a staff of twelve, including an attorney who focuses on risk reduction.
Having both a clinical and legal background has given Sheehan a significant advantage at CHS. “It enables me to more fully understand the day-to-day operations and the clinical staff’s difficulties, like interpreting doctors’ orders or working double shifts and overnights. I’ve experienced those things firsthand, so I relate to them in a tangible way, not just from behind a desk.”
Sheehan’s background helps patients, too. For instance, the CHS staff sometimes calls on her when they have a particularly disruptive patient. “One strategy for dealing with those types of situations is to create a ‘behavioral contract’ that contains language the patient can agree to, like ‘I will not walk out of my room’ or ‘I will not yell at the nurses.’ We then have the patient sign the contract,” she says. “It’s not legally binding, but it helps the patient see that we’re looking out for their interests and that they have a role to play in their care.”
Sheehan has also been instrumental in strengthening CHS’s compliance with regulations through online education. “Most mistakes come down to people not taking the time to do things correctly or not fully understanding a regulation, so we offer refresher courses via NetLearning to make
it as easy as possible for them. If we see an area that’s being overlooked—like workers not washing their hands as frequently as they should, not calling for an interpreter for patients that don’t speak English, or misinterpreting a HIPAA rule—we will strengthen that part of the program.”
Sheehan’s experience with online education included an eight-year stint teaching in the University of Maryland University College’s master of healthcare administration program. “I taught healthcare law, but it was frustrating to not have any personal interaction with the students.”
Surprisingly, Sheehan’s favorite part of her job has nothing to do with clinical issues. “I like putting deals together,” she says. “As part of our growth strategy, we’ve been acquiring some physician practices and merging with other healthcare entities.” This has allowed CHS to expand its geographic reach and the services it provides beyond their four hospitals to include outpatient and home care, specialty clinics, and proactive care of chronic diseases.
One area CHS is just starting to explore is telemedicine. “Due to the current shortage of psychiatrists, we’re considering contracting with a national provider so patients at our affiliated rural hospitals who need psychiatric help can access psychiatrists via videoconference,” she explains.
Sheehan is glad that, after all these years, she is still finding new ways to help people. For instance, she participates in CHS’s “Women Helping Women” mentorship program. Sheehan’s mentee is thinking about going to law school to focus on regulatory work. “She knows she can reach out to me any time to discuss things and explore possibilities for her future,” Sheehan says.
And although she’s no longer able to run in the annual Buffalo Marathon due to back problems, Sheehan still finds a way to combine her passion for running, law, and medicine. “CHS is the major medical sponsor, so I take off my lawyer’s hat and pitch in as a nurse at one of the medical stations.” AHL


Mauren MacInnis has helped create a people-centered, future-focused culture at Dentsply Sirona
BY MARY KENNEY
“You need to create and sustain a winning culture that keeps people motivated, collaborative, engaged, and proud.”
Dentsply Sirona creates dental equipment and consumables that are marketed in more than 120 countries. But according to Maureen MacInnis, senior vice president and chief human resources officer, its products are not the only thing that makes the company unique. Its key feature, according to MacInnis: its people. “People talk about products and innovating products, and those are incredibly important. But great products start with great people,” she says.
Dentsply Sirona’s business model requires a focus on dental professionals and patients around the world, who have a wide variety of needs and require easy access to care. “It’s rare to be part of defining an industry, and our employees are driving that,” MacInnis says. “This means not only offering the best development internally, but also externally by supporting dentists in their ongoing training and clinical education. Everyone grows professionally. Everyone focuses on the future. Our living mission says: “Empowering dental professionals to provide better, safer, faster, dental care.”
MacInnis and the other members of Dentsply Sirona’s worldwide HR team know
that, as HR leaders, developing talent and leadership brings results. “You have to know what will make your business thrive, and you need to find ways you can build value and grow,” she explains. “At the same time, you need to create and sustain a winning culture that keeps people motivated, collaborative, engaged, and proud.”
Focusing on education, talent, and culture are major work for any organization, but in September 2015, another massive undertaking was added to MacInnis’s plate when Dentsply and Sirona announced their intent to merge. The combined HR teams rapidly went to work to unify the organization. The deal closed on February 29, 2016— a rapid approval process, especially for a global enterprise. Merging two separate cultures and practices could have been a protracted and painful process, but MacInnis says it was just the opposite. “On day one, we came out with a core vision and shared values, and made them part of introducing our new company to the world. We were two market leaders with over one hundred years of experience in dentistry—and we combined in record time. We were driven by the energy of knowing what we could create for our customers.”

Congratulations to Maureen MacInnis on being profiled in American Healthcare Leader for her people-first leadership strategy.
Like Maureen, we believe in the power of our people. We provide superior service to our clients every single day.
We’re who you talk to when you’re ready to go beyond goals. Exceed expectations. Outrival rivals. We can do it all.
Whether you need 5 employees or 500, we can customize a plan designed just for you.
From temporary to direct hire to enterprise partnership solutions, our programs are the perfect fit.
Contact us today to learn how our workforce solutions can make you and your organization better. adeccousa.com

“Everything is based on trust. You have to extend trust to get it, and it happens over time.”
The expanded global HR team realized an important benefit of an operational decision made six years earlier – the implementation of an enterprise-wide HR software. “This common platform gave us the ability to speak to our leaders in terms of measures that directly linked their people and their business performance,” MacInnis explains. “It raised our credibility as an HR team while also allowing us to focus where we were most needed.” The software allowed connection and access to employees around the globe, and the HR team could recognize and develop talent in a broader, deeper way. “That’s what really started us on the path to creating our learning-centered culture,” MacInnis says. MacInnis and the HR team don’t just encourage a culture of learning and development: they actively engage in those practices themselves. Throughout Dentsply Sirona, MacInnis encourages everyone to keep three things in mind: encourage people to ask for clarity about their roles; create an environment in which everyone can be successful; and develop a culture of trust. “Everything is based on trust,” she says. “You have to extend trust to get it, and it happens over time.”
This empathetic, people-first philosophy has helped make MacInnis the leader she is today. “I’ve learned more from my colleagues than I could ever have imagined,” MacInnis says. “I’m incredibly grateful. I’m a better leader because of them.” AHL



Profile shares the stories of the modern executive.




Share your story of exceptional leadership with our network of powerful business leaders.






BY JENNY DRAPER
Tolmar’s Jack McLane reveals what it takes to bring safe, effective medicines from the minds of his team to the hands of patients
Fort Collins, Colorado, may be known for its dozens of local microbreweries, yet Jack McLane brews up concoctions of a different kind: medicines. In this town in the foothills bordered by the Rocky Mountains, the vice president of clinical development at Tolmar works alongside his team of scientists, chemists, and engineers within the three hundred thousand square feet of high-tech laboratories and manufacturing facilities. Together at the pharmaceutical company’s headquarters they invent and distribute remarkable products for patients around the world.
Tolmar’s anticipated 20 percent growth caught McLane’s attention, and he joined the company in July 2014. He felt his breadth of experience at large pharma and small biotech companies could boost the company’s trajectory. “It was one of those opportunities where, intellectually, the stimulation and the potential of helping a company grow was really important to me,” says McLane, who has devoted his career to tackling diseases like Parkinson’s, Alzheimer’s, schizophrenia, and more.

McLane’s background certainly equipped him for the task at Tolmar. He began his career as a postdoctoral researcher at the Yale University School of Medicine after earning a master’s degree and a PhD in biology from the University of Rhode Island. He has not only worked with R&D, but with marketing, finance, and regulatory functions as well. He has managed clinical trials, budgets, strategic operations, and US FDA applications for pharma, including Hoffmann-La Roche and Clinquest—the latter immediately prior to Tolmar.
“I’ve always been interested in making sure I’m working on products that are going to be safe as well as effective for patients,” McLane says. “It drives me to make sure we’re doing good science and making sure we really are thinking about the end result.”
The end result at Tolmar comprises a portfolio of innovative generic and proprietary products in therapeutic areas, and its twenty-four FDA-approved products range from dermatologic care to palliative treatment of prostate cancer. “There’s an awful lot of competition in the market today for different drugs,” McLane says. “But we’re
looking at what’s affordable for the patients and giving them products that will help them have better healthcare overall.”
Currently, Tolmar is working on a number of drugs for severe neurological disorders and other neurological conditions with injectable drugs. “It’s exciting because these drugs have shown to be very effective in having a longer time that it acts in the body between having to take doses,” McLane explains. “And for patients with neurological disorders, it means they get much better treatment over time.”
McLane’s chief role is ensuring that the benefits of Tolmar’s products outweigh the risks, and he says that pharmacovigilance is crucial both to patients’ health and the company’s success. His team’s deep knowledge of the drugs’ pharmacology applies to multiple facets of product development, including the safety information listed on packaging inserts. It also requires a proactive understanding of how each product’s molecular structure could interact with patients’ diverse physiologies.
“Each drug they develop has unique characteristics, and you have to look at them and think robustly,” McLane says. “You have to make sure you’re thinking of how to summarize the data that you’ve collected and present it in the best format for the regulatory submissions to the FDA. And that strategy of presentation and choosing the best set of trial designs—that’s what I’m able to bring forward.”
Tolmar has 5–10 products getting ready for clinical trials each year according to McLane, taking 2–5 years each before applying for FDA approval. While McLane says that each company is different in his experience, at Tolmar, generic drugs typically take 9–14 months for FDA approval, whereas proprietary products, known as new molecular entities, typically will take about 1–2 years to get approved.
As Tolmar’s vice president of clinical development, he’s constantly designing the best clinical development programs and
“I’ve always been interested in making sure I’m working on products that are going to be safe as well as effective for patients.”
evaluating the process carefully to ensure teams can understand and respond if a product safety issue arises. That attention to operational strategy contributes directly to product innovation.
McLane explains that his insight into the marketplace and what consumers are looking for directly influence clinical methodology. “We ask, ‘Is there a way to extend the formulation so that patients can take a drug a little less frequently and still maintain the drugs’ effectiveness?’” McLane says. It also helps the drug formulators identify the market objective and, in this case, adjust the time the product remains active in the body.
Looking ahead, McLane sees Tolmar expanding more and more into injectabletype products. “It’s a unique swath,” he says. “There are not a lot of companies that have this ability to formulate products that, for example, have a long release time or long activity in the body.”
Tolmar’s global expansion is also implementing clinical trials and speeding up evaluations while working to spread health benefits to populations that may often find getting treatments difficult. McLane says they also have one clinical trial that’s particularly interesting because it’s working with pediatric patients suffering from a rare disease. Plus, Tolmar has partnerships with global companies that distribute its products in more than sixty-seven countries,
and McLane says Tolmar certainly aims for continuous progress.
“This is a company that definitely wants to keep growing and really establish itself as a good, solid, thoughtful company that really is working on innovative and appropriate products,” he says. “Employees contribute to real-world work. We want to make sure we have meaningful employment here in Northern Colorado.” AHL
Everest Clinical Research is a proud partner of Tolmar, delivering value through our commitment to quality, customer focus, and flexibility. Everest is a full-service CRO to the biopharmaceutical and medical device industries for project management, clinical operations, data management, biostatistics and programming, IRT/IWRS, pharmacovigilance/ drug safety, medical writing, and regulatory submissions. www.ecrscorp.com
“Fisher Clinical Services is proud to work with Tolmar and its forward-thinking leaders like Jack McLane to make the world healthier. For more than twenty-seven years, Fisher Clinical Services has been committed to delivering the highest-possible value and ensuring adherence to the utmost level of quality, performance, reliability, and sustainability standards while serving the packaging and distribution requirements of clinical trials across the globe. We look forward to continuing to support Tolmar in their studies.”




BY RUSS GAGER
Audrey Murphy has spent the past twenty-five years advising Hackensack Meridian Health on how to help its patients through the law
Audrey Murphy first realized her life’s passion was to help people when she worked in a rest home for the elderly as a teenager. Since then, she has built a successful career in healthcare, but her focus has always remained the same: helping people.
Murphy began her career by working shifts as a hospital nurse, and during the AIDS epidemic in the 1980s, she began to see the importance of law in healthcare. As AIDS patients lost their jobs and apartments due to fear of infection by the little-understood disease, Murphy saw that these patients needed more than healthcare–they also needed their rights.
While still working full-time, she began law school at Pace University, where she had earned her BSN and MSN in nursing. By 1992, she had earned her law degree with a concentration in healthcare and was hired at Hackensack University Medical Center as associate counsel and director of risk management.
Twenty-five years later, Audrey is now executive vice president, general counsel, hospital enterprise, for Hackensack Meridian Health, a network of thirteen hospitals and more than two hundred ambulatory care centers serving Bergen to Atlantic counties in New Jersey. Murphy and her ten-person department provide legal advice for Hackensack Meridian Health, which was formed from a merger of Hackensack University Health Network and Meridian Health System and is headquartered in Edison, New Jersey.
“I have a great job,” she says. “It’s been a great career path. I’ve really enjoyed my job as it has changed over the years, and appreciate how there’s always something new to learn. I really enjoyed how the organization has evolved—we are now a very large network.”
The growth of Hackensack Meridian Health has brought its own set of challenges, although that’s not necessarily a problem for Murphy. “I like a challenge, so this has been a great position for me,” she says.
When it comes to the challenge of leading a team, her management philosophy is to be flexible and not to micromanage employees. “You need to allow people to be autonomous,” Murphy says. “You let them bloom on their own and celebrate when they do well. When the team does well, it makes the organization run well.”
And it’s no surprise that her nursing background has been invaluable in her legal work. “As legal counsel, you get pulled into
a lot of operational issues and strategic planning,” she explains. “And if you have a healthcare background yourself, that’s a huge advantage because you understand how the healthcare system works.”
This understanding of the healthcare system has helped Murphy earn numerous awards for her and her legal department’s work. She won the Innovator Award at Pace University’s Spirit of Pace Awards Dinner in June 2016, and she and her staff were previously honored as the Best In-House Legal Department of the Year by the New Jersey Law Journal.
Murphy’s focus on helping patients through the law has continued in the innovative programs she has helped facilitate.
One such program is called Orchestrate Excellence, which encourages supervisors to make the rounds of their hospitals and medical facilities to examine various aspects of their operations.
Recently, Murphy made the rounds at one of the network hospitals with the co-CEO, and she believes that making rounds is a best practice that is proven to help improve the experiences of patients, families, and team members.
Another new initiative is the Event Evaluation and Resolution Committee, which evaluates risks and suggests proactive steps to ensure patient safety.
The Grievance Investigation and Response Team is another new program geared toward patients and families, in which each facility’s patient experience team meets











Hoagland Longo congratulates Audrey Murphy on her recognition as a vital member of Hackensack Meridian Health.






“I like a challenge, so this has been a great position for me.”
www.hoaglandlongo.com
with top administrators, including Murphy, to discuss patient concerns and determine the best resolutions for them.
Despite her family and career responsibilities, Murphy still finds time to volunteer with numerous organizations, including Project Literacy of Greater Bergen County. “When I sit down to assist people with their reading skills, you realize that you need to be patient, set priorities, and take small steps,” Murphy says. “Volunteering is a very rewarding experience.”
Murphy still has another goal she would like to achieve: earning a doctorate in nursing. “I’m very interested in the patient safety aspect of patient care,” she says. “While we’ve made strides, I don’t think that we are anywhere near where we could be in terms of medical errors, patient falls, and other issues. Medical centers should be safe places. I think in the United States we should strive to have all of our healthcare facilities be high-reliability organizations with an emphasis on patient safety and quality care.” AHL
Since our founding in 1977, Hoagland Longo has worked closely with a variety of clients in the healthcare industry focusing our strengths on obtaining flexible, achievable results. In today’s multifaceted healthcare industry, we work to find result-oriented, cost-effective approaches that help our clients meet their goals. Visit Hoaglandlongo.com today.









Founded in 2005, ALTTRIX has grown organically straight from the start. It began as an online hardware and software store with just two individuals working out of a run-down warehouse in midtown Manhattan. They have grown to be innovators, problem solvers, and solution providers having helped companies with 3D Imagery, Automotive Wireless Technology, Digital Payment Systems, Speech Technology and On Premise Self-Serve Inventory Warehouse technology. What was our success? Proven technology solutions, customer satisfaction, innovative solutions, cost-e ective problem-solving solutions, and capital and operational cost reduction methods.

Our mission is to provide the best innovative technology service provider and become the technology experts customers can rely on. Throughout the years, we have grown to be the Alternative for Excellence (ALTTRIX) in Cloud, Data and Telecom, Data Center Services, Digital Media, Digital Marketing, Flexible Display Technology and Audio, Video, Web Services
We look forward to serving you.
Even a brilliant mind has its limitations, and physicians and nurses are no exception. But with the right medical equipment, these talented medical practitioners can further enhance their treatments by utilizing state-of-the-art products to better patients’ lives.
Scott Hinshon and Orthotic Care
Services bring innovative care to pediatric oncology patients
By Adam Kivel

When Scott Hinshon saw his opportunity to take over leadership of a healthcare organization after years of providing pediatric orthotic care, the company’s name gave him pause: Orthotic Care Services (OCS). It was a little on the simple side, not as flashy as its competitors. But he made the leap, bought the organization, and decided to keep the name. Its simplicity actually echoed his focused, passionate drive to help individuals in need, particularly pediatric oncology patients and patients with life-changing disorders such as cerebral palsy and Down syndrome. In fact, Hinshon and his team have developed products like the Go-Buddy Ankle Foot Orthosis (AFO)—an innovative brace with a hard outer boot and soft inner boot that work together to improve mobility, maintain neutral joint alignments at the foot and ankle, and prevent the irreversible deformities commonly seen in pediatric diagnoses—in order to help young patients run, jump, and play, today and in the future.
Prior to taking ownership of OCS, Hinshon spent years specializing in spinal and pediatric lower extremity orthotics. He worked closely with patients to achieve outcomes rather than delivering plastic wearables, emphasizing engineering and collaborative plans that created custom solutions for individual needs. “I don’t look to deliver braces, but rather for an opportunity to help,” Hinshon says. One primary way in which OCS accomplishes that is through a partnership with Children’s Hospitals and Clinics of Minnesota and other pediatric organizations looking to make a difference in the lives of their patients.
The Go-Buddy AFO, in particular, has been a major focus for Hinshon and his team. In years past, more and more oncology patients were being referred to OCS for foot orthotics, as their foot and leg strength were being affected by chemotherapy. OCS and Children’s Hospitals and Clinics of Minnesota are partnering on research called “The Impact of Solid Ankle Foot Orthoses on Physical Function with Chemotherapy-Induced Peripheral Neuropathy.”
Although chemotherapy is an essential part of pediatric oncology treatment, it has side effects that can be devastating. The therapy can, in fact, change the very shape of a child’s foot. “These symptoms have permanent effects on children. Changes in bone structure of the foot and ankle lead to many other side effects,” Hinshon explains. “Early intervention is the main goal. We don’t want to wait for anticipated symptoms. To prevent injuries, you need to educate families and care providers of the risks. It gives the family hope when you communicate the information appropriately, acknowledging and truly understanding the pathology and the significant ramifications for delayed interventions.”
Greater than 80 percent of children diagnosed with cancer will survive for five or more years. Cure rates are rising, and emphasis is being placed not only on finding a cure, but also on improving patients’ quality of life. Cancer treatment may involve chemotherapy, radiation, and surgical interventions, which eliminate cancer cells in the body; however, these treatments also damage the healthy cells, resulting in multisystem late effects. Neuromuscular impairments and physical function limitations are among the documented late effects of childhood cancer. These impairments can make participation in physical activity difficult. In order to be physically active, one must have strength, flexibility, and mobility to challenge the cardiovascular system. Current literature reports high incidents of chemotherapy-induced peripheral neuropathy, muscle weakness, ankle contractures, and gait inefficiencies in children receiving chemotherapy, with the effects persisting into adulthood.
According to Hinshon, designing properly engineered and fitted AFO systems can allow patients to maintain the joint integrity of their body while retaining the normal function needed to help them live happy, full lives. Although cancer treatment has vastly improved, those improvements often focus on patients with life-threatening diseases rather than survivors’ physical health post-treatment.
Over the past ten years, there have been significant developments with orthotic design methodology. “At OCS, we’ve pushed the boundaries to find solutions that form, fit,


Orthotic Care Services (OCS) makes a negative impression of each patient’s limb to customize care plans.


OCS gives each child the opportunity to be a part of the AFO decisionmaking process.
and function better than they ever have before,” Hinshon explains. “In order to achieve this consistency of success, we had to take a close look at our internal processes and the consecutive steps that are taken at the point of contact with a patient.”
Attention to each and every detail has translated to improved comfort, compliance, and outcomes. Material science and fit strategies have been the driving force behind improving the functional performances and outcomes for patients. “The answers to these questions are complex but are better understood today than they were even yesterday,” Hinshon says.
Understanding gait, muscle strength, muscle tightness, joint alignment, and the effect of those factors on the human body have guided orthotic design. OCS, though, is constantly reinventing the wheel. “We seek to mimic nature,” Hinshon says. “If you look close enough, you’ll notice how the many small details add up to make a big difference.”
Mechanical fitting strategies describe how the orthoses attach to the body, how they dynamically move like flesh and bone, how they structurally interface with the ground below, and how those forces, when designed just right, enhance mobility.
In years past, orthoses would be fit to the bottom of the foot or to the back of the leg. Today, OCS’s designs envelop the limb by wrapping around it circumferentially, acting like connective tissue to maintain the orthopedic structural integrity underneath. “This prevents the limb from moving inside the orthosis and becomes a part of the body as the device secures itself to the limb,” he says. “We use materials that are hard over areas that are soft, and soft materials over areas that are hard.” This framework becomes stiff and soft at the appropriate point during the walking and running cycle.
“What is the normal physiology of walking, running, and jumping, and how do we use material and components to create optimal performance?” Hinshon asks. The solution, he’s found, is to utilize stiff and soft zones to create structural control where it’s needed, and shock absorption during impact and where movement and potential pressures are anticipated. “There is a new focus to have the orthosis interface with the body and with the ground to enhance the experience and functionality,” Hinshon says.
An average child takes ten to fifteen thousand steps per day, so neuropathy, weakness, and abnormal stride can
mean serious damage to ligaments. “When muscles are weak and fatigued, all of the stress is localized to the ligament structures and cause them to lengthen, and when that rubber band-like material elongates, it stays long,” Hinshon says. These physical changes to the structure of the foot won’t go away, and in fact will last patients a lifetime. They then often rely on orthotics to help ease the pain and correct untenable walking patterns. “We understand the cause and effect of these life-saving medications, so we have become better at anticipating symptoms and methods of protecting the foot structures,” Hinshon says. “Two or three years of intervention is a short-term commitment for a long-term outcome. The goal to make sure they don’t need physical therapy and bracing for the rest of their life.”
To provide the support patients need, the OCS team knew the AFO designs would need to be comfortable and not prevent kids from doing things that kids do: running, jumping, and transitioning to and from the floor. “It’s a delicate balance,” Hinshon says. “In the past three years, we’ve established reproducible processes and methods to improve the quality of the fit, which has a direct correlation to function. We’re now at the point that we want to share our innovation with other oncology centers around the country.
By educating others and creating a common understanding of the side effects, OCS hopes to show providers and patient families the impact that early intervention can have on quality of life throughout the patient’s childhood and into adulthood. A pilot study has shown positive results in OCS’s ability to help restore or maintain range of motion at the ankle. The new study aims to further prove that OCS’s technology excels past that of other orthotics providers. “It’s taken us years to perfect the craft of making a circumferential, total contact style of brace,” Hinshon says.
The OCS team always has the mind-set of care. “We’re not trying to design braces; we’re trying to design solutions,” Hinshon says. “Our mission is bigger today. We want to share this information to help more kids across more hospitals.” OCS is prepared to bring awareness and share its innovations with the oncology community. “We are partnering with pediatric hospitals and orthotic companies around the country to bring competency and orthotic care to their patients,” he says. “We feel blessed to have the opportunity to help them and to be able to share good news about preventing lifelong injury to these kids’ feet and ankles.” AHL
DARI’s Joel Hungate believes his company’s cutting-edge technology is shifting the paradigm in the realm of treatment and prevention in musculoskeletal health
By Randall Colburn
Five years ago, Joel Hungatez was a medical device consultant and a biomedical engineer with a desire to make a difference in orthopedics and, more ambitiously, shift the paradigm in musculoskeletal health assessment. As it turns out, everything he was looking for was right next door to his office.
At the Dynamic Athletic Research Institute (DARI), a group of researchers, led by brothers Patrick and Ryan Moodie, was refining motion capture technology not unlike the kind that’s used in creating video games and animated films. The goal at DARI, however, was to figure out how they could use this technology to achieve objectivity in the realm of sports performance, namely in treating and preventing joint and muscular injuries.
On a whim, Hungate stopped into the DARI offices to check out what the neighboring researchers were doing. Impressed by the potential of this technology, Hungate kept on coming back. He saw an untapped opportunity in DARI’s technology to bring an objective eye to healthcare, where motion health is typically treated and tracked via subjective and unrepeatable “eyeball tests.” Hungate believed that the technology had the potential to predict and prevent pathologies on a grander, population-level scale, thus allowing patients to engage in their motion health like never before.
“I thought to myself, ‘When this turns the corner and reaches a speed and scale that we can use in clinical settings, where we can get a scan and see objective data immediately, where we can action it in a patient population, that’s when we need to start talking about taking this to the next level in healthcare,” Hungate says.
When that day came, Hungate took action. “I couldn’t stop my mind from trying to work through all the different ways we could apply the technology,” he says. Fueled by enthusiasm, he put together a presentation and proposal before ever working in an official capacity for the company. He then took the proposal to potential healthcare customers in an attempt to plant seeds and gauge interest in the technology. It wasn’t long until DARI appointed him its vice president of orthopedics programs.
“Ever since, I’ve been dreaming up new ways for us to use this technology in healthcare to make such a difference in the lives of patients and clinicians by treating musculoskeletal health objectively,” he says.
Here’s how it works: A patient steps into the system—which has no sensors, markers, force plates, or lengthy calibration—and strikes a pose so DARI can overlay a “digital skeleton” on the patient’s body. From there, the technology calculates all kinetics and kinematics during any movement in three dimensions. It can also perform a full-body scan that involves a nineteen- or twenty-movement pattern or target individual




problem areas with single motions. Afterwards, an online portal, dubbed the DARI Vault, calculates the biomechanics, applies algorithms and reporting constructs, and generates comprehensive reports and DARI “scores” based on motion health—all in roughly five minutes or less. An added bonus is that patients can wear whatever they want during the process.
Using DARI’s technology, clinicians and physical therapists can objectively identify dysfunction and imbalances and assess musculoskeletal risk, thus improving their ability to treat issues before they manifest as costly complications.
Hungate aligns DARI with the movement toward personalized medicine and prevention in healthcare. “When we scan someone, we capture a personal motion signature,” he says. “From that point on, we can see the objective manifestations of our medical interventions and achieve a better, more effective way of identifying care paths and matching people to whatever therapies meet their needs. We can start to get ahead of these problems before they become a burden on the system.”
There’s been ample interest and a number of positive testimonials about the real-world benefits of DARI’s technology. The Carlton Blues, an Australian rules football team in Melbourne, experienced their first season without an ACL injury in one hundred years after using DARI’s technology. Likewise, UC Health and Steadman-Hawkins Denver Clinic are currently using the technology to fundamentally change the way they deliver orthopedic and PT care. Rolling out the technology worldwide, however, will take time. “It’s a paradigm shift,” Hungate says. “We’re talking about opening up the floodgates and providing data that nobody had access to before. You have to build the onus
and the use case for applying that data. You have to show the value.”
Luckily, DARI’s value is continuously growing. DARI’s parent company, Scientific Analytics, is consolidating the rapidly evolving technology. On a grander scale, Hungate says DARI will soon be able to leverage its database to use predictive analytics to identify biomarkers that predispose patients to specific outcomes or specific pathologies. At approximately three hundred thousand human motion files, he says it’s the largest database of its kind in the world.
“It’s such a new idea to treat motion this way,” Hungate says. “We want DARI to be a new way for people to think about their health. Movement is medicine, and if motion really is the next vital sign, then we are the ‘blood pressure cuff’ for human motion.”
Someday soon, Hungate believes, everyone will know their DARI scores—and we’ll be better off for it. AHL
Network mobility is the biggest opportunity for healthcare in today’s technology-driven market. With the competitiveness of the new healthcare landscape, innovative healthcare applications are now a necessity; these include mobile clinics, bringing healthcare to the patients for home care, ambulatory applications, and traveling doctors that bring their own network (BYON) to clinics to provide care.
The growth of 4G LTE networks now lets medical professionals sever traditional ties to the office and use high-speed, reliable connectivity to enable key wellness programs and bring advanced care to patients anywhere and everywhere.
Learn more at www.cradlepoint.com/healthcare.
How Ingrid Foerster is helping to create a smarter, more proactive approach to healthcare via IBM’s core cognitive technology: Watson
By Chris Gigley
Few fields generate more data than healthcare. Scientists researching breast cancer, for instance, can generate thirty thousand papers a month on new findings and existing treatments. It is humanly impossible to keep up with it all, let alone analyze and interpret it. But Watson can.
Ingrid Foerster, Watson Health Group’s intellectual property counsel, readily admits that she loves talking about the core technology she protects. She can’t help but discuss Watson’s natural language processing capabilities and its potential benefits.
“Watson is this scalable cognitive platform used in all types of domains,” Foerster says. “But it’s uniquely well-suited for healthcare because it’s able to ingest volumes of information in the form of content and data.”
Foerster calls Watson the perfect physician’s assistant. “Watson never tells the doctor what to do, but provides the latest research from around the world to the treating physician so that the patient is offered the best possible treatment options,” she says.
One of Foerster’s key roles is helping Watson Health get access to data and subject matter expertise to make the platform increasingly smarter and accurate. Technology has had a huge impact on the future and direction of healthcare.
This past November, for instance, IBM Watson Health and the Broad Institute of MIT and Harvard started a five-year, $50 million research project aimed at discovering the basis of cancer drug resistance. Anonymized data from the project will be made available to the scientific community to catalyze research worldwide.
In February, Jupiter Medical Center began using Watson to help oncologists deliver personalized, evidence-based cancer treatments. That same month, Watson Health Group announced plans to develop

a cloud-based service designed to improve the physician-patient experience at Atrius Health, which serves 675,000 patients in eastern Massachusetts.
Watson should become more widely used in the future. In the wake of four acquisitions over the past two years, IBM’s health cloud now houses one of the largest and most diverse collections of health-related data in the world. It contains the aggregate health information of about three hundred million patients, an extensive cloud-based data set spanning hundreds of different types of costs, claims, quality, and outcomes information.
“I’m meeting with the developers of these acquired companies to help them understand how important their innovations are to IBM and how we can protect what they’re bringing to us,” Foerster says. “These acquisitions
February 2011
Watson makes its television debut on Jeopardy!, defeating two of the all-time champions in a three-day match.
March 2012
IBM and Memorial Sloan Kettering collaborate to use Watson for oncology treatment.
October 2012
IBM announces its partnership with the Cleveland Clinic to help train medical students who will expand their learning by using Watson as a training tool.
have no idea how valuable their IP is, and we have to help them understand that we can’t simply give it away.”
Foerster and Watson Health are also gaining data and expertise for the platform through partnerships with outside vendors. Foerster has been involved with many of those negotiations, which she says has been a lot of fun. “When I get to work with researchers and data scientists, my techie side comes out,” says Foerster, who earned a BSAA in electrical engineering at the Illinois Institute of Technology.
When she’s not in a lab studying the technology, Foerster works with internal clients to develop thoughtful strategies to protect it. The work involves invention mining and educating internal clients on IP laws, in addition to weighing different approaches when it comes to trademarks and copyrights.
The work isn’t easy, as the technology is constantly evolving; her vision must shift along with it. But few grasp how to get things done at IBM better than Foerster. While in college, she did some cooperative work as an engineer for IBM, which hired her on full-time in 1989. “I decided I wanted more breadth to the job,” Foerster says. “As an engineer, you can be incredibly focused on one piece of technology. I went to law school while I was working.”
Halfway through law school, IBM moved Foerster to the IP legal department in its storage group. The company eventually
shifted her to the software side of its business. When the healthcare division was founded in 2015, she was the one who initiated her move.
“Overall, IBM makes a difference in people’s lives by providing convenience through technology, but this is even more than that,” she says. “I come from a family of doctors, so I have an interest in the medical field. It was a marriage of all my interests.”
Foerster says her job constantly keeps her engaged because of all the new ways healthcare entities want to use Watson. In a partnership with Medtronic, for instance, Watson will predict hypoglycemic episodes in diabetic patients nearly four hours ahead of time, preventing potentially devastating seizures.
While custom applications are breaking new ground, Watson Health is establishing what Foerster calls “off-the-shelf Watson systems” that physicians can subscribe to. The best example is Watson Oncology. Clinicians and analysts at Memorial Sloan Kettering are working with IBM to train the system to interpret cancer patients’ clinical information and identify individualized, evidence-based treatment options that leverage decades of experience and research.
“One thing my career at IBM has guaranteed is that my job changes and evolves as the company does,” Foerster explains. “I don’t know what tomorrow will bring, but I’m sure it will be exciting and challenging.” AHL
Patterson + Sheridan, LLP is proud to have worked with Ingrid Foerster for many years in her capacity as IP counsel for IBM. Ingrid’s experience, guidance, and insight have served her and IBM well in ushering in a new era in cognitive computing. We proudly join in celebrating Ingrid’s many achievements!
April 2015
IBM establishes Watson Health with two acquisitions (Phytel, Explorys) and partnerships with J&J, Medtronic, and Apple.
February 2016
IBM acquires Truven Health Analytics, adding more than 8,500 clients to the IBM Watson Health Portfolio, including US federal and state government agencies, employers, health plans, and hospitals.


October 2016
IBM acquires Merge Healthcare, embarking on a collaboration with IBM Research to teach IBM Watson how to “see.”


Since 1996, the attorneys at Patterson + Sheridan have successfully secured patents, trademarks, trade secrets, and other critical assets for exceptional technology innovators, ranging from start-ups to Fortune 100 companies.
Patterson + Sheridan is dedicated to maintaining excellent client relationships and delivering high-quality, cost-effective services. True partnership with our clients, coupled with experience and expertise, makes us the go-to firm for building, leveraging, and protecting a strong IP portfolio.
Vestagen Protective Technologies’ innovations raise the performance level of medical scrubs
By Jeff Silver
In the controlled chaos that can occur in hospitals, the staff’s first instincts are focused on maintaining patient care. That can be a problem if that staff has inadvertently been exposed to body fluids that have soaked through their scrubs, a recognized risk for healthcare workers.
Vestagen Protective Technologies is addressing the problem with its VESTEX Active Barrier apparel. Active Barrier apparel is designed as a replacement for traditional, everyday hospital attire and helps repel splatter and spills of fluids and other material. The fabric also contains an EPA-registered antimicrobial agent shown in laboratory and hospital settings to inhibit certain tested bacteria from growing on the fabric under the conditions of the tests. Neither liquid repellency nor antimicrobial tests are intended to assess the active barrier apparel’s ability to meet personal protective equipment requirements, and the ability of the fabric to reduce exposure or infections has not been studied. Additionally, this product does not protect users or others against disease-causing bacteria and must always be cleaned thoroughly after each use. Though the antimicrobial layer repels liquids, the scrubs remain breathable and comfortable.
“When worn regularly, VESTEX garments provide documented and reliable fabric protection,” says Marc Lessem, Vestagen’s chief
marketing officer. “They keep the uniform from absorbing fluids, which results in a more professional image due to fewer stains and odors, but also result in fewer germs on the fabric and less exposure for coworkers, patients, and loved ones at home.”
In fact, a study published in the Journal of Infection Control and Hospital Epidemiology found a reduction of Methicillin-resistant Staphylococcus aureus (MRSA) on VESTEX scrubs compared to standard fabric garments worn by a group of ICU healthcare workers. (The study did not assess the impact on healthcare-associated infection rates or test the fabric to establish the ability of the apparel to reduce disease transmission.) And although its findings cannot be generalized beyond the setting studied, the study did find that “when bundled with known infection prevention strategies such as hand hygiene, (VESTEX fabric) may limit the bacterial burden of the inanimate environment” and “may be a useful adjunct to other infection prevention measures.”
Lessem adds that the company’s scrubs are designed for combined use with existing personal protective equipment (PPE) used when fluid exposure is anticipated. In fact, Lessem compares routine, general purpose use of VESTEX attire to the way in which air bags complement seat belts for vehicle passenger safety.
“Our scrubs minimize the risks associated with unanticipated fluid exposures, but VESTEX is not a replacement for PPE,
which is the gold standard,” Lessem explains. “Our garments should be used together with PPE as an insurance policy in case of poor PPE compliance, improper PPE removal, or possible PPE failure.”
Vestagen began developing VESTEX in 2009. After extensive testing to identify the most effective fluid repellent and antimicrobial agent, a remaining challenge was making the fabric breathable. This was addressed by developing an application process that leaves the outward-facing surface resistant to liquid, but the inside (against the skin) surface still able to wick moisture away from the body.
That dedication and attention to detail is essential to the company’s manufacturing regimen. The chemistry formulation and application process alone requires weeks of effort. A robust quality assurance program also ensures formulation accuracy, application consistency, and postproduction durability and effectiveness.
VESTEX is available online, making them competitively priced. “Selling directly to customers enables us to offer added value for just a few dollars more than standard, untreated uniforms,” Lessem says. Several hospitals, such as Northwell Health in New York and Baptist Health System in Jacksonville, Florida, have provided VESTEX garments to their employees. This has helped address common strategic initiatives, such as employee satisfaction, which can have a positive spillover effect on patient satisfaction.
In one instance, Lessem anonymously approached a neonatal unit staffer to ask what the “V” on the sleeve of her scrubs stood for. He was thrilled when she demonstrated an extraordinarily high awareness of the VESTEX line. She told him the logo meant they were higher-quality uniforms that the hospital provided to help protect the staff—something which makes an impact on the patients and the community at large.
“Local media coverage typically generated by implementing VESTEX also enhances community relations and helps build a stronger hospital brand,” Lessem says.
In addition to lab coats and healthcare workers’ uniforms, Vestagen also makes patient apparel and is considering numerous customer-requested line extensions. Any such product expansion will have to meet rigorous testing to mirror real-world use patterns, just as current products are tested to show they maintain their performance and durability for up to fifty home washings.
In the meantime, Lessem says, the innovations that Vestagen has introduced empower healthcare workers—nurses in particular. “They are doing heroes’ work,” he says. “That creates a very satisfying sense of pride for all of us.” AHL
“We are focused on because we know the difference a
highly engaged workforce can have on patient care.” p. 182
BY JOSEPH KAY
Duke Health chief human resources officer Rhonda Brandon reveals the potential in others

“The best-designed mentoring experiences are like matchmaking: you have to make sure that the chemistry works.”
When Rhonda Brandon arrived at IBM in 1981 as a new college graduate, she noticed one executive who was always prepared, kept her cool, and effortlessly navigated conflict. She simply radiated confidence and competence. “She was adored by all, and I wanted to be just like her,” Brandon says. With so few female African American leaders available to guide their younger colleagues at the time, Brandon decided she had to have the woman for a mentor. Brandon worked up the nerve to walk into the executive’s office to ask.
“She looked at me, and I eagerly awaited her response,” Brandon recalls. “And she said, ‘I don’t do that.’”
Following that deflating moment, Brandon made two resolutions. First, she decided to become a student from afar. “I would find my way into meetings where she was going to speak. I watched her mannerisms, and I listened to her articulate tough subjects,” Brandon says. “She was always so graceful and, through practice, I learned to make many of these professional attributes my own.”
Second, Brandon decided that she would be different. If a young colleague asked her for mentorship, she would find the time to invest in them. This closely aligns with Brandon’s personal mission: to set the stage
so that others might shine. Since then, mentoring has become her passion, and she has developed a rich history of advising her employees.
For example, while working at a pipeline company in Atlanta, one of the few female engineers sought out Brandon for help. She wanted to trade in her engineering career to become a human resources professional. They made an instant connection. Together, they focused on transforming her professional presence; they collaborated on HR projects to expose her to the profession, and Brandon found opportunities to help her gain visibility with executive leadership. But the highly skilled engineer’s supervisors were hesitant to give her an opportunity in HR, arguing that she was already adding the best value to the company as an engineer. Brandon persuaded them that they needed to give her the chance, or else another organization would.
“I think I just wore them down,” she says. “I encouraged my mentee to share her own story with her leaders, and that was the compelling differentiator.” That young engineer eventually earned a position in HR and has enjoyed a spectacular career trajectory. She now serves as vice president of human resources at a large human resources management services company.
Another of Brandon’s mentees was recently awarded an expanded role. He came to her needing a listening ear and a wise word. As he shared his hopes, his fears, and what he considered his failures, Brandon revealed that she shared many of those same experiences. That, she says, unlocked a new perspective for him. He gained a new sense of his career’s possibilities. Now when they meet, she notes that he has a different energy and exudes increased confidence.
But Brandon doesn’t just help others succeed. She has accumulated her own impressive list of professional accomplishments throughout her career as well.
When Brandon arrived at her first healthcare organization in 2006, she realized that this industry tended to rely on traditional HR practices. She and her team members, many of whom came from other industries, encouraged the adoption of more contemporary strategies. With the healthcare industry undergoing profound, rapid, and unpredictable changes, advancing the approach to managing human capital is more crucial than ever, she says. “Our patients are sicker, regulatory measures have increased, the ACA has transformed the way we deliver care, and we must compete for talent differently,” she says. Because of the uncertain future of healthcare, Brandon has primed her current employer, Duke University Health System, to focus further on developing its talent, particularly its leaders. As part of a multiyear human capital plan, she is partnering with operations leaders to enhance the effectiveness of their leaders at all levels, and mentoring will be a key component of that strategy.
Although HR can offer an array of mentoring programs and processes, Brandon emphasizes that the tools and trappings of an institutional program are no substitute for
“They teach me, and they keep me young. They keep me in touch with what’s going on


























Outside the office, Rhonda Brandon and her husband uphold her personal mission by mentoring a twelve-year-old boy with Big Brothers, Big Sisters. The challenges their “Little” faces are rather different from what they experienced with raising their twenty-two- and twenty-nine-year-old children—but over the past four years, it’s proven to be one of her most fulfilling mentoring relationships.
“It’s about pouring goodness into another person’s life,” she says. It’s about lighting a path and inspiring greatness.”



genuine, organic connections between people invested in each other. “Sometimes when you put those ‘check-the-box’ programs in place, you’re not allowing those relationships to form organically,” she says. “The bestdesigned mentoring experiences are like matchmaking: you have to make sure that the chemistry works.” Mentoring programs provide clarity and structure, but they can’t replace the ultimate objective of awakening leaders to their potential and providing the guidance they need to fulfill it.
Brandon has enjoyed tens of mentoring relationships, some at Duke Health, and a number of other long-term connections from previous organizations. Her assistant often tells her that she doesn’t have time—there’s just no room on the calendar—but she makes sure to find space somewhere amid her other organizational priorities.
“This is a passion of mine,” she says. “I really believe I have added value to many in achieving their goals, and these same people have poured into me. They teach me, and they keep me young. They keep me in touch with what’s going on in our organization— and the world.” AHL

For BioMarin, a company that develops treatments for rare diseases, compliance is more than a legal requirement. Philip Lo Scalzo’s compliance awareness campaign is redefining the department to emphasize integrity along with innovation.
BY GALEN BEEBE

arly in Philip Lo Scalzo’s career, when he was working as a legal intern at Pfizer and attending law school at night, he was standing with a group of lawyers when someone cracked a lawyer joke. “One of the older, wizened, white-haired attorneys really had a visceral response to that,” Lo Scalzo says. “His attitude was, ‘This is our profession, and when we belittle it like this and allow these jokes to metastasize in society, it erodes the confidence and credibility in our profession.’”
Lo Scalzo says he feels similarly about the idea that compliance officers police the organization. As senior vice president and chief compliance officer at BioMarin, a biotech company that develops treatments for ultra-rare diseases that primarily affect children, Lo Scalzo has worked hard to redefine the role the compliance department plays in an organization. “People don’t like people telling them what to do,” he explains. “If they think you’re the company cop or are going to have a binary position of whether a certain issue is right or wrong— and that if you do wrong you’re going to get in trouble— they’re not going to trust you or be transparent with you.”
Instead, Lo Scalzo says compliance professionals are like doctors but for a company. His team goes out and assesses risks for the organization. Compliance officers look into what could potentially make the organization ill and help find the
right prescription. Like doctors, the compliance team has to gather information from its patient. “We can only make good decisions if people are providing us with real, honest information—transparent information—with which we can make such a decision,” he says. “We can’t analyze what’s not in front of us.”
In 2015, Lo Scalzo began a compliance awareness campaign with the aim of bolstering employees’ understanding of the value of compliance. “I learn a lot from my commercial colleagues on how we sell our products and our business,” Lo Scalzo says. “We’re trying to sell the value of proactive compliance.”
As part of the campaign, the compliance department hired commercial videographers to make a short video explaining BioMarin’s commitment to compliant and ethical behavior and illustrating what the compliance department does to help ensure that commitment is met. They then premiered the video at an all-hands meeting and went around the globe and presented it to BioMarin teams.
In part, the video explains the department’s three functions: internal audit, healthcare compliance, and GxP, which stands for good X practices. In pharmaceuticals, the X stands for good manufacturing, laboratory, clinical, vigilance, or distribution practices. Subject matter-specific auditors audit both BioMarin and its vendors in those areas.
“You don’t have to make wholesale changes often to make a program more compliant or risk-tolerant . . . The only way compliance professionals can recommend appropriate alterations is if they understand the business.”
In building the compliance department, Lo Scalzo combined the existing GxP auditors from around the company and developed the healthcare compliance and internal audit functions from the ground up.
In many publicly traded companies, the internal audit function falls within the finance department. However, BioMarin created an independent audit department to alleviate any concerns around conflicts when that function audits financial controls, among other things. “The theory was to get a group in the company to oversee compliance and audit activity independent of operationalizing anything,” Lo Scalzo says. “So we brought internal auditors together with our healthcare compliance and GxP auditors. Some thought putting CPAs on a team with lawyers and scientific auditors was crazy, but we thought it would generate synergies, and it did.” Along with compliance issues, the internal audit function works to make BioMarin more efficient. By helping the business increase efficiency, he says the audit function is able to sell its value beyond its traditional role of identifying and remediating risk.
Although policies and procedures are important, building trust among departments is paramount. Lo Scalzo describes the traditional compliance model as a game of whack-amole, where compliance officers knock down issues as they see them. If this is the outlook, he says, people are not going to turn to compliance ahead of time and will instead ask for forgiveness after something happens, which increases the company’s risk. “By building trust with our colleagues, we are able to promote a partnership that allows us to identify risk early and allow the company to act proactively toward compliance risk,” Lo Scalzo says.
The compliance awareness campaign encourages employees to bring questions before they become problems, so the business can adjust course accordingly. Lo Scalzo likes to compare it to sailing. “A one- or two-degree tack in your positioning takes you to a different destination,” he says. “You don’t have to make wholesale changes often to make a program more compliant or more risk-tolerant. A lot of time it’s just slight alternations. But the only way compliance professionals can recommend appropriate alterations is if they understand the business, and the only way to truly understand the business is to build strong cross-functional relationships.”
The compliance department’s tagline is “Innovation Powered by Integrity,” but Lo Scalzo says BioMarin is also
powered by hope. “It gives hope to these families when they get this unbelievably terrifying news that their child has been diagnosed with a one-in-a-million disease that many people have not heard about, often even their pediatrician,” Lo Scalzo says. “In the ultra-rare disease space in the United States, it is not uncommon for us to get to know the patients and caregivers who use our products, as the numbers are so small. They reach out to us. We know their family stories. We get letters and Christmas cards from these families. We look at the photos of the children and the families when we walk in the door. We can feel the hope we bring to these families’ lives. That drives a lot of us, and it definitely drives me. It’s the proudest I’ve ever been representing an organization.”
Since Lo Scalzo launched the compliance awareness campaign, every employee has seen the department’s video, in which senior team members emphasize the weight of BioMarin’s mission and the role compliance plays in it.
“It is crucial,” Lo Scalzo says, “to have believers from your board to your CEO down through your organization to say, ‘We’re going to be highly innovative, we’re going to be creative, we want to be impactful and make deep differences in these patients’ lives—but we’re going to do it appropriately, compliantly, and with integrity.” AHL
In 2011, Elegrity and BioMarin partnered to innovate the pharmaceutical’s multistep and cross-departmental grant submission process, and later, the firm’s independent research program. The collaboration resulted in two workflow applications that delivered on BioMarin’s goals of stronger compliance, accuracy, and auditability and positively contributed to the company’s compliance awareness program.
PwC has been honored to be a valued business partner to Philip Lo Scalzo and BioMarin, bringing our leading life sciences strategy, operations and regulatory services to help BioMarin achieve its strategic goals. For more information on how we can help you, visit pwc.com/us/pharma.
Symbiotix applauds the unwavering dedication and insight of Philip Lo Scalzo, one of this year’s AHL leaders. His passion and commitment worked to activate possibilities for patients and caregivers through important and meaningful education. We look forward to future collaborations that will continue to lead the way in the industry.

PwC congratulates Philip LoScalzo for the recognition of his accomplishments in American Healthcare Leader magazine. As a global leader for Pharmaceutical, Medical Device and Life Sciences Risk Consulting, PwC combines industryfocused compliance strategy and operations to help organizations become more efficient, agile and resilient balancing risk in today’s evolving healthcare environment. Visit us at pwc.com/us/pharma



















Unlocking the power of Scientific Activation requires unwavering commitment and passion, and Symbiotix is proud to salute Philip for having an abundance of both.
His unwavering dedication, insight, and collaborative spirit have been key to our long-standing relationship with BioMarin. Together, we have created inspiring and motivating engagements with patients and caregivers that have activated possibilities and gone beyond the expected.





Elegrity Provides Healthcare Solutions That Help Compliance Executives Manage Risk While Fostering Growth
Elegrity provides workflow and compliance tracking systems that allow executives to codify and automatically enforce key compliance policies. The solutions raise needed visibility to compliance-related issues and related monetary implications. As a natural byproduct, compliance executives enjoy automatic auditability and defensibility and garner new capabilities to learn from powerful business analytics.
You consider us a partner in your success as we all work together to drive growth while managing risk.
We deliver a solution customized to your needs.
Your new system adapts and grows along with your company.
You own your system.
Tressa Springmann, senior vice president and chief information officer for LifeBridge Health, manages both technology and the people who depend on it
BY DAVID LEVINE
Tressa Springmann knew early on that life in the lab did not suit her personality. After graduating from St. Mary’s College of Maryland with a bachelor’s degree in biology, she landed a job conducting research at John’s Hopkins University. “I liked the scientific rigor, but I hated the social aspects of it,” she says. “I am a more social creature than the lab afforded me.”
Springmann preferred human interaction to head-down lab work, so she switched gears and got into healthcare IT. Now, as senior vice president and chief information officer for LifeBridge Health, a multifacility network in the Baltimore region, she combines the science of technology with the people skills of management.
Born into a military family that traveled every few years, Springmann became interested in IT when she implemented a new computer network at her lab job. That time spurred her to go back to school to earn an MBA at Johns Hopkins. “It focused on managing technical people,” she says. “I crossed the divide from researcher to more of a computer science wonk.”
Springmann first entered the healthcare space as a project manager at Electronic Data Systems. Other IT positions followed, and when LifeBridge’s retiring CIO called her, she was vice president and CIO for Greater Baltimore Medical Center in Towson, Maryland. “She asked me to consider taking her job, but I thought she was kidding,” Springmann says. “Then, three months later, she chastised me for not applying. So I did. I wasn’t anxious to leave my job, but I was intrigued by the possibility of being in a more complex environment. I am really glad I made the call.”
Since it was founded, LifeBridge Health has grown to include Sinai Hospital of Baltimore, Northwest Hospital, Levindale Hebrew Geriatric Center and Hospital, Courtland Gardens Nursing & Rehabilitation Center, and their subsidiaries and affiliated units, including LifeBridge Health & Fitness and three LifeBridge Medical Care Centers. Much of that growth has happened recently, and as a result, Springmann’s focus is on orchestrating growth in a varied computing environment. “One of our strategic pillars is to grow scale,” she explains.
In that role, her sociable personality and interest in management really come into play. She has found that integrating the technology is not as complex as integrating the people who run it. “When we acquire or partner with another entity, we spend a lot of time on cultural differences,” she says. “Moving to our platforms hasn’t been as complex as harmonizing the different organizations’ cultures.”
That’s not to say that IT isn’t an issue whenever she oversees migrating a newly acquired hospital or provider group to the LifeBridge system. “Whenever we go through an M&A activity, that presents potential opportunity elsewhere,” she says. “We may have systems we have to retire, so system selection and implementation while we sunset legacy systems are an essential element of a new acquisition.”
In addition to integrating new acquisitions into the organization, LifeBridge also has many ongoing information services projects. Springmann believes in letting her direct reports manage the day-to-day. “I make myself available to those leaders so that any barriers to their success get dealt


Change Healthcare is a key catalyst of a valuebased healthcare system.
We deliver wide-ranging financial, operational and clinical benefits to payers, providers and consumers through our broad portfolio of solutions to help:
• Lower healthcare costs
• Improve patient access and outcomes
• Manage the transition to value-based care.
“I am a relationship person, focused on trying to find common ground and using dialogue and data to strike at common goals.”
with,” she says. “A priority for my time is being accessible to my direct reports, getting them what they need.”
As part of a new initiative at Lifebridge, she also spends time working on the company’s new bioincubator, which looks at intellectual property developments in the IT space. Other parts of her day are spent identifying new partners to help meet IT needs and developing an operations excellence program based on the Lean Management System. In all of her work, Springmann applies her natural analytical skills. “I like the deductive reasoning that scientists apply, which I was exposed to as an undergraduate,” she says. “I have brought that to the business world. But I am also very collaborative. I am a relationship person, focused on trying to find common ground and using dialogue and data to strike at common goals. I still enjoy planning and analysis, but if ideas are not able to be applied, what good are they?”
Comfort with change and an eye on innovative thought are particularly important now because healthcare is at a technology crossroads, she believes. “Automation is here to stay, even though it can sometimes be an impediment to the most efficient workflows in healthcare,” she says. “We are still in the early generation of tools that providers use in what is still a super-high-touch industry. We have hit an inflection point. Now, these workers are knowledge workers as well as high-touch workers. Technology affords a gateway of opportunity to provide care, but we have to unlock that while making it easier and more efficient for them.” AHL
Change Healthcare is inspiring a better healthcare system. Change Healthcare is a key catalyst of a value-based healthcare system—working alongside our customers and partners to accelerate the journey toward improved lives and healthier communities. While the point of care delivery is the most visible measure of quality and value, we are a healthcare technology solutions company that uniquely champions the improvement of all the points before, after, and between care episodes. With our customers and partners, we are creating a stronger, better coordinated, increasingly collaborative, and more efficient healthcare system that enables better patient care, choice, and outcomes at scale.
BY KASEY CHEYDLEUR
Gary Rakes is using his role in supply chain to improve clinical quality and patient outcomes, thus reducing costs for Aspirus
y putting the patient at the center and centralizing management, Gary Rakes is transforming the supply chain at Aspirus and changing lives.
Gary Rakes discovered the healthcare supply chain because he wanted to serve his country. His father and three of his uncles served in the navy, and when one suggested the Navy Medical Service Corps, Rakes realized it was the perfect opportunity to balance his patriotism with his desire to serve people. Thirty-four years of healthcare experience later, Rakes says he has enjoyed every minute and has never considered doing anything else.
That service mind-set is still clearly at the center of Rakes’ vision for Aspirus, and every supply chain decision is made with patients’ best outcomes in mind. Located in North and Central Wisconsin and Michigan’s Upper Peninsula, Aspirus is a regional healthcare leader that comprises eight hospitals and more than fifty clinics. When Rakes joined the company a year and half ago, his first goal was to centralize the supply chain system and leverage its advantages to drive down costs.
“Everything else is secondary to providing great patient care to those we serve.”
While other teams might bond over an activity like bowling, the supply team at Aspirus has bonded over something rather unusual: picking up trash. At least four times a year, they can be seen picking up plastic bottles and old tires along the two-mile stretch of highway they adopted. Rakes says they arrived at the idea when looking for ways to give back. “My Aspirus supply chain team is really committed to service and giving back to the communities in which we live,” Rakes says. “The idea of adopting a highway was a fun way for many team members to participate by providing meaningful volunteer service that keeps our community clean and trash-free.”
“When I walked in the door, we were operating as a loose confederation of hospital supply chains, each performing as a separate entity with little collaboration and system-wide integration,” Rakes says. “What I tried to do was develop a system-wide supply chain structure and strategy, with system leaders managing specialized supply chain functions for the entire health system.”
Instead of the old model, where every supply chain employee was a jack-of-alltrades, Rakes wanted his team members to focus on their passions and strengths. He appointed three system supply chain leaders to manage specific system-wide areas of focus: strategic sourcing, procurement, and value analysis; inventory management, operations, and logistics; and informatics and business intelligence.
Rakes says that when he’s building that team he’s looking for people who see healthcare as a calling and not just a profession. As a leader, it is his job to nurture that passion. “Take the time to invest in their lives, their education, their training, and genuinely care about them, and they will in turn be extremely high-performing team members who also care about their job and those they serve,” he says.
In addition to the changes made to personnel, Aspirus has also found significant cost savings through its active participation in a regional purchasing aggregation group that comprises sixty-five other like-minded health systems. Using its robust contract portfolio and aggregating its collective spending, the group has been able to drive national best
pricing in not only commodity and clinical preference products, but medical devices as well. Rakes says that typical contract savings under this aggregation group were more than 23 percent in 2016.
The effects of these changes, combined with some newly acquired automated pricing tools, are starting to emerge. Aspirus is ranked fifth nationally in overall pricing index within their peer group, moving from an index high of forty-three in January 2016 to thirty-six in October of 2016. They also ended 2016 ranked fifty-seventh nationally among more than seven hundred health systems in regard to key performance metrics related to: price, unit of measure, inventory discrepancies, number of automated purchase order trading partners, and gross transaction volume per licensed bed. For its focus on contract compliancy and system standardization strategies, Aspirus was one of 152 companies recognized with the Supply Chain Executive Savings award and one of 111 to receive the Participation Leader award in 2016 out of 5,300 competing members.
Although he is focusing on cost reduction, Rakes is careful to never lose sight of his top priority: the patients. “Everything else is secondary to providing great patient care to those we serve,” Rakes says. “Our supply chain must serve as an enabler to that vision as we focus on bringing products that not only lower our operating costs and improve our financial margins, but also enhance clinical quality and patient outcomes.” He explains that his role is all about achieving balance. “In the end, supply chain professionals have to be able to balance cost improvement, clinical quality, and patient outcomes and work at the intersection to bring balance to the patients we serve,” Rakes says. Finding that balance includes looking beyond immediate cost-saving measures to strategies that could reap benefits longterm. “I am a big advocate of the belief that if we improve clinical quality and patient outcomes, it will have a significant impact on reducing our overall costs,” Rakes says. “It might not come in the form of reduced medical product cost, but if we can be a positive contributor to reducing hospitalacquired infections, improving length of stay, or reducing cut-to-close time in surgery, it will have a positive impact on our financials.“ AHL


BY DAVID LEVINE
Vice president of business affairs Sharon Zehe oversees Mayo Medical Laboratories’ business growth around the world and stays abreast of trailblazing technology in the laboratory medicine industry
Say “Mayo Clinic” almost anywhere, and most people will know that you are referring to one of the world’s best-known healthcare brands. The institution is one of the largest healthcare providers, offering a number of services that—though they get less press than its hands-on, team-based model of patient care—make a big difference to the health and well-being of patients around the globe. One of those services is clinical laboratory testing, and Sharon Zehe is part of the team charged with bringing those laboratory services’ best practices to other parts of the world—and to the new frontier of personalized medicine. Mayo Medical Laboratories (MML) is a for-profit arm of Mayo Clinic that performs everything from basic blood tests to cutting-edge genomics testing. The global reference laboratory operates within Mayo Clinic’s Department of Laboratory Medicine and Pathology and provides clinical laboratory testing to support healthcare systems, hospitals, specialty clinics, and other clinical laboratories—currently about four thousand clients in more than seventy countries. Zehe oversees MML’s business growth around the world and stays abreast of trailblazing technology in the laboratory medicine industry. “MML is our outward-facing laboratory, performing testing for medical groups from around the globe,” explains Zehe, the vice president of business affairs. “We also provide laboratory services for millions of patients who come to Mayo Clinic every year through our Department of Laboratory Medicine and Pathology.”

of Business Affairs
Zehe is in charge of both sides of the business, overseeing regulatory and compliance issues and participating in business strategy and outside collaborations. “In this role, I function as more than just a lawyer,” she says—though that is how she began her career in healthcare. A native of Wisconsin, Zehe worked in human resources before earning her law degree from William Mitchell College of Law, now called Mitchell Hamline School of Law, in St. Paul, Minnesota. Zehe got to know Mayo Clinic through outside counsel work, and when an opening came up to support the laboratories, she applied for and was offered that position. Zehe came in as a business lawyer in 2004. “They originally needed help with just contracting and business strategy, but over the years, my role has grown to support all the needs of both the external and internal practices,” she says.
Zehe’s current top-line challenge is bringing laboratory best practices to bear as Mayo expands its model of care to other parts of the world. Currently, physicians and medical clinics send samples to Mayo’s reference laboratory, which is headquartered in Rochester, Minnesota, for testing. “We have a fairly significant footprint in the Middle East, South America, and Mexico,” she says. “We are not as big in Europe or Asia, but we are trying to grow there.” But in those and other parts of the world where it is impractical or illegal to send samples to the United States, Zehe is helping to set up collaborations with facilities in those countries. “We want to bring the Mayo testing model to these healthcare providers and work with their physicians and scientists to show them how we do it here,” she says. The team is also in discussions with facilities in Canada and South America, but they are not as far along in the process as Europe and Asia.
Mayo has also developed a Center for Individualized Medicine to advance the science of genomics testing to create personalized treatment plans for each patient’s particular disease genotype. “The big question is, ‘How do we take each individual’s genetic makeup and customize treatment for that person so it’s more effective?’” Zehe says. One such collaboration involves the Baylor College of Medicine and OneOme in the RIGHT 10K study to sequence seventy-six pharmacogenes samples from ten thousand patients who receive all of their healthcare at Mayo Clinic. Results and an interpretive report will be loaded into each patient’s EMR to improve healthcare by using already-installed clinical decision support alerts for nineteen different druggene pairs and evaluating the clinical and fiscal impact of those alerts. “The RIGHT 10K study is working to help providers understand what pharmacogenomics is,” Zehe says. “Pharmacogenomics can be quite big, and to ask physicians to stay on top of all this is overwhelming. This study hopes to help educate physicians and pharmacists on how a patient’s genome affects how certain prescription medications can be prescribed to ensure the greatest effectiveness.”

“I want to keep an open mind that what was done before is not necessarily the way we move forward in the future.”
Joe Kane
Zehe’s challenge is to help facilitate these strategic advancements while making sure the organization remains flexible to compassionately and respectfully care for patients and respond to the changing industry. “We have the practice side of Mayo, taking care of patients every day, and that never wavers. That part is huge, and it’s the reason we are here,” she says. “Our physicians see what patients need, and they tell us what the laboratory needs to develop to support these patients.”
Patient privacy is also top of mind. “My soapbox on personalized medicine is on protecting patient privacy,” she says. “To perform research on the way our environment, our lifestyles, and our genes affect our health, organizations need to collect a significant amount of information. Mayo does a great job of letting patients know how this information may be used.”
With all of these different projects and collaborative processes, Zehe truly appreciates the pace and variety of her job. “Some of these collaborations move extremely fast,” she says. “Different parts of the world have different issues to address. I really enjoy the learning experience of it.” In addition, she says that the law is far behind where medicine is. “It is an interesting dynamic to say, ‘Here are the legal parameters, but they haven’t caught up with how laboratory tests or precision medicine works now.’ But we have to work with that going forward to always do the right thing for patients.”
One of Zehe’s goals, in fact, is to stay on top of genetics and personalized medicine. The two areas are really intertwined as one, she says. Zehe’s other goal, concerning overseas growth, is to find creative new ways to strike collaborative business deals. “I want to keep an open mind that what was done before is not necessarily the way we move forward in the future,” she says. AHL
OneOme ’s RightMed® pharmacogenomic test, codeveloped by Mayo Clinic, helps providers improve patient care by using a patient’s DNA to predict how he or she may respond to medications. The RightMed test has the potential to limit adverse reactions and improve the economic efficiency of healthcare systems. Learn more at oneome.com.

Make more informed prescription decisions with the RightMed® pharmacogenomic test, co-developed with Mayo Clinic.
Daniela Crivianu-Gaita—chief information officer of Dynacare, a subsidiary of global life sciences company LabCorp—strives to unite technology and healthcare services to create something unique
BY DAVID LEVINE
Finding your passion in life comes at different times for different people.
Growing up in Romania, Daniela Crivianu-Gaita pursued a degree in computer software engineering but had no clear idea what to do with it. She held a variety of jobs, some in the IT space as a systems analyst and others in purchasing. During a stint with an IT consulting firm, she found herself working with a large academic hospital. “I discovered healthcare and absolutely fell in love with the field,” she says. Now, as CIO of Dynacare, a laboratory service provider that is transforming into a health and wellness solutions company, she is helping shape the future of healthcare through technology.
The industry appealed to Crivianu-Gaita immediately. “You can help people and make a real difference in their lives,” she says. “You sense it more than in other industries.” She also was attracted to the somewhat contradictory nature of technology and healthcare. “IT is structured. It’s black and white, while in healthcare, each care interaction is unique,” Crivianu-Gaita says. “I was fascinated by the challenge of meeting the unique needs of healthcare with the structure of IT. I wanted to be a part of creating something unique.”
Crivianu-Gaita began working for the hospital full-time. However, in 1998 she and her husband and son immigrated to Canada. “We wanted more professional growth opportunities, so my husband and I decided to move,” she says. CrivianuGaita was hired at The Hospital for Sick Children (SickKids) in Toronto, where she helped to set up the hospital’s diagnostic imaging information systems and then became involved in an increasing number of enterprise-wide projects. She eventually became the hospital’s chief information officer and vice president of information management and technology.
Happy in her work and not looking to change jobs, Crivianu-Gaita nevertheless came across an opportunity to join Dynacare. “I came for an interview and learned about the company’s fantastic vision,” she says. “Dynacare wanted to transform itself from a traditional lab company into a health and
wellness solutions leader that improves the lives of all Canadians. That sold me.”
In her three years with the company, Crivianu-Gaita has helped make much of that dream a reality. The company has grown and diversified and now does specialty testing in genetics and forensics, mobile services, and paramedical services. As CIO, she oversees about eighty-five people in her portfolio, which is divided into four verticals. Core IT handles infrastructure, databases, data storage, and the like. Digital Solutions and Integration Services teams design, develop, and implement software solutions. Informatics Solutions and Services are charged with gaining insights from data. Finally, the Project Management and Resource Planning vertical addresses how the company approaches initiatives to help deliver on its projects.
Crivianu-Gaita’s major focus currently is supporting the company’s vision and mission through the acquisition, design, and implementation of innovative IT solutions. “We’re taking Dynacare to the next level of digital technology,” she says. “The strategy of the company includes evolution, transformation, and growth. We’re creating new technology, digital solutions, and services to achieve this.”
Supporting the company’s vision and mission also means engaging with customers differently, by merging their physical presence with a digital presence. “A big focus for us is digitizing both our internal and external processes in order to provide an amazing customer experience,” CrivianuGaita says. That includes eliminating any paper and manual processes and moving to electronic data collection in business-tobusiness services. It also means focusing on offering mobile applications that allow customers to make appointments and check wait times online. “We have a number of new apps that enable customers more flexibility and choice,” she says.
As a leader, Crivianu-Gaita says she believes in transparency. “I communicate with my staff as much as possible to ensure they understand our organizational direction and how their role contributes to it,” she explains. “They can then respond to


Powua is a platform that can enable automated provisioning of services, software and infrastructure from the Public Cloud, Private Data Center or On-Premise locations.
Monitor, streamline and centralize your complex IT environment by offering self-serve SaaS/IaaS solutions to your internal or external user base via the Market Place. Learn more at Powua.com
business needs more easily.” She continually brings employees from other business units in to present to her staff and expose them as much as possible to the business side of the company.
Mentoring is important to her as well. “I like to help people grow personally and professionally,” she says. “I offer to coach and mentor people, and many take me up on that. I was lucky to have mentors, and I want to help as others have helped me.” On her horizon, Crivianu-Gaita wants to take Dynacare to new levels of expertise in the areas of informatics and analytics. “The more technology advances, the more data we have available to us,” CrivianuGaita says. “We are trying to make sense of that data and provide insights to our clients and customers.” A recent project incorporated artificial intelligence tools to mine data from histology reports and create statistical information for gastrointestinal clinics. “The clinics no longer had to complete this manually, so it was very well received,” she explains. Even after twenty-seven years in healthcare, Crivianu-Gaita still feels the passion she felt when she first worked for that hospital in Romania. “I still love what I am doing, and I still love healthcare,” she says. “I come to work with joy. After this long in an industry, sometimes you can get bored, but I don’t. It is always dynamic and evolving. It keeps me motivated.” AHL
Beckman Coulter Diagnostics DxONE is a portfolio of informatics solutions that empowers laboratories to do what they do best: make a difference. It’s all about standardized processes, optimized workflows, impactful analytics, and streamlined inventory management to ensure fast, accurate results that support better patient care. When essential manual tasks within a laboratory are efficiently automated, skilled staff can dedicate themselves to the high‐value work that moves healthcare forward. For more information, visit beckmancoulter.com/dxone.




© 2017 Beckman Coulter, Inc. All rights reserved. Beckman Coulter, the stylized logo and the Beckman Coulter product and service marks mentioned herein are trademarks or registered trademarks of Beckman Coulter, Inc. in the United States and other countries. For Beckman Coulter’s worldwide office locations and phone numbers, please visit www.beckmancoulter.com/contact AD-30022




BY DAVID BAEZ
When people think about health at a hospital, their first thoughts naturally gravitate to the sick patients being treated by nurses and doctors—but there can be many interpretations of what health means. At Carolinas Healthcare System (CHS), a nonprofit healthcare network serving the Southeast, senior vice president in human resources Mick Fisher has made it his mission to maintain the health of the organization’s employees, something that inevitably trickles down to the hospital’s clients.
When Fisher talks about health, he envisions three pillars: physical, financial, and emotional. He asserts that all three must be in place for employees to thrive and bring their best to the organization, just as the organization brings its best to them. “You take any one of those pillars out of the picture and your experience will not be what you would want,” Fisher explains. “We feel it is a shared responsibility between the organization and the teammate.”
Fisher spent twenty-five years at the same retail company before deciding to make a move to healthcare. The decision had been a long time coming, but the clincher came when Fisher saw all the people who came to honor his father, a Methodist minister, at his retirement ceremony. Numerous people from all of the churches Fisher’s father had ministered over the past four decades came out to honor him.
“Seeing all those people show up to recognize my father had an impact on me,” Fisher says. “It put his career in pretty stark contrast with mine, working in for-profit. I decided I wanted to use my expertise in HR to serve something with more intrinsic value.”
Thinking at first about the nonprofit sector in general, Fisher eventually settled on healthcare because the field would give him a chance to use his skills. CHS’s mission—to improve health, elevate hope, and advance healing for all—made it seem like the perfect place. “We accept all patients regardless of their background or ability to pay,” Fisher says.
Despite the obvious differences between retail and healthcare, Fisher felt that the HR principles in both fields were similar. One notable difference was that the multitude of roles at CHS was ten times the number in his previous organization.
Once he got his bearings, Fisher and his teams began to implement a plan of wellness for employees. Part of his job is to administer benefits that include salaries and health and retirement plans. But those benefits won’t serve their purpose, Fisher says, unless the team members gain knowledge about preventive health and become proactive in their own physical, financial, and emotional wellness.
To that end, Fisher has taken on the role of educator, working to coach and influence behavior. A lot of these efforts take the form of employee engagement initiatives. His teams began voluntary financial education classes that attracted fourteen thousand people in the initiative’s first year, with topics ranging from basic budgeting to retirement planning. To help with the physical aspect of wellness, the company holds walks at lunchtime and on Saturdays during which team members mingle with company leaders and get their hearts pumping. There are also intramural sports leagues and fitness-in-thepark days. The activities are wildly popular: CHS has been in the 75th percentile of employee engagement in the industry for the past seven years.
“We have a huge number of engagement initiatives across HR and CHS,” Fisher says. “We are focused on teammate engagement because we know the difference a highly engaged workforce can have on patient care.”
The third pillar, emotional health, is often overlooked, though Fisher feels it is equally important. There is a strong relationship between financial, physical, and emotional health, Fisher explains. Issues with finances or physical health problems can easily take a toll on one’s emotional health. “It is this relationship that drives our focus on activities to support healthy diets, fitness, and financial education,” he says. “We also feel it important to let our teammates know they are appreciated. I have great partners

President,

Mick, you connect teammate well-being, patient satisfaction, teammate engagement and organizational success. That’s not the only thing that’s made you a respected HR leader among U.S. health care organizations. You are also admired for how you have coupled that insight with decisive, industry-leading action – and results – in workforce wellness.
Willis Towers Watson is honored to partner with you and your team.
Willis Towers Watson Together, we unlock potential.
willistowerswatson.com




“We are focused on teammate engagement because we know the difference a highly engaged workforce can have on patient care.”
within the HR team that organize multiple recognition events throughout the year to let teammates know they are valued.” Every Monday, they send out an inspirational e-mail that isn’t related to business, and there is also an e-card program that gives team members the ability to send happy birthday notes, thank-you notes, and notes of congratulations. The forum is used by tens of thousands of team members.
“The key is that we have multiple ways teammates can connect with each other, with the organization, and with their leaders, inside and outside of work,” Fisher says. “They aren’t high-cost activities, but they drive engagement.”
All of this helps to bring HR out of the bureaucratic, administrative realm and into a more meaningful role that actualizes the reasons Fisher made the move from retail: to contribute to a humanistic enterprise.
“Being on the total rewards side, the way we design and administer benefits can help influence behavior to improve health, to pay attention to financials, and to maintain a good emotional state,” he says. With those three pillars in place, HR at CHS is standing on a solid foundation. AHL
At Bank of America Merrill Lynch, our mission is people-centric, helping individuals and companies pursue health and financial wellness. Working with employers through a strategic combination of benefits design, educational outreach, guidance, and support, together we can help employees create better money habits, gain confidence in their financial decisions, and build the financial security to help them become both “physically and financially fit.” We connect what is important to employees, considering their life priorities and goals, along with the knowledge, tools, and support they need to empower them to find financial balance and equip them to succeed.
How Hartford HealthCare’s executive vice president and chief administrative officer has made her mission into her career
BY MARY KENNEY
Hartford Hospital, the first hospital in what would become Hartford HealthCare’s network, was founded more than 160 years ago. It’s an organization and industry steeped in tradition, but Hartford is anything but stagnant. “We spend a lot of time building our culture here,” says Tracy Church, executive vice president and chief administrative officer at Hartford HealthCare. “We’re constantly working to infuse practices that help us develop the organization and the transformation we’ve been undergoing.”
To understand Church’s practice at Hartford and her reasons for staying in the healthcare industry, it’s important to understand what drew her to human resources in the first place. Church is the oldest of four children, so she found that caring for others was her calling in life early on, she says. When she was a freshman in high school, her father passed away. “My brother, the youngest, had just turned five. My dad was thirty-eight,” she says. “It was a traumatic event for my siblings and mother. I’m not sure if she has ever recovered from that, if anyone could.” Her father’s passing thrust her into a leadership role at home.
Church, who was the first in her family to attend college, found that the leadership skills she’d practiced in her family could easily translate to her professional life. After working in insurance and benefits consulting after graduating from college, she eventually took a job in human
resources. After obtaining a master’s degree in organizational management, Church turned her focus fully to human resources in the healthcare industry and has never wanted to leave since.
Church joined Hartford HealthCare six years ago as a senior vice president and the organization’s chief human resources officer. It was the logical next step in a career that, even as it spanned more than three decades, had always focused on human resources and healthcare. “I’ve worked for many types of organizations, but I’ve always stayed in healthcare,” she explains. “I’m called to help people, and I want to spend my career helping people who help people.”
Church describes herself as a generalist and says this is why she is successful in her current role. She compares generalists and specialists using the analogy of a ruler. “Balance it on its long edge, and it’s one inch deep and twelve long. That’s a generalist: someone who knows many different things, but only to a certain extent,” she says. “Now, balance it on its short end. Now it’s twelve inches deep and one wide: a specialist, who has a very deep understanding of one subject area.”
Church’s role, however, brings in partner relationships, project management, and many more areas of practice. “I have to be a generalist,” she says. “But the people I work with, many of them are specialists. For example, my leadership vice president knows a lot about one subject. I can’t ask him about compensation, but I can ask him to go into depth about leadership strategy. That’s what I need.”


important work.”
“That’s how we’re making this change initiative happen: by a thousand tiny steps, we move mountains.”
To that end, Hartford recently hired its first chief experience officer, a key voice in building the organization’s culture. A healthy culture will lead to better customer experiences, Church adds. She oversees the chief experience officer along with another executive. Together, leadership is building the kind of networkwide culture that will lead to better and more comprehensive healthcare across the board. That’s the kind of result that Church has always sought in her human resources practice. “I moved from San Francisco to Connecticut for this role,” she says. “And my instincts were spot on. This is the most passionate group of professionals I’ve ever been privileged to be a part of. They’re individuals of integrity, they hold themselves accountable, they constantly give feedback, and they always have an eye toward helping people improve and succeed. And that’s how we’re making this change initiative happen: by a thousand tiny steps, we move mountains.” AHL
















If your actions inspire others to dream more, learn more, do more and become more, you are a leader.


~ John Quincy Adams



Hartford HealthCare offers gratitude and congratulations to Tracy Church, our executive vice president and chief administrative officer. You represent everything a leader should be. And more.
Thank you for bringing our values to life, and for your vision, commitment and inspiration.
Joline Treanor—former senior vice president, chief human resources officer at St. Joseph Health—played a significant role in the creation of Providence St. Joseph Health, the third largest health system in the country

BY DAVID LEVINE
Joline Treanor isn’t afraid to put the greater good above her own ambition. And that’s exactly what she did at St. Joseph Health, essentially eliminating her own position at the company in the process. And she’s OK with that. Treanor, former senior vice president, chief human resources officer at Irvine, California’s St. Joseph Health System, was instrumental in the integration and strategy work that brought the organization together with Providence Health & Services to become what is now known as Providence St. Joseph Health. Mergers and integrations often create position redundancies that impact some people during the company’s transition. In the case of the St. Joseph’s merger, Treanor ended up being one of the people who would be impacted.
“As the organizations were coming together, I knew early on that there would be a need to look at all available synergies; it’s the right and prudent thing to do,” she says. “You can’t have two CHROs, and my Providence counterpart is an accomplished, brilliant woman, sure to do great things. I leave encouraged about their future and with great relationships with colleagues and friends.”
This merger is just one example of the changing landscape in healthcare. Convergences are occurring throughout the market. “It is a turbulent time in healthcare, and certainly one of change, ambiguity, and uncertainty,” she says. Indeed, change and uncertainty are what Treanor loves most, which partially explains why she entered the healthcare space in 2014. Originally from Colorado, Treanor earned her BS in industrial organization psychology and her MA in education technology at San Diego State University. Her professional experience has included positions with Digital Equipment Corporation, Compaq Computer Corporation, and Apple. She then worked at Deloitte Consulting for fourteen years, where she served as an advisor to clients across a range of industries covering subject areas such as
business strategy, operations, technology adoption, and human resource strategy, design, and transformation. While working at Deloitte, Treanor worked with St. Joseph Health on its HR transformation initiative. Needing a full-scale transformation, she revised policies, processes, and organizational structure in preparation for the implementation of new HR technology. “It was an antiquated system,” she says. “We were structuring HR to be more cost-effective and more aligned with the employee experience.” In this advisory role, she realized she wanted to work for St. Joseph because of its mission to help underserved populations, she says. “The sole reason they exist is to serve their communities and address the needs of the poor and vulnerable,” she says.
Less than a year after she joined the organization full-time, Treanor was asked to bring the St. Joseph Health System and Providence Health & Services systems together. Because both were Catholic organizations, the partnership seemed like an easy choice, she says. “There was an alignment in values that brought those two naturally together,” she explains. In addition, there was no market overlap. “It was a natural marriage of two organizations with shared values for serving the community at large,” she says.
While working on the merger, Treanor had to balance the needs of the organization with the uncertainty of the modern healthcare landscape. “It was about aligning strategy and understanding the needs of healthcare today,” she says. “It was about how to provide the services the community expects and deserves while successfully dealing with the political ambiguity and uncertainty—including Medicare, population health, changing reimbursements, and consumer-driven healthcare,” she says.
From Treanor’s perspective, mergers cannot just be effective in theory: they have to work in the real world and offer substantial benefits to those they serve. She is especially
Congratulations
Deloitte is proud to celebrate the great work and accomplishments of Joline Treanor.
Congratulations on your continued success.
“Twenty-three million uninsured Americans shifts the problem to the health systems, the safety net hospitals, and clinics. Someone has to care for these people.”

proud, therefore, that on the day the merger was announced, the newly formed system launched its Institute for Mental Health and Wellness and pledged one hundred million dollars to establish a foundation to support initiatives that drive collaboration and learning across the seven states it serves. “This was a differentiating factor,” she says. “Mental illness is the silent disease that everybody in some way or form has some kind of experience with. In coming together, the new organization made a pledge to become a mental healthcare leader and made a commitment of service. The combination was not just good on paper, it was bringing together the best of the two organizations to not only meet the needs of the community but also to meet its commitment of caring for the vulnerable in a fiscally responsible way.”
With the combination complete, Treanor is now taking a few months off as she contemplates her next move. “It was a difficult decision to leave,” she says. “While I was offered another position in the organization, I felt it best to pursue another role that was better aligned with my passion.” As she ponders her future, she will indulge another abiding passion. “I am obsessed with international travel,” she says. She’s already visited Cuba, Peru, and most of Europe, among other locales, and would like to add Vietnam to her passport stamp collection.
Treanor won’t be abroad forever, though; her concerns about recent changes in healthcare and the potential loss of access for millions of Americans will almost certainly bring her back. “Twenty-three million uninsured Americans shifts the problem to the health systems, the safety net hospitals, and clinics,” she says. “Someone has to care for these people, the poor and vulnerable, and organizations are faced with finding a way to do it that is financially prudent, particularly when you are not for profit.” Treanor is looking forward to attacking the challenge: “Complexity and ambiguity are what I love.” AHL
BY JEFF SILVER

For more than a decade, Matthew Stockslager has helped shepherd Dignity Health’s strategy of growth through the formation of highly successful joint ventures
“By identifying the right partners, we have been able to greatly expand access to care for our communities and create more costeffective service delivery options for patients and for the organization.”
Dignity Health’s roots go back to 1854, when the Sisters of Mercy established St. Mary’s Hospital, the oldest continuously operating hospital in San Francisco. It has evolved into four hundred care sites (including thirtynine hospitals) across a twenty-two-state network of comprehensive care. A major period of growth has occurred since 2006— the year in which Matthew Stockslager, now vice president and associate general counsel, joined Dignity Health. Prior to his arrival, the organization was actively seeking external partners for joint ventures and merger-and-acquisition activities to increase its points of care outside of the traditional hospital setting, and Stockslager has been instrumental in facilitating that change.
“I was hired as a regional general counsel but was asked almost immediately to provide legal support for the new growth strategy,” Stockslager explains. “By identifying the right partners, we have been able to greatly expand access to care for our communities and create more cost-effective service delivery options for patients and for the organization.” To date, Dignity Health has
established more than 150 joint venture relationships and/or locations, along with many other types of affiliations.
One of its key early relationships was with United Surgical Partners International, a national leader in developing and managing outpatient surgery centers. Not only has that collaboration resulted in close to thirty outpatient and specialty surgical locations across the organization’s service areas, but it has also allowed Dignity Health to gain valuable insight into developing models for successful partnerships.
Such ventures require a great deal of trust between the parties involved.
Stockslager points out that Dignity Health leadership’s willingness early in the process to establish procedures for internal review and developing good relationships helps guide how the organization evaluates new growth opportunities. However, he says circumstances still arise that require compromise.
“Part of the reason for partnering is because the other organization has a certain expertise and knowledge base,” Stockslager says. “Even though it might have a different view on a
specific issue, allowing them to leverage their experience goes a long way toward building the trust you need to succeed.”
Stockslager and his team have helped Dignity Health build a reputation for being a collaborative partner in everything from governance and financing growth strategies to ensuring regulatory compliance.
“If you ask any of our partners, they will tell you that Dignity Health is always dedicated to fulfilling our commitments and to exploring multiple options in order to find the best solutions for the specific needs of each venture,” Stockslager says.
By 2012, he was spending more and more time working closely with the business team responsible for developing external partnerships. Stockslager’s role had also become increasingly focused on transactions and affiliations to help expand the company’s service capabilities. Other lawyers in the department working on separate specialized issues have also developed their own areas of expertise. At the same time, Dignity Health was adjusting some of its internal operating structure. Due to this alignment of factors, Stockslager, the general counsel at the time, and the rest of the legal leadership team decided to analyze how the entire department could perform more efficiently and effectively and provide more consistent advice to the organization’s business units.
Ultimately, the team helped lead a major shift in the department’s approach. Instead of lawyers acting as generalists within a geographic region, they would develop and leverage expertise in specific functional areas.
“Rather than having each hospital lawyer in every region handling everything from physician contracts to real estate leases, now we can support the organization more effectively by identifying specialists among us to handle particular issues,” Stockslager says. “In the same way that the organization chooses to partner with experts, we can offer the same
level of service and insight by being more functionally focused.”
This has led to other specialized entities within the legal department, such as the Real Estate and Construction Group and Hospital Operations Group. It has also produced faster turnaround time on requests for legal advice since specialists are often able to identify appropriate resources more quickly.
The approach has also preserved personal relationships within the organization. “Our lawyers are still located close to many of our hospitals, so they can be assigned to a particular location and continue to interact with executives and physicians there,” Stockslager says. “But when a specialized issue comes up, that attorney can act as a liaison with the subject matter expert and clients don’t feel as if they’re suddenly dealing with a stranger.”
Stockslager characterizes the legal department as being in a continual state of evaluation to determine how it can most effectively support the organization’s business objectives. This continual process of improvement covers everything from whether to use electronic intake for all legal requests or to create self-help tools to assist clients with finding solutions faster. “We’re no different than the clinical side,” he says. “We’re always looking for ways to reach positive outcomes faster and more effectively.” AHL
The Polsinelli healthcare group is proud to serve as outside counsel to Dignity Health. The Polsinelli team applauds Matt Stockslager of Dignity Health for his leadership and dedication to the healthcare industry, specifically with his vision and agility navigating the challenges and opportunities necessary to succeed in today’s healthcare environment.



Dixie James’s empathy for patients guides her in developing strategies for Einstein Healthcare Network
BY JEFF SILVER
Dixie James reached a crossroads during the summer before her sophomore year of college when she participated in a clinical shadowing program as part of her biology/premed major. She quickly discovered that not only was she squeamish about numerous medical procedures, but she also became overly emotional about patients receiving difficult diagnoses or families coping with the loss of their loved ones.
Thanks to a suggestion from one of the physicians in the program, she discovered the business side of healthcare and its importance in the delivery of care. It is a path she has followed to this day.
After nine years with Einstein Healthcare Network, where she is now vice president, strategic planning and business development, James is still guided by the important lesson she learned that summer.
“The doctor I was shadowing said that I would get numb to the emotional part of the job over time, but I knew that I didn’t ever want to lose the empathy I feel for patients,” James says. “Since then, I have always maintained my sensitivity to how patients feel in a clinical setting when I am developing strategies for growth or improving operations.”
As she analyzes data and studies trends to make the best strategic decisions, James believes that her colleagues are driven by the same recognition that all of their efforts impact patients when they are at their most vulnerable.
“By and large, people choose the healthcare field because they care about other people,” James says. “Even if the rest of the team doesn’t agree with my recommendations, if we back up and focus on what’s best for the patient, we can almost always find consensus.”
Einstein Healthcare Network presents James with significant strategy and development challenges because it serves two distinctly different markets. Einstein Medical Center, its flagship academic medical center, serves a primarily low-income, uninsured, and underserved patient population. Its other acute care hospitals, however, serve more affluent suburban communities. The disparities between the two require James and her team to be highly creative in tailoring services that will meet each specific community’s needs.
James VP, Strategic Planning and Business Development

For example, Einstein is in the process of implementing virtual patient visits. For one community, the initiative represents a matter of convenience related to details such as work or childcare schedules. For the other, it is a solution for patients who might not be able to afford transportation or are not physically able to negotiate the challenges presented by mass transit.
“There is usually no one-size-fits-the-entire-network strategy,” James explains. “That’s why it’s so important to always have an individualized mind-set and approach for every challenge and solution. Plus, to provide the same kind of industry-leading care to all parts of the network, you have to get creative about how to do more with less.”
James has learned to leverage both technology and traditional platforms to help Einstein grow, improve operations, and increase positive patient outcomes. In addition to virtual visits, telemonitoring is being deployed to remotely monitor the most at-risk and chronically ill patients.
As vice chair of Philabundance, Philadelphia’s largest hunger relief organization, Dixie James is focused on advancing partnerships that help end hunger while improving health. One example is the Fresh For All program, a weekly farmers market that provides free fresh food to those living with food insecurity.
Einstein Healthcare is working on a partnership with Philabundance for the program, as it is directly connected to Einstein’s mission to care for underserved and uninsured patients. “Healthy food and adequate nutrition are critical to maintaining health and wellness,” James says. “At times, our patients and communities don’t have either enough to eat or adequate access to healthy food choices. Fresh For All is helping lead the charge for change.”
Although these kinds of solutions are strategic innovations, James knows that sometimes the biggest challenge facing a great idea is finding the right time to execute it. When she first raised the idea of virtual visits several years ago, for instance, market conditions and reimbursement models simply hadn’t evolved enough to provide sufficient support. Even though the necessary technology was available at the time, implementation wasn’t yet financially feasible.
“I’m OK being the rebel who champions ideas that might not be quite right,” James says. “To do my job properly, sometimes I have to go out on a limb and to be willing do things differently. I might borrow or tweak details from someone else’s approach, but to grow and do things more effectively, you prioritize the best ideas, make the best use of resources, and file away the rest for another time.”
As for her most daunting challenge, James points to creating a continuum of care that extends beyond the walls of the Einstein network. That would require a cohesive, collaborative, and holistic network made up of community organizations and other stakeholders committed to improving overall population health.
“We know we can successfully treat most patients who are admitted, but if there isn’t ongoing, coordinated support for needs like food, shelter, psychiatric care, or substance abuse, ultimately they’re going to boomerang back to us,” she says.
Issues of funding, privacy regulations, and the infrastructure needed to support such a network, at least for now, appear to be insurmountable. With the current emphasis on population healthcare and the possibility of future state support, however, she believes it could still be a possibility for the future.
Looking back on the summer before her sophomore year of college, James has never doubted that she made the right decision. “I get to do work that I love and that has a direct impact on patients,” she says. “It gives me a purpose professionally and spiritually, and that makes even the hardest days much easier.” AHL
Healthgrades is dedicated to empowering stronger and more meaningful connections between patients and their healthcare providers. At www.healthgrades.com, we help 30 million consumers a month to find and schedule appointments with their provider of choice. With our scheduling solutions and advanced analytics applications, we help more than 500 hospitals across the country to cultivate new relationships using deep consumer insights, improve patient access, and build customer loyalty. At Healthgrades, better health gets a head start. To learn how Healthgrades can help you reach and engage more patients, visit healthgrades.com/hospitals or call 855.665.9276.

BY LORI FREDRICKSON
Jeremy Livianu has translated his chemical engineering background into a successful legal career in the healthcare industry, helping build biotech company Nevro’s legal department from the ground up
Jeremy Livianu sees his career as an attorney and his bachelor’s degree in chemical engineering as two sides of the same coin. “Chemistry and engineering are the science of nature, whereas law is the science of how our society is governed—from the Constitution and its origins to the laws and regulations we have to follow today and the ways to navigate compliance with those laws,” he says.
Having spent the past several years working in a variety of corporate transactional, healthcare compliance, and global privacy roles at various medical device companies, Livianu has been able to merge his interests into driving growth for an industry that he’s passionate about. “What I like is playing a role in bringing life-changing, life-saving technologies to physicians and patients,” he says.
When Livianu started his law career, IP law seemed like a natural fit with his engineering background, so he started out
practicing patent litigation. But he didn’t realize his true calling until he was tasked with building the compliance program for Tethys Bioscience, a small diagnostics company. “That experience taught me that I love working for small companies, where you are often tasked with building infrastructure from the ground up,” Livianu says. “It also taught me that I love working in medical technologies and using my science background.”
From there, he moved on to become the manager of healthcare compliance for Johnson & Johnson, which gave him experience in a leadership role supporting medical companies on the West Coast.
In 2014, Livianu was approached by Nevro, where he now serves as the director of legal affairs and global healthcare compliance and privacy officer. At that time, Nevro was seeking US approval for its high-frequency spinal cord stimulator and was aiming to go public. The opportunity matched his
interests perfectly. Creating and building Nevro’s corporate legal practice was exciting, and pairing his experience in compliance, privacy, and medical devices on a global scale allowed him to take on a new type of leadership role. “I loved the fact that there was no infrastructure, that it was going to be a blank canvas,” Livianu says. “I was going to have the opportunity to build a department in the way that I thought would be best for Nevro today and for its future.”
Livianu had to build the department at a dizzying pace, as Nevro rapidly expanded while also announcing its IPO later that year. In Livianu’s early work for the company, he kept a careful eye to the future and started by meeting with team members globally to find out where they needed the most support to continue future growth. He also built automation and streamlined programs to make them more scalable and cloudbased and worked on ways to help assure that investors believed in the company and
backed them in early rounds. “It was an understanding that I’m not just building for today, but building something with the infrastructure and scale for tomorrow’s model,” Livianu says.
Because of the company’s upcoming plans to go public, he was tasked with helping prepare the company for the IPO while also defending Nevro against employment lawsuits brought on by its competitors who wanted to slow down Nevro’s growth. Once Nevro had gone public, Livianu then focused on formalizing procedures; negotiating agreements across multiple areas of the business, such as sales, marketing, and clinical and operations; implementing training programs for Nevro’s global sales force; and ensuring that the company was following all required federal and state regulations.
Livianu also spends a lot of time making sure that he’s connected with team members in the United States as well as its global sales teams. He knew at the outset that he didn’t want to build a US-centric legal department, so he’s worked to understand anticorruption and privacy issues at home and abroad. He even goes on the road each quarter to attend different sales meetings and conferences across the United States as well as throughout Europe and Australia. “Europeans and Australians treat legal issues such as privacy much differently from Americans,” Livianu says. “For example, they are much stricter in their laws protecting personal information, and you have to be much more careful with things like direct-to-patient marketing.”
It helps that Livianu speaks four languages: French, Romanian, Spanish, and English. “When you can meet people and talk to them in their language, it shows that you care and can be culturally sensitive to them,” Livianu says. He also says that helps him build rapport with team members and customers. This has become increasingly important as Nevro has grown from fewer than one hundred to more than six hundred employees since he started. In addition to his day-to-day legal responsibilities, Livianu


Morrison & Foerster is proud to work with
and congratulates Jeremy Livianu for his recognition in American Healthcare Leader. mofo.com
2017 Morrison & Foerster LLP
“When you can meet people and talk to them in their language, it shows that you care and can be culturally sensitive.”
has focused on making sure that he’s able to engage with his team members in ways that are fun and interesting.
This past January, he organized a global sales training that went the extra mile. After teasing his two hundred-member audience of global sales reps with an intro that suggested that the conference was going to be dry and rote, the presentation then jumped into a dance routine, followed by rounds of Family Feud style games, and a series of short videos commissioned from the Chicago-based comedy theater The Second City. “We put a lot of blood, sweat, and tears into planning the presentation, and it came together in a fun way,” he says. “There are so many people in the organization that you might only meet once a year, and this gives you an opportunity to relate to them personally in a way you’d never get to otherwise.”
As someone who firmly believes in the importance of trust and accountability in building relationships, Livianu strives to be available and approachable in all his work at Nevro, always phoning his customers and colleagues to check in and creating tools and resources to help with current challenges or future projects. And he loves knowing that he’s working at a company that is passionate about delivering a valuable product. “Being able to come in at the beginning and being able to bring a technology to the public has been a special opportunity,” Livianu says. “It was my dream job, and I now know that this will be the space I want to continue growing my career.” AHL
BY CHRIS GIGLEY
Debra Muscio’s passion for compliance, audit, information, and technology keeps Community Medical Centers vigilant against noncompliance and security threats
“Education is a large part of my life. If you want to be in the know, this is the job for you.”
One of Debra Muscio’s professors told her that she would be an auditor one day. Muscio laughed, but her professor was right. Muscio’s current role as senior vice president and chief audit, enterprise risk management, ethics, and compliance officer at Community Medical Centers in Clovis, California, is a perfect fit.
“I get up every day loving the profession that I’m in,” says Muscio, who earned an MBA in strategic leadership and a BS in accounting and has received a number of certifications and awards over the years.
“Education is a large part of my life,” she says. “If you want to be in the know, this is the job for you.”
Muscio always wants to be in the know. She doesn’t consider herself merely a Type A personality. “I’m probably triple-A, which works in this profession,” she says. “Various individuals in the organization do the work, but if I don’t stay informed, I can’t lead.”
Muscio is a nationally known leader with thirty-three years of experience, twenty-nine of which she spent in the audit and compliance healthcare profession in Connecticut and California. She served as the chief audit and compliance officer at Central Connecticut Health Alliance for sixteen years and internal audit at Hartford HealthCare Corporation for six years.
In 2011, Muscio relocated to California to join Community Medical Centers (CMC), where she serves as the senior vice president, chief audit, ERM, ethics, and compliance officer. Experience has taught her the risks of being blind to initiatives that other team members or individuals at CMC are working on.
“There will always be human error,” she says. “Not everyone will understand it all. That’s why we have a team environment here. We’re all part of this, and we all need to make it work.”
Muscio credits her team, fellow executives, and the rest of the staff for helping CMC handle privacy, information security, and compliance issues as quickly as healthcare regulations change. Simply put, it’s a big job. CMC is the largest hospital system in the Fresno-Clovis area, serving a fifteenthousand-square-mile area, and regulations in California can be complex.
One example is the little-known fact that California is one of a handful of states that prohibits the direct employment of doctors by hospitals. As such, physicians’ contracts and the encompassing regulatory requirements become a compliance concern. Muscio, the legal team, and the executive team work closely together to gather the appropriate documentation to support compliance.

Debra Muscio SVP, Chief Audit, ERM, Ethics, and Compliance Officer
“The regulators have increased scrutiny, making sure we pay and treat physicians fairly, and the supporting information you have must demonstrate you do so,” Muscio says. “We have a whole team that meets, reviews, and assesses this documented process.”
She notes that she needs to work closely with the chief legal officer or outside counsel. “I don’t have that legal expertise,” Muscio says. “This collaborative working relationship is a key component for compliance.”
The process sounds exhaustive—and it is—but Muscio’s self-described Type Triple-A personality helps keep things moving along. Plus, she has the teams implement steps to ensure that, should CMC ever get audited, cases can be resolved quickly.
“When an area is presented with an audit and we need to demonstrate compliance, you don’t want to have to reinvent the wheel,” she says. “We have processes in place in which information is documented and saved so we don’t have to question past or present happenings.”
Muscio is big on documentation. A certified fraud examiner, she advocates everyone involved in contracting, billing, coding, and documentation is educated and understands that they must make a record of everything to guard against human error, false claims, and other pitfalls.
Lately, more potential pitfalls are coming in the area of cybersecurity. About a year ago, Muscio hired a chief information security officer (CISO) to work within her compliance department, independent of the IT department, but also working closely with the chief information officer.
“Sometimes, IT people are working so fast to implement, upgrade, or fix systems, but many times no one inside or outside the IT department focuses on understanding the vulnerabilities,” Muscio says. “Having the CISO outside of IT helps make me more aware of these situations. I can be forward-thinking.”
Muscio is uniquely qualified to do so. She has experience as an IT auditor, during which she attended hacking/IT audit and security training classes to learn how systems are often compromised. She has a passion for that side of the business, saying that before she hired the CISO, she would periodically talk to IT and ask questions. “By educating the system and building the compliance information security team, it gives us the means and tools to monitor and assess the security risks,” she says.
Now compliance can monitor phishing tests to gauge the vulnerability of the network. Implementing the monitoring programs, she knows when someone is inappropriately looking at EMRs and can take corrective measures. In short, she has a lot more information to work with, which is exactly what she needs and wants.
“What you know can’t hurt you,” she says. “It’s what you don’t know that can come back to cause problems. I’m constantly looking for answers to what I don’t know.” AHL
Hooper, Lundy & Bookman, P.C. congratulates Ms. Muscio, and is proud of our association with Community Medical Centers. With offices in California, Massachusetts, and Washington, D.C., Hooper, Lundy & Bookman is the largest law firm in the country dedicated exclusively to the representation of healthcare providers and suppliers.
When you go above and beyond, the sun rises on boundless potential. We believe in the value of applauding your achievements—and the possibilities they inspire.
Congratulations to Debra Muscio for her leadership and dedication to the health care industry.
After a long career in employment law, Donna Hughes is taking her legal background and leadership skills to build HR at Impax Laboratories
BY LORI FREDRICKSON
Donna Hughes SVP, Human Resources
Impax Laboratories

One of the most difficult moments in Donna Hughes’s career came toward the end of her eight-year tenure as the in-house counsel on labor and employment for Circuit City, when the electronics giant closed down amid financial difficulties during the recession. As part of the leadership team winding down the employment of thirty thousand team members, the emotional impact for Hughes was twofold: first, in being charged with terminating plans and contracts for the company’s employees, aware of the consequences the closure would have for them, and second, in knowing that her own position at the company was also coming to an end.
After having joined Circuit City during some of its boom years and building her department steadily since then, this could have been a devastating moment for Hughes. Instead, she chose to embrace the changes and turn them into a learning experience. Her next organization was a growing pharmaceutical company, and the knowledge she gained while Circuit City wound down was beneficial in helping that growth. “The skill sets you learn during a difficult time
can help an organization tremendously,” Hughes says. “You can add value when an organization is on the upturn, as well.”
Her experience with finding new opportunities during periods of change is what led her to her current role at Impax Laboratories, where, after her twenty-three-year career as a lawyer largely focused on employment law, Hughes joined as the senior vice president of human resources in mid-2015. And it’s also what has helped her thrive, having joined at a time when the pharmaceutical company needed someone to align the organization’s HR department with major growth.
Though Hughes had been asked previously by other organizations to move into HR, she hadn’t seriously considered it until she was approached by Impax’s then-CEO. Hughes was attracted both by the opportunity and by the company’s interest in her leadership style and focus on business strategy.
“I was ready for a challenge, but I didn’t want to completely leave my legal background behind,” she says. “Not only did I not have to leave it behind, I lean on it every day to drive dialogue and the right solutions for the organization, as well as in the investment and development of our people.”
“If there are opportunities that we’re looking at and there are due diligence efforts, that’s a development opportunity for my team.”
functional endeavor helped it take a foothold, immersed throughout the company’s culture. “Building relationships across the organization is very significant to successful collaboration,” she says. “Our products change patients’ lives. That’s meaningful, and employees take that to heart.”
As part of the executive team, Hughes participates in all business strategies. Her previous experience has been an asset in enabling her to think through strategies from a business perspective while also knowing to promote best HR practices and manage risk. In addition to being able to add value and perspective to the company in this way, she’s focused on making sure that her own team members are seen as strategic partners rather than support. To raise the HR department’s profile, HR business partners are involved in strategic business initiatives. “If there are opportunities that we’re looking at and there are due diligence efforts, that’s a development opportunity for my team,” Hughes says. This has even helped team members move into different or more senior roles where their talents can be better leveraged.
Impax had been a growing small-cap company, and though the organization had built infrastructure in many departments to support growth, its HR department had remained static. Hughes immediately set about making changes—investing in functions that had been overlooked, helping to capitalize on a newly installed human capital management system, and developing a total rewards function and philosophy. She and her team worked on streamlining a number of processes to make them more simple for management, ranging from approval processes to enhancing performance management using capabilities in the system.
Hughes also focused on promoting engagement throughout the organization and incentivizing management to focus on that goal. One of her primary goals was to make sure that investment in people was at the forefront of decisions, rather than something that was managed separately from a business end. “It’s important to focus on what attracts people in a competitive market,” Hughes says. Working closely alongside management, she and co-leaders in compliance and corporate communications created a new values set for Impax titled CARE: collaboration, accountability, respect, and excellence. The initiative was rolled out in 2015, alongside plans to drive those values throughout the organization. That cross-
That capability for cross-functionality and collaboration is something that Hughes sees as particularly relevant for the organization currently. Impax recently announced a consolidation program, and Hughes has focused on making sure that the changes at the company can help lead into new growth opportunities for employees by allowing them to lead projects, work under new leaders, or take on an acting head role. Since starting with Impax, she’s focused on looking for ways that her team can be developed and where their talents can add value. She’s also worked on building opportunities for her team to teach and develop one another, in part through a training series called “Education Begins at Home.” Hughes has also taken over leadership of the internal communications function, and her primary objective is to drive transparency and break down organizational silos. Her future goals, she says, are to continue to build cross-functional dialogues and to help promote networking, something that has been an asset to her throughout her career and that she’s passionate about doing for others. Most importantly, Hughes is looking forward to seeing where Impax goes next. “We manufacture and deliver products that positively impact the lives of patients every day,” she says. “It’s rewarding to be part of an organization where the work you do adds value and makes an impact, and at Impax, HR is a valued part of the team.” AHL

At Aon, we understand what drives healthcare quality, cost and efficiency. Our insights, gained over decades of working with healthcare organizations, enable us to deliver breakthrough solutions for delivering care more effectively and efficiently. We leverage this knowledge to help employers improve their benefit plans, driving down costs while driving up employee satisfaction. This unique combination of expertise sets us apart—and produces dramatic results for our clients. For more information visit aon.com
Georgette Kores was hired to make World Fuel Services a healthy, happy, and productive company. What she’s created is global in nature, even as it drills into the specific wellness needs of each individual.
BY RUSS KLETTKE
Corporate wellness is a lot like the proverbial horse led to water. Just as you can’t force a stallion to drink, it might be impossible to prompt all members of the accounting department to go to the gym.
This is the kind of thinking that played into the design of the wellness program at World Fuel Services (WFS), a global energy distribution business. Georgette Kores is the company’s manager of global wellness and engagement and the woman responsible for WFS’s wellness program. She is a perfect fit for this job because she understands both human nature and fitness, given her career in corporate wellness and her education as an exercise physiologist.
Still, this is no small task, given the company operates at more than 150 locations in more than 30 countries, with a workforce of more than 5,000 employees. Kores had to consider the cultural differences from continent to continent, as well as the range of employees in the company’s core business of supplying energy products and services to marine, aviation, and land-based transportation companies. It took more than a little effort to get this sprawling energy company’s workforce in shape.
For a project like this to be successful, it starts with support from the highest level in the organization: senior management. “This was their idea before I was hired,” Kores says. “They wanted a culture of healthy competition, and they knew it would require more than a company-based fitness center.”
The ambiguity of the term “corporate wellness” is one of the biggest reasons that initiatives like this often fail, Kores says. It is a general term that has evolved considerably over the years and expresses itself differently from firm to firm. Fifty years ago, it may have meant employee assistance programs, but now it encompasses biometric screenings, smoking cessation programs, gyms in the workplace, and much more.
But often, people who were already predisposed to healthy habits were the biggest users of such programs. Those who weren’t especially health-minded sometimes found such programs threatening, Kores says.
To be clear, wellness at WFS doesn’t necessarily require anyone to work up a sweat on a treadmill. As Kores explains, the WFS program, “Wellness for Life” (WFL), emphasizes four dimensions: social, physical, emotional, and financial wellness. Each dimension has multiples points of entry for employees, including focuses on nutrition, smoking cessation, hydration, activity/exercise, financial wellness, and a broad category that incorporates all of these, plus emotional and social components. For example, someone dealing with nagging financial problems might not be able to manage dietary changes, so it’s more effective to tackle that source of stress before taking on other behavioral modifications. Once one health pain point is managed, the individual can confidently move on to make other positive changes.
In other words, Kores devised the program to fit the unique needs of all employees. The company even ensures that traveling employees can stay on their program while staying in hotels or traveling via plane or car.
She credits her colleagues in marketing for helping to build participation. They collaborated with Kores on a full complement of communications tools and platforms to advertise WFL components, including a sixweek special event in the summer of 2017. Called the WFS WorldSTRONG Fitness Challenge, it tested employees’ physical strength and tracked their improvements over a forty-five-day competition.
The social wellness component of the program is typically called something like “community relations” in other companies, Kores says. WFS’s program involves volunteer service projects such as park cleanup and tree planting days and local 5K and 10K runs—each a physical and social activity that arguably contributes to emotional health. Kores administers these from the wellness initiative, a logical joining of green- and health-oriented programming.
If that seems unorthodox, it might be because people in Kores’s position have to do some out-of-the-box thinking. Science and health specialists aren’t necessarily prepared


Healthy mind, healthy body, healthy you
Aetna is proud to support Georgette Kores/World Fuel Services.
for careers in corporate environments, and she advises anyone thinking about corporate wellness to consider what that entails. It’s not necessarily about short-term action and rewards. Typically, the planning and selling aspects can be frustrating to her colleagues in exercise physiology, and there’s rarely a one-sizefits-all solution.
“It’s a different world,” she says. “We didn’t start with an off-the-shelf program. I had some best practices up my sleeve, but we needed to develop a multinational program from the start.”
To ensure that program could develop successfully, Kores took three months during the development stage to get a feel for the company, its key players, and to understand their knowledge and expectations. “Our employees were not unhealthy,” she says. “We simply looked at population trends for ways to prevent what is out there.”
The wellness program also folded into a larger corporate initiative: to create a unified culture in a company that has grown through acquisition. It turns out that having a welcoming, holistic, corporate well-being program also fostered belonging and a shared sense of purpose.
Kores is held accountable for program results, which are published internally on a quarterly and annual basis. Importantly, the program participation levels have grown over time, meeting the original objectives of senior executives who fund it. This wellness program is, after all, about business.
And despite launching the wellness program on a global scale, it wasn’t as difficult as it might seem at first glance because of Kores’s dedicated team. “We have about ninety-seven people in our global wellness ambassador network who promote their programs in their workplaces,” Kores says. “I call them my boots on the ground.” She adds that within their workforce the cultural differences are really not much of an issue where it comes to wellness: “Employees everywhere just want to be healthy and happy.” AHL
BY JOSEPH KAY
patient billing experience
Marji Karlin VP, Finance Montefiore Health System

Marji Karlin has spent almost her entire thirty-plusyear career at New York’s Montefiore Health System as a partner and witness to its extraordinary growth.
In 1986, Montefiore was an academic medical center in the Bronx with two divisions; in 2018, it’s an integrated health system of eleven hospitals with more than three thousand beds. Now, as the health system’s vice president, finance, Karlin leads a department of about 170 employees. Despite the system’s transformation, her team is stable and loyal, many to the degree that she herself has been.
Karlin credits their longevity to a simple leadership approach. “I hire well, and I take interest in the individual as well as the collective,” she says. While not everyone on her team has to be friends, they have to share the ability to prioritize Montefiore’s mission. Her success at that mission is clear, as some of her direct reports have been with Montefiore for nearly twenty years.
Paradoxically, Karlin has discovered that one key to keeping her team together has been her willingness to recommend them for openings in other departments within the organization. Her investment in those individuals—doing what’s best for them, at whatever stage of their careers—
has often paid off later, when they returned to her team at a higher position, more seasoned and capable than before. Three of her five current direct reports have left for other opportunities, then returned; a fourth is coming back to fill a recent vacancy.
“I’m not afraid to help people fly and launch. That’s what people should do in their careers: get different experiences and not get stuck,” she says. While Karlin naturally wants to hold onto the best talent, she remembers to take care of their needs, too. “I’m not afraid to recommend them. That’s what’s best for the individual and the organization, and I think my staff appreciates that,” she explains.
Karlin also develops her colleagues within the organization by providing ongoing access to training. “We’ve always been very focused on trying to create a career path, developing a pathway for people to move up through our department and our organization,” she says.
A number of her department functions, such as application support and data analysis, are highly technical, so Karlin encourages her staff to hone their skills and keep abreast of evolving technology and practices. Along with leadership training, these tools help prepare Montefiore associates to
climb within the organization; a visible upward career path is another key to fostering engaged and loyal associates.
Fostering an engaged team is crucial both to Karlin’s team members and to overall Montefiore initiatives. Today, Montefiore is overhauling patient-facing billing and scheduling procedures to make them as patient-friendly as possible. They’re crafting new, streamlined billing communications, and empowering providers and patients to make smart, informed decisions.
Karlin identifies two major challenges. The first is to examine the various materials with a patient’s eye. “So many of us in the financial and medical arena are used to lingo,” she says. “We’re translating for people who don’t necessarily understand the terminology we use. While that’s been a challenge, we’re always revising based on feedback we get from patients.” Leaders and associates collaborate with patient advisory boards, which include providers and current patients, who provide iterative feedback on patientfacing materials. Karlin calls it a continuous feedback loop that guides the team toward smoother, more patient-friendly communications.
The second challenge is to examine the institutions internally, tracking the pulse of the health system itself. “The health of Montefiore is everybody’s shared goal, but sometimes you get caught up in your own day-to-day work,” Karlin explains. “You have to pull people out of what’s best for this physician group or that department, break down those walls, and move toward the greater good.” Her collaborative approach, both within her department and in connection with others, continues to bear results.
“If you start with the groundwork and head toward a goal, people will come on board,” she says. “Sometimes it takes a couple tries.” Karlin notes that some of today’s successes have roots a decade deep; the current work to improve patient access was found in Karlin’s conversations in 2008. “Through some recent collaboration, we’re able to get it off the ground now,” Karlin says. “I don’t see that as a failure in 2008; I see it as priming the pump for what’s happening in 2018.”
Montefiore has already reduced the quantity of paper statements by 50 percent. Minimizing the amount of paperwork makes the process more efficient for all parties and prevents communication fatigue for patients. In step with the rapidly evolving convenience of online shopping, banking, and other consumer services, the Montefiore team is working toward an online payment system that presents all relevant information up front and in one place.
Karlin hasn’t noticed any real friction, but she acknowledges that her strategy for building connections across the organization might go above and beyond the traditional boundaries. But that’s fine with her, if it means that colleagues across the organization are banding together to advance the mission. “We all work for Montefiore Health System, and Montefiore is here to support our communities,” Karlin says. “That’s what we’re all about.” AHL

We developed the world’s first transvenous cardiac pacemaker and have been setting the pace in medicine ever since. To discover how we’re doing more in healthcare at Montefiore and our Albert Einstein College of Medicine, go to doingmoremontefiore.org
BY CHRIS GIGLEY
Why Sherri Zink’s work in IT and data analytics is crucial to the way BlueCross BlueShield of Tennessee fulfills its mission
When Sherri Zink arrived at BlueCross BlueShield of Tennessee seven years ago, she was tasked with one mountainous job: to build a data and analytics center of excellence.
Her effort didn’t stop there, however. Along with accomplishing that task, Zink has also helped shape the company’s culture of innovation and data-driven decision making by introducing transformative analytic solutions and predictive science into the process.
“Data is embedded in what we do every day,” says Zink, senior vice president and chief data officer for the organization. “We see it as a valuable strategic asset because it gives us insight into ways we can better support our members, customers, and communities. Data also helps us deliver on our corporate mission.”
Zink and her information delivery team work closely with IT and other business units across the organization to develop tools and technology that translate data into actionable insights and solutions.
Zink’s initial career path was in information systems technology. She earned her degree in the field and took her first job at a healthcare company in Chattanooga, Tennessee, that is now part of Cigna. In that role, she used information to assess benefit design trends and plan performance metrics for employer groups. “I realized early on that I loved analyzing the data, not just programming it,” she says.
Zink also enjoyed translating her analyses into narratives that clients could understand and leverage to make changes that improved their business performance.
“At the end of the day, you can have all the data in the world,” Zink says. “But if your business partners and customers don’t know how to leverage it, it’s not worth a lot to them.”

Zink continued her path in the healthcare industry, spending twenty-one years of her career at Cigna in various analytic roles. In 2005, she joined the UnitedHealthcare national accounts division as director, reporting strategies. In 2007, she became vice president, reporting & analytics for Optum, where she was responsible for enterprise-wide clinical reporting solutions and data infrastructure design.
Upon joining BlueCross BlueShield of Tennessee in August 2010 as vice president, medical informatics, Zink led an analytics team of fifty-four data scientists and data analysts focused on reporting solutions and research projects. The separate IT department, meanwhile, included a data management team and application development team.
“My job was to assess existing data infrastructure and analytic capabilities across informatics and IT, identify any gaps, and bring in new technologies and skill sets to successfully deliver on this new organization-wide strategy,” Zink says.
She spent her first ninety days at the company learning the lay of the land, analyzing the organization’s data, the ease of access to it, and the technology available to harness it. Above all, Zink realized that a strong data architecture and infrastructure is the key to a successful analytics center of excellence.
“We wanted to be able to run predictive models easily across large amounts of data,” she says.
Another critical aspect of the project was the communication strategy throughout the process. “I found myself taking on somewhat of a salesman-type role, making sure everyone was comfortable and on board with the decisions,” Zink says. “I was careful to translate all the technical jargon into something that was meaningful to my business partners to get their buy-in.”
In 2012, BlueCross BlueShield of Tennessee implemented its initial data analytics framework with a new database structure and business intelligence platform. Zink and her team, in partnership with IT, also began to launch new analytic applications to drive business value immediately.
“We made sure to create some quick wins throughout the process,” Zink says of those applications. “It takes a while to create a database, so we improvised by creating business intelligence applications within ninety days of releasing new data subject areas onto the data platform. This allowed our business partners to leverage the analytic applications with their customers and embed them into their existing operational processes.”
Zink was fortunate to have a senior leadership team who understood the value of data and the heavy investment needed to make it all work.
She secured their buy-in by prioritizing business needs, showcasing the return on investment for each project, and tying the development to corporate strategic goals. “This is an ongoing process as we continue to build out and enhance the platform today,” Zink says.
It was also important for Zink and her IT counterparts to establish clarity on the role each of them would play in the development aspects of the project.
“There were some gray areas we had to work through at first, but we’ve hit our stride, and things are moving along really well now. We couldn’t be successful without our IT partners,” Zink says.
One final success factor was driving the adoption of the platform. This required training for the users as well as integration of the analytics into day-to-day operations. “People, process, and technology are all important aspects of our strategy and this consideration is built into the rollout of each new project,” Zink says.

Now that data is in such high demand at BlueCross BlueShield Tennessee, Zink and her team are experiencing a new challenge: keeping up with expectations. They are streamlining their processes to create efficiencies to help avoid access and development delays.
“We’re asking, ‘How do we move more of what we do into a self-service environment so we’re not creating bottlenecks in delivering data and analytics?’” says Zink. “We want to make it easier for our business partners, data scientists, and data analysts to quickly get the information they need.”
Zink divides the progression that she and BlueCross BlueShield of Tennessee have made over the past seven years into three layers. First was data integration, bringing the data together cohesively. The second was data transformation, taking data and running predictive models, risk stratification, and segmentation on it. Finally, through data visualization, she and her team figured out how to showcase the information so business units and customers can easily identify opportunities.
“We have business units that have been leveraging this information platform for 3–4 years now,” Zink says. “Now we’re looking at how to capitalize on the solutions associated with that data.”
Having already used Zink’s new database infrastructure to analyze historic data and predict future events, BlueCross
BlueShield of Tennessee is applying prescriptive analytics, creating solutions around what the data shows, and alerting business partners, customers, and providers about trends they should be aware of.
Zink is now well beyond the task that BlueCross BlueShield of Tennessee gave her seven years ago. Her team has grown to include 215 data and analytic professionals, and the analytics platform now houses more than one thousand data sources and has evolved to include machine learning, text analytics, and a “next best action” solutions workbench. She and her data are leading the organization into the future. AHL
Information Builders helps healthcare organizations succeed in maximizing their efforts in value-based care. Our OmniHealthData application allows provider and payer organizations to create a patient/member-centric view across the continuum of care. Optimized costs, timely care delivery, and improvements in risk management, network performance, care coordination, and workforce and patient/member satisfaction lead to healthier outcomes and greater market share. Founded in 1975, Information Builders is headquartered in New York City, with offices around the world, and remains one of the largest independent, privately held companies in the industry. Visit us at informationbuilders. com and follow us on Twitter at @infobldrs.
Sergio Plecas

Information Builders is proud to have helped Sherri Zink and BlueCross BlueShield of Tennessee improve their members’ quality of care and satisfaction. We look forward to continued success at every level. Learn more at our Healthcare Solutions Center: informationbuilders.com/healthcare.






Prognosis
“We’re looking for heroes. significant difference in somebody else’s life.”
Somebody who’s going
to come in and make a
BY GALEN BEEBE | PHOTOS BY GILLIAN FRY
or James Harrington, statistics are an essential litigation tool. As senior vice president, chief intellectual property counsel at Shire Pharmaceuticals, Harrington uses data analysis in every step of the litigation process, from deciding on lead trial counsel to determining the best strategy in the courtroom.
Harrington began fine-tuning his system of statistical analysis after reading Thinking, Fast and Slow by economist Daniel Kahneman. “Kahneman used litigation as an example where people think it’s open as to who wins,” Harrington explains. “But actually, if you have the right data, you can predict with a high degree of certainty how a case will come out, assuming the case is presented properly in the courtroom.”
To determine their strategy, the Shire litigation teams analyze the success rate for lead trial counsel, the time to trial and likely outcome in a given jurisdiction, the type of patent claim being litigated, the data generated related to prospective jurors, and the history of the trial judge. Based on the predicted results, Harrington will either bring the case to trial and use data analytics to optimize the chance of success, or try to enter into a settlement with favorable terms for Shire.
One of Shire’s most important cases involved the drug Vyvanse, which is used to treat attention deficit hyperactivity disorder. Six generics challenged the patent portfolio. After gathering data on prospective litigation teams, Shire selected the legal firm Haug Partners to try the case. Shire also analyzed the judge’s past rulings and the particular patents in question, after which Harrington predicted with more than 90 percent certainty that Shire would prevail. The data was right—Shire won on summary judgment and the verdict was upheld in the court of appeals. “It’s very unusual to brief a leadership team or board that you have more than a 90 percent chance of winning any kind of litigation, and that was done strictly on the data analysis,” says Harrington. Statistics can predict a likely outcome, but the numbers are not a guarantee. “It’s not like we’re inputting all the data into a computer and getting the result,” Harrington says. “We still have to try the case.” Even with a 90 percent likelihood of winning, there is a 10 percent chance of defeat.
The opposite holds true, as well. Shire’s legal teams try to settle cases that the data analysis predicts they are unlikely to win, but if the settlement is unacceptable, they will take the case to trial and try to beat the odds. “It can be motivating when the data says you shouldn’t win and then you end up
James Harrington SVP, Chief Intellectual Property Counsel
Shire Pharmaceuticals


In 1991, James Harrington served on the litigation defense team that successfully overturned the conviction of Glen Woodall for serial rape. Although the DNA evidence excluded Woodall and his conviction was vacated, the prosecution prepared to retry the case. The case garnered significant attention when it was discovered that a West Virginia State chemist had falsified evidence to convict Woodall. “I have the original DNA test, and the National Law Journal article, and the letters from the local counsel all framed and sitting in my office,” says Harrington. “That was a case I was incredibly proud of.”
Harrington also served as the chief legal and scientific correspondent for USA Today during the O.J. Simpson trial when he was a member of the chemistry and law division of the American Chemical Society. “The case is a good example where notwithstanding the statistics strongly linking Simpson to the crime scene, other evidence brought reasonable doubt to the jurors’ minds, and he was found not guilty,” Harrington says.
winning the case,” says Harrington. “There is a chance that you can overcome the burden.”
To overcome those obstacles, Harrington uses data—this time, to select litigation counsel and experts and to construct a story in the courtroom. Harrington also uses data analysis during jury selection. Attorneys and jury consultants can quickly collect large amounts of information about potential jurors in order to determine the likelihood of a bias. Through this type of analysis, Harrington’s team can design its courtroom strategy to boost the probability of a win. This strategy works; since Harrington joined Shire in 2004, his team has a 95 percent success rate.
Data isn’t the only key to Harrington’s winning strategy. Shire’s company-wide emphasis on career development ensures that his attorneys are always improving. For Harrington, that emphasis largely manifests as a bottom-up management style. “I’m here more as a coach than I am as the head of a department,” he explains. “Any opportunity to teach the less-senior lawyers and develop them and put them in front of our board or our executives, I will take that.”
In 2017, Shire launched the People, Operations, Development (POD) program, which includes POD Academy, a seven-month leadership and skill development program designed for the company’s in-house legal and secretariat professionals. Claire Debney, director of legal strategy, developed the content for POD and the academy with input from Shire’s general counsel Bill Mordan and other members of the organization’s legal leadership team.
We see things differently.

We congratulate our friend and client James Harrington for his leadership and contributions to Shire Pharmaceuticals & the Healthcare Industry.
We are honored to have supported James Harrington and the ShireIPteam throughout their many remarkable successes. Proskauer’s collaborative Life Sciences Patent group partners with our clients to further their business objectives in key therapeutic areas.

For further information about our Life Sciences Patent practice, please contact:
Fangli Chen, Ph.D. Partner, Vice-Chair Boston +1.617.526.9633 fchen@proskauer.com
“We’ve been able to protect our franchises brilliantly . . . because we hire really talented people and develop them really well.”
They collaborated with Professor Bill Kahn at Boston University to specifically address the career goals of the company’s legal employees. The five-part program includes one-on-one coaching, virtual leadership trainings, and two in-person sessions. A competitive application process ensures that each cohort consists of no more than fourteen participants.
The more effectively Harrington trains his reports, the more likely they are to be chosen for competitive, company-wide initiatives. In addition to POD, Shire holds multiday development sessions with senior executives and the company’s CEO Flemming Ornskov. The human resources department offers formal trainings, and departments support applicable continuing education programs offered by other institutions. Harrington empowers his lawyers by giving them broad responsibility to perform litigation, contract, patent, and regulatory functions, and holding them accountable for their decisions.
Although some companies might be tempted to reduce professional development offerings to conserve resources, Harrington thinks this is a mistake. Increasing development opportunities not only encourages employees to remain at the company, Harrington says, but also attracts top hires who are driven to work for a company that invests in their careers.
This, in turn, benefits Shire. “We’ve been able to protect our franchises brilliantly, and I think that all of that occurs because we hire really talented people and develop them really well,” Harrington explains.
As the IP department grows, Harrington’s focus is shifting from litigation to development, but he continues to find ways to improve his team’s use of analytics in the courtroom. “It’s not a static process,” Harrington says. “We’re always trying to perfect it.” AHL
Proskauer ’s nationally recognized life sciences patent practice counsels leading biologics, pharmaceutical, biotechnology, and medical device clients, meeting their business objectives by developing and executing market exclusivity and freedom-tooperate strategies. We employ comprehensive strategies that draw from our deep knowledge of and extensive experience with patent litigation, contested patent office proceedings, FDA regulations, patent prosecution, patent transactions, and licenses.
Wolf Greenfield commends Jim Harrington for his leadership and vision. As the largest intellectual property firm in Massachusetts according to the Boston Business Journal , we are proud to have helped Shire with its transactions and intellectual property for more than a decade.


Ron Kloewer and rural Montgomery County Memorial Hospital push boundaries with technological advancements in healthcare
BY DAVID BAEZ

ontgomery County Memorial Hospital (MCMH) serves a region with a population of only 20,000. Fewer than 350 employees, including administrative staff, work at the 25-bed facility. It meets all the conditions required to be officially considered a rural—or critical access— hospital. But its size and remote location haven’t prevented it from riding the vanguard of technology, providing patient service on par with that of much larger hospitals.
“The tech we have access to, combined with our leadership and strategic intent philosophy, puts us at the level of any urban health system,” says MCMH CIO Ron Kloewer.
Kloewer, who began his career in construction civil engineering, left the field when he grew tired of the constant travel that the role required. Born and bred in rural Iowa, he has found a way to stay close to home working for the hospital in Red Oak, Iowa. He started with the organization in 1987 when a contract project manager position opened up.
“I figured it was a good transition job,” he says. “I could get off the road, work there for two or three years, then figure out what’s next.”
But, as the saying goes, life is what happens while you’re busy making other plans. The late 1980s was the era of the PC explosion, and Kloewer, who had zero IT experience, began investigating how this new technology could help the hospital.
Kloewer told the CEO that if he would buy him a PC, some development software, and a few books to learn from, he would manage construction without a staff of secretaries and clerks.
“I told him, ‘I’ll do it all on my own, write programs and everything,’” Kloewer says. ‘“I’m going to dedicate time and effort and save you a bunch of money on labor, because this is where the future is.’”
With a $2.5 million equipment budget to outfit the new hospital, Kloewer also coordinated the move to a new facility.
“It’s incredibly fulfilling to see people get well . . . These are my friends, neighbors, and relatives.”
Quick to learn, he wrote his own databases to organize the transition. Once the project was completed, he left to work in agriculture, but soon enough, the MCMH CEO called him and asked him to come back to lead the development of health information technology.
“My engineering and construction background helped me approach health information technology from an engineering and builders’ perspective,” he says. “That means you have to start with a foundation and build from there.”
Laying that foundation prepared the hospital for all the tech advances that would come to the field beginning in the 1990s. Now, the hospital is as technically advanced as any. A major source of pride for the hospital is its Verizon Heartland Mobile Health Clinic, a clinic on wheels that uses 4G LTE technology to bring medical records anywhere the vehicle goes. The mobile clinic was front and center at the Iowa Hospital Association conference this past October in Des Moines, Iowa.
The hospital also uses tech to create virtual healthcare through biometric home monitoring. MCMH gives iPads and Bluetooth-connected monitoring devices to patients with chronic conditions so the hospital can monitor their data and progress. If they need a hotspot to get online, the hospital, which has a close relationship with local ISPs, sets that up for them. The patients have constant access to their care plan, receive medication reminders, and are able to record weight and blood pressure measurements. If they aren’t tracking these things, the nurse they’ve been assigned will see that on their dashboard and check in with the patient via messaging or live one-on-one video.
“It’s a tech-driven solution to help people engage more in their own healthcare,” Kloewer says. “It’s a high level of patient engagement. The patient is participating and knows someone out there is paying attention.”
The innovations don’t stop there. The hospital recently installed a state-of-the-art, 3-D mammography unit; it’s the only hospital within fifty miles to have one. MCMH is also in the midst of putting in a sixty-four-slice CT scanner. The hospital also has an automated blood bank that does the type and crossmatch for transfusions.
All of these innovations help patients in a variety of ways. Besides the benefit they get from the technologies’ capabilities, that technology also attracts top talent to the hospital. Although a good portion of the medical staff performing primary care joins the organization locally (MCMH is the county’s largest employer), some thirty visiting specialists regularly travel from the Omaha, Nebraska metro area.
“What we try to do is create a medical environment that is modern and accepting, and in some ways advanced beyond what the larger center in the city has, so we can attract these specialists,” Kloewer says.
With all of his experience and accomplishments at the hospital over the past thirty years, Kloewer could surely find interest in his services from a larger, urban hospital. But he says that MCMH has provided him with a set of challenges that are more than sufficient. Combine that with a former farm kid getting to stay in a small-town setting that matches his sensibilities, and there’s been no reason to leave.
“It’s incredibly fulfilling to see people get well when they’re at their most vulnerable,” he says. “These are my friends, neighbors, and relatives. We do darn good work here. It’s an organization I’m proud to be a part of.” AHL
OffSite Archiving and Disaster Recovery (DR): Serious Solutions. Serious Customer Service.
Ready for total control of your data? OffSite specializes in archiving and disaster recovery, offering real-time replication and data reconciliation.
OffSite’s vendor neutral archiving (VNA) services integrate seamlessly with other applications due to an open architecture design and industry enterprise archiving standard. This eliminates concerns about future storage requirements and obsolescence.
OffSite clients have access to vendor neutral archiving and business continuity solutions that protect their organizations’ data and ensure that they have immediate access. Thanks to the nonproprietary storage format, compatible with any DICOM environment, authorized users have multiple and alternative access channels through which they can access medical imaging and other data.
At OffSite, clients can maintain their normal operations with minimal inconvenience due to a cloud-based image management solution that takes all the challenges out of software, hardware, and maintenance, yet offers total control over the data.
OffSite Imaging Management Inc. offsiteimagemgt.com
•
•

•
•
JFK Health System’s Neal Ganguly tackles the communications challenges caused by expansion through mobile connectivity
BY LORI FREDRICKSON
When JFK Medical Center launched an expansion of its emergency department in 2013, it turned a single-unit space into one that comprised four separate units ranging from low to high acuity. Because of that change, it was able to solve the issues that had come with growing volume: driving down the need to divert patients to other medical centers and providing increased comfort for both physicians and patients.
But for clinicians that had previously been used to working side-by-side in a single space, the expansion also brought new challenges, particularly in being able to communicate across the new units. Neal Ganguly, vice president and CIO of JFK Health System, saw this as an opportunity to go mobile.
“We were able to say, ‘Look, we’ve got the technology for this, we can use an app to create an environment where the mobile phone can act as a handset on our phone system,’” he says. Because JFK Health had made significant investments in wireless technology as well as a voice-over IP infrastructure, it seemed like a natural transition to give the ER doctors and nurses dedicated devices with a tool kit of apps to improve communications, including an employee directory, physician on-call lists, and access to broadcast messaging and secure texting.
For a seasoned professional who had taken on similar challenges throughout his long career in the healthcare industry—including fourteen years at CentraState Healthcare, where he’d led the development of an IT strategy to support organizational goals—this was a challenge that he and his team were excited to focus on. “Doing this would create a very seamless communication process,” he says.

“Patient engagement and the world of apps that encourage patient-clinician communications are exploding.”
But the process of building it, he soon learned, was not quite so seamless. The first issue was being able to time the introduction of a new system along with the opening of the new expanded unit, which was set to take place only six months after the idea was approved. This meant that the team had about two months to plan the rollout and identify which tools and underlying structure they would use, followed by two months to build and assemble tools, and two additional months to get them up and running.
First, his team worked to acquire a set of Samsung Galaxy smartphones through the hospital’s cellular service provider, and then customized them for use in a corporate setting by removing nonessential preinstalled apps and limiting those that could be added to the device. Next, they worked to install a new voice-over IP app, directory, and on-call list; from there, they focused on organizing a secure texting environment.
Once the new system was rolled out and implemented, perfecting it took another year. “We were able to develop a pretty strong set of policies and procedures, but we had a lot of technical challenges,” Ganguly says. “Ultimately, we ended up ramping the whole system down to retool it.” Some
of the issues were in usability, particularly with the voiceover IP communication piece. Others were more basic: the extra-strong phone casings also had a tendency to distort microphones, and the network connections for the Wi-Fi system needed to be retuned by engineers to optimize them for a corporate environment.
But as Ganguly’s team was retooling the devices, they were also learning from their customers. One lesson was how invaluable the directories and on-call lists were to hospital employees, who eagerly adopted these from the start. More surprising was just how much hospital members needed direct communication—not just within the ER, but throughout the hospital.
“While initially we were focusing on physician-tophysician communication, we realized that there’s probably a more urgent need for a nurse-to-physician communication,” Ganguly says. He then expanded the devices to nurses within the inpatient units, as well as to other employees who needed to reach doctors on issues ranging from patient quality to regulatory compliance. And though Ganguly initially thought that physicians might feel bombarded by communications,
they have instead been grateful for that connectivity. “They’re feeling like they’re able to close the loop on patient care issues more rapidly,” Ganguly says.
As his team has continued to perfect the mobile system, he’s also seen increased opportunities in it—not just about how it can connect clinicians, but also how other apps might be able to improve patient care. “Mobile is an area we’ve all been looking at because it has such a huge array of applications. Patient engagement and the world of apps that encourage patient-clinician communications are exploding,” Ganguly says. He points to apps that patients are using to monitor their own health, such as FitBit, and notes that information from the growing array of Internet-connected devices can be applied to enable real-time clinical management and intervention.
One application that he’s currently looking to develop would focus on diabetic patients, using technology to monitor physical activity and blood glucose levels and contacting them if they might be at risk. “That way, clinicians can intervene quickly instead of waiting until a month later when that person comes in for their scheduled exam,” Ganguly says.
For him, it’s all part of bringing JFK Medical Center— which has earned Hospitals & Health Networks and HealthForum’s “HealthCare’s Most Wired” award for the past three years—further along into the future. As an active member of the College of Health Information Management Executives, where he also mentors up-and-coming CIOs, Ganguly also hopes that he will inspire others working in his role.
“Although my teams and I don’t directly touch patients, the tools that we provide, support, and maintain are critical to the delivery of healthcare, and I think mobility is going to give us much more data that we can use,” Ganguly says. “How do you begin to mine that data? I think that’s an exciting frontier that I’m excited to see evolve over the next few years.” AHL



Take the pain out of integration, configuration, inter-operation, compliance and detailed charge capture with software designed by ED Providers for ED Providers
Innovation is in our DNA. Browser-based deployment, extensive integration with ancillary and enterprise systems and tools to speed up clinical charting are where we started. PulseCheck has evolved from Ibex, to Picis, and now to its forever-home in Harris, where our future is to empower Patients and Providers to effectively manage Emergency care and follow-ups. Learn more at www.harrispulsecheck.com
With a focus on education and appreciation, SVP of HR Joe Machicote and the Erickson HR team develop a community of lifelong employees at Erickson Living
BY GALEN BEEBE
oe Machicote was a student worker in the dishwashing room at Manhattanville College when his boss called him into his office and asked, “Do you realize how important you are to this organization?” Machicote was confused—after all, he was only a dishwasher. “You don’t realize it, but your job is where everything starts,” his boss said. Since then, Machicote’s career has been driven by the desire to inspire his colleagues. By the time he left college, Machicote was a student manager with Compass Group, the company that provided Manhattanville’s dining services. After two years at Stouffer Hotels, Compass Group asked Machicote to become its director of dining services, where he shared his former boss’s insight with each employee. His efforts didn’t go unnoticed. Soon, the company’s president asked Machicote to transition into human resources as a training manager.
That was twenty-five years ago. Now, Machicote is senior vice president of human resources at Erickson Living, which operates nineteen senior living communities in eleven states. Machicote and the human resources team’s goal is not only to attract and retain strong employees, but to build a community where employees can thrive. “We want to help people truly find a home once they get here,” he says.
Erickson Living fosters a culture of growth through initiatives such as Erickson Living University (ELU). ELU is a blended learning environment that provides both mandatory compliance trainings and supplemental development opportunities. Employees can chose from 750 courses in twenty-nine languages, including leadership, healthcare, and computer courses.
ELU’s framework offers a clear structure for employees, with various courses of study to choose from and achievement markers along the way. Career planning courses help employees envision their future within the company, and

“We’re looking for heroes. Somebody who’s going to come in and make a significant difference in somebody else’s life.”
Erickson Living has also partnered with the University of Maryland, Baltimore County to create the Erickson School of Aging. Students can earn a certificate, bachelor’s, or master’s degree in Management of Aging Services, which will prepare them to begin or further their careers in the senior living industry. “No matter where you are in your career, there’s something for you to be able to seize the opportunity to learn and grow,” Machicote says.
trainings help them gain the necessary skills. For inspiration, Machicote’s team is creating career profiles to highlight individuals who have grown with the company.
Educational opportunities don’t just develop employees— they also attract them. According to Gallup’s 2016 report “How Millennials Want to Work and Live,” 87 percent of millennials say development and career growth opportunities are important in a job. This is a significant increase from the 69 percent of nonmillennials who say the same, but Machicote believes there is more to the story than the numbers show. While nonmillennials might rank other considerations, such as compensation, above development opportunities, growth still matters. “We’re developing growth opportunities with everyone in mind,” Machicote says. “We’re providing it in such a way that you can choose your own order.”
Millennials aren’t the youngest employees at Erickson Living—some waitstaff join as early as high school. “The seniors love it,” Machicote explains. “They build unbelievable connections to the high school students.” High school employees benefit not only from connections with residents, but also from the opportunities Erickson Living provides. The company offers a college scholarship to high school employees who work a certain number of hours, and it is developing ELU programs for high school employees to envision a future in senior living. These students will attend college as Erickson Ambassadors and have a job at Erickson Living waiting for them upon graduation. “ELU is really a great platform that opens a lot of doors to everybody in every single generation,” Machicote says.
Along with a culture of growth, Machicote fosters a culture of appreciation through his philosophy of inspirational human resources. “We’re all doing something for a much, much bigger cause, and that cause is serving others,” he says. In an effort to recognize the most inspirational employees, the human resources and marketing departments collaborated to create the Everyday Heroes campaign. They distilled the company’s philosophy, The Erickson Way, into a onesentence call to action: living our values, one interaction at a time. This saying applies to situations large and small, from washing a dish to building a relationship. “We’re looking for heroes,” Machicote explains. “Somebody who’s going to come in and make a significant difference in somebody else’s life.”
Each of the organization’s nineteen communities already recognized meaningful interactions in their own ways, such as the Mission Moments program, which tells the stories of people—employees or residents—who impact each other’s lives. Everyday Heroes will combine the spirit of these programs and expand the celebration across the organization. “Many employees like the idea of being recognized globally for just doing something that they would do every day without even thinking about it,” Machicote says. “We’re really trying to build a culture of appreciation where people are recognized for living our values, one interaction at a time.”
Machicote’s inspirational human resources philosophy extends all the way from high school waitstaff to senior leadership. He encourages the company’s leaders to consider how their colleagues perceive them and to give each other feedback based on their perceptions. The leaders quickly realized how impactful this feedback could be.
“I do believe in the old adage, ‘Most people will leave their leaders, not the company,’” says Machicote. “Human resources starts with great people. If you’ve got great people, great things are going to happen.” AHL



Joe Machicote SVP of HR Erickson Living
Diversity in the workforce must be accompanied by inclusion in the workplace, the ability for every employee to feel they add value, are treated with dignity and respect, and are part of the natural fabric of the organization. I also envision an organization where diversity and inclusion are not buzzwords, hype, empty celebrations, and fancy titles. Instead, it is real work tied to real objectives, tied to real performance goals, assigned to key leadership, and carried out by all the disciplines of the organization.
Dixie James VP, Strategic Planning and Business Development Einstein Healthcare Network
When I think of a diverse workplace in 2018, I envision a workforce with significant representation across generations, genders, races, cultures, religions, and sexual orientation dispersed throughout every level of the organization, from the mail room to the boardroom.
Jonathan So Senior Director, Health Care Initiatives
Detroit Regional Chamber
Successful companies need to be flexible and constantly shift to meet the needs of customers and the market. A diverse workforce brings in voices that might have gone unheard to business problems. A business should strive for a workforce with varying demographic, socioeconomic, and experiential backgrounds that allows it to leverage new ideas and provide creative and collaborative solutions to problems. Additionally, diverse workforces naturally create environments where ideas are challenged, tested, and allow for more innovative thinking.
Georgette Kores Manager, Global Wellness & Engagement World Fuel Services
The first image that comes to mind of a diverse workforce is the world with a view from space, because a diverse workplace means more than just diversity of gender, race, or age; it also includes a diversity of skill sets, problemsolving abilities, and ideas. The next image that comes to mind is a group of different people, similar to what you would see on a college brochure. This is the image that I think comes to mind for most people because they see diversity as just the superficial differences. That reminds me that there is continued work that needs to be done in the workplace to educate and inspire others to see deeper than what is obvious to the eyes at first glance.
78%
The percentage of healthcare professionals who are women, according to the Bureau of Labor Statistics. However, women are drastically underrepresented as a percentage of healthcare executives. (Avella, p. 68)
15K+
The area in square miles served by Community Medical Centers, the largest hospital system in the Fresno-Clovis, California, area. (Community Medical Centers, p. 203)
300K+
The number of files in DARI’s human motion database, making it the largest database of its kind in the world. (DARI, p. 144)
1854
The year in which the company now known as Dignity Health System was established, when The Sisters of Mercy opened St. Mary’s Hospital, the oldest continuously operating hospital in San Francisco. (Dignity Health, p. 193)











